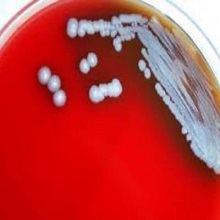
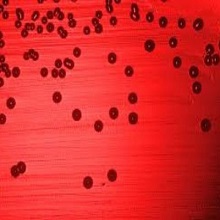

Актуелно
 |
Са поносом можемо да вас обавестимо да ће у наредном периоду сајт ОБ Панчево, бити замењен новим, који ће бити много прегледнији са много више занимљивости. Наравно, и даље ћемо бити ту за све оне који имају примедбе, питања, сугестије али надамо се и похвале. |
| Цироза јетре је хронична болест код које оштећење ћелија јетре изазива инфламацију, некрозу и активацију звездастих ћелија што доводи до инсуфицијенције јетре и / или малигног тумора. |
| Током викенда умерен број пацијената у ОРЛ амбуланти у Општој болници Панчево. Најчешће су долазили због компликација горњих респираторних инфекција, деца због гутања страних тела али још увек има и падова и повређивања са бицикла. |
 |
У оквиру редовне превентивне акције Министарства здравља Републике Србије, и ове недеље смо у специјалистичком центру Опште болнице Панчево организовали акцију превентивних прегледа која је омогићила нашим грађанима да провере своје здравље и тиме значајно утичу на превенцију даљем развоју болести, такође пацијенти који су желели могли су се вакцинисати против сезонског грипа. |
 |
И ове недеље организујемо акцију превентивних прегледа. Позивамо грађане да дођу у специјалистички центар Опште болнице Панчево, у недељу, 6. октобра од 8 до 17 часова и провере своје здравствено стање. Прегледе могу обавити сви грађани Панчева и околине, без здравствене књижице. Акције које спроводи Министарство здравља за циљ имају рану дијагностику и промоцију превенције као најефикаснијег начина бриге о здрављу. |
| Деменција се дефинише као стечени и перзистентни поремећај интелектуалних функција са дефицитом у најмање три од следећих интелектуалних функција: 1. памћење, 2. језик, 3. виднопросторне способности, 4.личност и понашање, 5.друге когнитивне способности (апстрактно мишљење, рачунање, планирање). Кључно је да когнитивне промене морају бити стечене и довољно изражене да ремете социјални и професионални живот болесника. |
| Хемороиди или фиброваскуларни јастучићи аналног канала су део нормалне анатомске структуре и сматра се да су веома битни за одржавање континенције. Постоје два типа хемороида у односу на локализацију: спољашњи (у доњем делу аналног канала, испод зупчасте линије) и унутрашњи (у горњем делу аналног канала, изнад зупчасте линије). |
 |
Зашто долази до хипертензивне кризе и чак инфаркта? Колики је битно контролисати и лечити нивое високог холестерола? Tолико болесни aли смо некад мало и немарни кад је наше здравље у питању? |
 |
Ултразвучни преглед јетре је неинвазивна, брза, једноставна , дoступна и поуздана дијагностичка процедура која се користи за процену величине, структуре и стања јетре и представља први корак у дијагностици обољења јетре. |
 |
Синдром изгарања на послу је тема о којој се у последњих пар година јако пуно говори, што због развоја људских ресурса као посебне гране, то због све комплекснијих послова који укључују мултидисциплинарни приступ, познавање модерних технологија, а услед брзине садашњице, често се заборави на опште људске потребе што још више доприноси испољавању симптома изгарања. |
 |
По налогу Министарства здравља Републике Србије, дана 21. и 22. септембра 2024. године ( субота и недеља), у нашој здравственој установи ће се спровести ЦТ снимање. |
 |
У организацији Министарства здравља Републике Србије, у недељу, 22. септембра 2024. године, у периоду од 08.00 до 17.00 часова, одржаће се превентивни прегледи |
 |
И овог викенда, у оквиру акције Министарства здравља, у Панчеву су одржани бесплатни превентивни прегледи. Сви грађани, укључујући и оне без здравственог осигурања, имали су прилику да провере своје здравствено стање. |
 |
Пијелонефртитис представља запаљење ткива бубрега које траје (бубрежне карлице, чашица и каналића). По дужини трајања дели се на акутни и хронични. |
 |
Дубока венска тромбоза ( phlebothrombosis ) настаје због призидног стварања тромба који својим растом може у потпуности да опструише венски лумен. Последично се развија дистална венска тромбоза. |
 |
У првој недељи дубоке венске тромбозе тромб није чврсто фиксиран за зид и растреситог је састава. Део тромба се може откинути и пропагирати до пулмоналне артерије, ту се зауставља изазивајући емболију плућа (embolia pulmonum). |
 |
Вилсонова болест је генетски аутозомно рецесивни поремећај у коме се бакар ексцесивно накупља у јетри и мозгу. |
 |
У нашој болници листе чекања су много краће него у појединим здравственим центрима где се чека и преко годину дана. У Oпштој болници Панчево на операцију кука чека се око 8 месеци, док пацијенти који оперишу катаракту на ову хирушку интервенцију чекају најдуже два месеца. |
 |
у недељу 15. септембра 2024. године, у периоду од 08:00 до 17 часова, одржаће се превентивни прегледи у здравственим установама целе земље, као и у Општој болници Панчево. |
| Општа болница Панчево се захваљује ЗТР Фооди и Премиер таксију Панчево на вредној донацији 3 клима уређаја. |
| У зависности од силе која је изазвала трауму, повреде бубрега делимо на оне изазване тупом силом (пад са висине, повреде задобијене у саобраћајном удесу и сл.) и повреде настале дејством оштрих предмета (нож, сечива). Ове повреде могу бити изоловане, или удружене са повредама других органа. Велику групу чине јатрогене повреде настале у току извођења перкутане биопсије бубрега, пласирања нефростоме или литотрипсијe. |
| Хипертензија у трудноћи се дефинише као повећање систолног притиска на 140mmHg и више или повећање дијастолног притиска на 90mmHg и више, измерено у два мерења, у врменском интервалу не мањем од 4 сата. |
Акција превентивних здравствених прегледа у Панчеву

 |
Још једна у низу акција превентивних прегледа у организацији Министарства Здравља Републике Србије одржаће се у Општој болници Панчево, 8. септембра 2024. године од 08 до 17 часова. |
| Бенигна хиперплазија простате (БХП) представља немалигно увећање простате, које се често јавља код мушкараца старијих од 50 година. Ово стање се сматра физиолошким и обично није проблематично све док не доведе до симптома који утичу на квалитет живота пацијента. |
| Већина болесника који имају срчану слабост пре или касније развије и бубрежну слабост, исто важи и за обрнуту варијанту. То значи да болест једног од та два органа временом доводи до погоршања функције другог органа и тако настаје кардио - ренални или рено - кардијални синдром. Зато је врло важно да приступ болесницима буде мултидисциплинарни, да се у лечењу таквих пацијената ангажује како кардиолог, тако и нефролог. |
| Спинална анестезија је техника регионалне анестезије. Заједно са епидуралном анестезијом спада у групу централне спроводне анестезије. Често се користи код операција доњих екстремитета, карлице, доњег абдомена или током порођаја. У овој процедури, локални анестетик се убризгава у цереброспиналну течност – ликвор, на нивоу лумбалних пршљенова (између L2 и L5). Када се раствор локалног анестетика апликује у цереброспиналну течност, он доводи до привременог прекида нервне трансмисије коју постиже захваљујући реверзибилној блокади натријумових канала у нервним влакнима. |
| Опсесивно-компулзивни поремећај (ОКП) је ментални поремећај у којем људи доживљавају нежељене и поновљене мисли, осећања, слике или сензације (опсесије) и учествују у понашању или менталним радњама (компулзије) као одговор. Често особа са ОКП спроводи компулзије да привремено елиминише или смањи утицај опсесија, а њихово неспровођење изазива узнемиреност. ОКП варира по тежини, али ако се не лечи, може ограничити нечију способност да функционише на послу, у школи или код куће. |
| Једна од веома честих болести колена у општој популацији је остеоартритис. То је хронична болест дегенеративне природе тј. последица је измена у ткивима која сачињавају зглоб, а које настају процесом старења организма. Остеоартритис није специфичан за одређене зглобове, већ може захватити било који. Када је зглоб колена захваћен, то се назива гонартроза. |
| Жучни канали су склони зачепљењима и упалама, а то су, поред појаве камења, и неки од највећих проблема у раду жучне кесе. |
| Тумор маркери су супстанце које производе туморске ћелије, али их могу стварати и здраве, нормалне ћелије. Производи их или сам карцином или организам пацијента као одговор на присисутво карцинома, али могу бити последица и неког бенигног поремећаја. Налазе се унутар ћелија, а такође циркулишу у крви. Управо чињеница да се њихова концентрација може одређивати из узорка крви, омогућила је њихову широку употребу. |
| Мучнина је непријатни субјективни осећај који претходи повраћању. Повраћање је неуромишићни рефлекс који се завршава експулзијом желудачног садржаја на уста. Мучнина је субјективна, за разлику од повраћања које представља објективни феномен. |
 |
Планоцелуларни карцином и аденокарцином једњака изразито су малигни тумори који у раном стадијуму када су још потенцијално курабилни, имају асимптоматски ток. Симптоми се јављјају тек у узнапредовалом стадијуму болести, са врло лошим исходом упркос оперативном лечењу и хемиотерапији. |
 |
Анеуризма аорте је локализовано, трајно проширење крвног суда од најмање 50% ширег пречника, у односу на крвни суд здраве особе истог пола и старости, а која садржи сва три слоја зида. |
 |
У Општу болницу Панчево ускоро стижу нови апарати, у вредности од 6о милиона динара, захваљући новцу који је обезбедио Покрајински секретаријат за здравство. Централни мониторинг за Службу неурологије, холтер систем за Службу кардиологије, ултразвучни апарат за Службу радиологије као и нови софтер за чување података. УПС систем за скенер који ће чувати скенер од прекида дотока струје. Набавићемо нову централну остеодензитрометрију за дијагностиковање остеопорозе. Ови и многи други апарати помоћиће у лакшем дијагностиковању болести и квалитетнијем лечењу. |
 |
Дијабетес тип 2 је болест која се може спречити, што је значајна информација за особе са предиспозицијом за развој овог обољења, а то су првенствено људи који се боре са гојазношћу, имају мањак физичке активности, као и лоше навике у ихрани. |
 |
Диабетес меллитус је веома чест метаболички поремећај, у коме продужена хипергликемија настаје као последица недостатка и/или умањене ефикасности ендогеног инсулина. Диабетес може да буде инсулин зависни ( ИДДМ) и инсулин независни ( НИДДМ), односно тип 1 и тип 2. |
 |
Концепт роботске хирургије и генерално минимално инвазивне хирургије, резултат је савремених технолошких достигнућа и хируршких иновација. Нове технологије имају за циљ оптимизацију хируршких терапијских резултата. |
| Терминална бубрежна слабост представља крајњи стадијум акутних као и хроничних бубрежних болести.Терминална бубрежна слабост је стадијум бубрежне болести где је, ради спасавања пацијентовог живота, неопходна примена неких од метода замене бурежне функције, нека од врста дијализе или трансплантација бубрега. |
| Инфекција коже, захвата површни слој коже. У око 90% случајева обољења изазивач инфекције је СТАФИЛОКОК. Локални налаз се исполљава у виду црвенила након чега долази до стварања пустула и була које се пуне гнојним садржајем. |
| Интракранијална крварења обухватају различите типове крварења од којих су нека најчешћи узрок морбидитета и морталитета, пре свега превремено рођене деце, а нека се ретко срећу у новорођеначком периоду. |
 |
Током лета се дешава да због незгодног скока у воду дође до пуцања бубне опне. Начелник Одељења за ухо, грло, нос доктор Вељко Божић наглашава да се треба јавити лекару и да је погрешно лечити се на своју руку, јер то може довести до оштећења слуха и операције која би могла да се избегне уколико се дође код лекара одмах после повређивања. |
 |
У просторијама Црвеног крста Панчево организована је редовна акција добровољног давања крви на којој је прикупљено око 40 јединица. Залихе крви су и даље на минимуму и у септембру ће бити организоване и две ванредне акције. |
 |
Пролактиноми представљају туморе ћелија предњег режња хипофизе. По природи најчешћњ су то аденоми (врста бенигних тумора), као и већина осталих тумора хипофизе. Они производе и излучују хормон пролактин, који нам тако предтавља врло користан тумор маркер, како у постављању дијагнозе, тако и у праћењу успешности лечења. |
| Акутни холециститис је акутно запаљење зида жучне кесице праћено болом у трбуху под десним ребарним луком. Чести симптоми су још и повишена телесна температура, мучнина и повраћање. У око 90% случајева удружено је са билијарном калкулозом (камен у жучној кесици). Акутни холециститис се најчешће јавља као акутна егзацербација хроничног холециститиса. |
| Кожа је наш највећи орган и представља заштитни омотач за наш организам. Као таква је често изложена различитим спољашњим факторима како зими тако и лети. Посебно је важно да о њој бринемо током летњих месеци када је највише изложена штетном ултравиолентном зрачењу од сунца. |
 |
Давне 1978. године урађена је прва ин витро фертилизација (ИВФ). Лујза Браун је прва беба рођена поступком вантелесне оплодње. Од тада па до данас очигледан је напредак и стално усавршавање асистиране репродуктивне технологије (АРТ). |
| Ограничена (oSSc) системска склероза углавном почиње Raynaud феноменом који траје више година. Затим се јавља дифузни оток прстију и шака који се завршава склеродактилијиом. У ограниченом облику склеродермија је углавном ограничена на прсте, шаке, лице и врат. Захваћеност унутрашњих органа је такође мала и углавном не долази до инсуфицијенције па скраћење животног века није значајно. |
| Системска склероза је системско обољење хроничног карактера код кога долази до оштећења малих крвних судова коже и унутрашњих органа. Активација имуног система који учествује у оштећењу крвних судова, истовремено подстиче појачано стварање влакана везивног ткива. |
| Гастритис спада у групу најчешћих обољења гастроинтестиналног система, а представља упални процес слузокоже желуца. Слузокожа облаже желудац и има важну улогу у процесу варења и стварању желудачне киселине, помоћу које се храна у желуцу разграђује. Осим хране, желудачна киселина има и заштитну улогу, јер штити организам од различитих патогених микроорганизама које унесемо у себе. |
 |
Међународни дан младих обележава се сваке године 12. августа, скрећући пажњу младих на питања младих и славећи потенцијал младих као партнера у данашњем гловалном друштву. Године 1965. у резолуцији 2037 Генерална скупштина усвојила је Декларацију о промовисању међу младима идеале мира, узајамног поштовања и разумевања међу народима. |
 |
Од свих врста отровних змија код нас су значајне поскок и шарка. Уједи се најчешће догађају током топлих месеци у пролеће и лето. Уједи отровница углавном се дешавају у сеоском становништву при обављању пољопривредних радова. |
| Број операција у Општој болници Панчево није редукован, без обзира на годишње одморе. У Специјалистичком центру ради се уобичајено, није смањиван ни капацитет операција јер су све сале климатизоване, истакла је ПР Опште болницеПанчево, докторка Слађана Ковачевић. |
| Вирус Западног Нила је, поред вируса јапанског енцефалитиса, најраширенији узрочних тешких инфекција централног нервног система (у даљем тексту ЦНС). |
| Дојење је један од најефикаснијих начина да се осигура здравље и опстанак детета. Међутим, супротно препорукама СЗО, мање од половине беба млађих од 6 месеци се искључиво доји. |
 |
Тромбоемболија плућа настаје опструкцијом гране плућне артерије крвним угрушком. Презентује се у виду отежаног или убрзаног дисања, убрзаног срчаног рада, несвестице и бола у грудима. |
 |
Светски дан хепатитиса одржава се сваке године 28.јулa. Тренутно у свету са хепатитисом живи 290 милиона људи. Aктуелни слоган „Пронађимо милионе неоткривних“ указује на један од највећих проблема везаних за хепaтитис-поред познатих бројки оболелих, постоје милиони људи у свету који су заражени, а да немају знакове инфекције. Чешће обољевају жене. |
 |
Хипотиреоидизам је стање недовољне производње и дејства тиреоидних хормона. Чешће обољевају жене. |
 |
Делиријум је акутно настало стање конфузности са флуктуирајућим током, коме су посебно склоне старије особе са когнитивним оштећењем, а у коме доминира поремећај пажње. |
 |
Током живота најмање 90% људи доживи неку врсту главобоље. Свака трећа особа у неком делу живота доживи јаку главобољу. Мигренске главобоље су изненађујуће честе и њихова преваленција износи 15% до 18% код жена и 5% до 6% код мушкараца. Најкраће, сваки десети становник планете пати од понављаних напада мигрене. |
 |
У последњих неколико година код млађих мушкараца ТУ тестиса је у порасту. Не зна се тачан узрок и настанак тумора, али у 10% случајева је уочен, неспуштен тестис као узрок, док је код 20-30% упчен смањен број сперматозоида. |
 |
Представља један од најчешћих разлога болне осетљивости рамена. У немедицинским круговима често се описује као „укљештење“ мишића у раменом појасу или „сударање мишића и кости“ у пределу рамена. |
 |
Докторка Гавриловић је лекар у Општој болници Панчево, а колико се у овој установи бол озбиљно схвата сведочи чињеница да од августа 2020. године ради амбуланта за терапију бола у којој се третирају све врсте дијагностикованих акутних и хроничних болова. |
 |
Без заказивања и здравствене књижице и ове недеље грађани Панчева могли су да преконтролишу своје здравље. Превентивни прегледи битни јер се у већини случајева болест открије на време и може да се излечи и контролише на адекватан начин. |
 |
Акцијом бесплатних превентивних прегледа, које спроводи Министарство здравља, 14. јула 2024.године у периоду од 8.00 до 17.00 часова у специјалистичком центру Опште болнице Панчево организујемо превентивне прегледе. Сви наши грађани, и они без здравственог осигурања, биће у прилици да без заказивања и упута, брзо и ефикасно провере своје здравствено стање |
 |
Свeтски дан станoвништва oбeлeжава сe 11. jула и тo je дан устанoвљeн oд странe Уjeдињeних нациjа, 1987. гoдинe, када je забeлeжeнo да на планeти Зeмљи живи пeт милиjарди људи и има за циљ да подигне свест о питањима везаним за глобалну популaцију. |
 |
Едем мозга представља повећање укупне запремине мозга услед накупљања воде у интра- или екстрацелуларном простору можданог ткива. Идентификоване су три врсте можданог едема – цитотоксични, вазогени и интерстицијални, мада је у клиничким условима њихово разликовање ретко могуће због њиховог преклапања у истој патолошкој ситуацији. |
 |
Алцхајмерова болест (АБ) дефинисана је као клиничко-патолошки ентитет који најчешће има амнестичку презентацију (почиње поремећајима памћења, а праћен је развојем прогресивне деменције у следећих неколико година). |
 |
Сунчева светлост има бројне улоге у нашем организму. Одговорна је за циркадијални ритам, за синтезу витамина Д који се показао нопходним за скоро све физиолошке процесе у нашем организму. |
 |
Акутне леукемије (АЛ) су малигне болести хематопоезног система које настају клонском пролиферацијом ћелија хематопоезе. Постоје две велике групе АЛ: акутне мијелоидне (АМЛ) и акутне лимфобластне леукемије (АЛЛ). |
 |
Тренутно, више од 55 милиона људи широм света има деменцију, од којих преко 60% живи у земљама са ниским и средњим приходима. Сваке године има скоро 10 милиона нових случајева. |
 |
Муцање представља поремећај говора, јавља се код особа свих узраста, а значајно утиче на флуентност и временску форму говора. Муцање је повезано са разликама у анатомији мозга, функционисању и регулацији допамина за које се сматра да су последица генетских узрока. |
 |
Изненадна срчана смрт (ИСС) дефинише се као природна смрт чији је узрок срчано обољење, а која се манифестује губитком свести насталим унутар једног сата од почетка акутних промена у функцији кардиоваскуларног система. |
 |
Бројне научне теорије, као и експерименталне и клиничке студије покушавају да објасне настанак и развој атеросклерозе, чије најчешће последице, а то су коронарна болест и церебрални инфаркт, представљају водеће узроке морталитета широм света. |
 |
Од 29. до 31. маја ове године је у Прагу одржан 46. Конгрес Европског удружења херниолога. Ово струковно удружење окупља хирурге из целе Европе који се баве лечењем кила предњег трбушног зида. |
| Ендометриоза представља присуство ендометријалног ткива ван материце.У питању је релативно често стање које је бенигно по својој природи,али у великој мери нарушава квалитет живота жене. |
| Климатске промене утичу на квалитет ваздуха повећањем хемијског (пораст концентрације сумпорног и азотног оксида, озона, финих честица, прашине) и биолошког загађења (повећано стварање и повећана алергогеност полена и плесни). Сумпордиоксид и азот диоксид настају сагоревањем фосилних горива, а њихово испуштање у атмосферу доводи до киселих киша и погоршања квалитета ваздуха. |
| Клима представља интегрисани сатистички показатељ температуре, влажности ваздуха, атмосферског притиска, ветрова, падавина и других метеоролошких елемената, у одређеном региону, за одређени временски период (просечно за 30 година). |
| У физиолошким стањима процес изградње и разгрaдање костију је у равнотежи, а остеопороза настаје уколико се та равнотежа наруши (ако се убрза разградња, а смањи изградња костију). |
 |
Уринарну инфекцију пре свега потврђују њени симптоми који су веома непријатни. Јављање тегоба уколко не пролази захтева посету лекару. Уринарне инфекције су чешће лети и код жена, за то је често може бити одговоран мокар купаћи или клима уређаји |
 |
Апендицитис је упала слепог црева (апендикса). Слепо црево је узани део црева у облику црвуљка, дужине неколико центиметара. Једним крајем слепо црево везано је за почетни део дебелог црева, а други крај му се слепо завршава |
 |
Перитонитис представља запаљење перитонеума. Перитонеум или трбушна марамица је танак слој ткива који у виду омотача покрива унутрашњост абдомена и већину унутрашњих органа. Упала најчешће настаје као последица гљивичне или бактеријске инфекције. |
 |
У клиничкој слици перитонитиса доминира јак абдоминални бол који се појачава при покретању и кашљању па болесник мирно лежи. Услед надражаја дијафрагме јавља се бол у рамену. Често се јављају и повраћање, подригивање и штуцање. |
 |
Фебрилна неутропенија (ФН) дефинише се као фебрилност пораст оралне температуре изнад 38,5 ºC, или два узастопна пораста изнад 38,0ºC у размаку од 2 часа код болесника са неутропенијом (апсолутни број неутрофила мањи од 0,5x10 9 , или мањи од 1 x 10 9 ако се предвиђа смањење на ≤ 0,5x 10 9 током следећих 48 часа) после антиенопластичне терапије (хемиотерапије и/или радиотерапије). Фебрилна неутропенија увек означава инфекцију неутропеничног болесника иако знаци и симптоми инфекције могу бити благи или чак одсутни услед компромитованог имунолошког одговора. Она је ургентно стање у онкологији. |
| Акутни глауком спада у групу најургентнијих стања у офталмологији, тако да захтева брзу дијагнозу и терапију. |
| Злоупотреба дрога је озбиљан светски проблем, који захтева континуирану, мултисекторску сарадњу институција, са мерама и активностима усмереним ка појединцу и заједници. |
| Атријална фибрилација (апсолутна аритмија) најчешћа је дуготрајна преткоморска аритмија. |
| Анемија преставља стање које се карактерише снижењем броја еритроцита и / или снижењем концентрације хемоглобина у крви (мушкарци мањи од 130г/л, а жене мање од 120г/л). |
| Инфекције мокраћних путева (ИМП) су један од водећих разлога за прописивање антибиотика у свету. Најчешће су у доби од 18 до 39 година, када је сексуална активност највећа. Посебно су честе код младих жена и чак 27% њих 6 месеци након прве епизоде ИМП има потврђен први, а 2,7% потврђен и други рецидив. |
| У периоду раног пролећа па све до касне јесни , мора се пазити од уједа крпеља. У већини случајева ујед крпеља је безопасан, али у неким ситуацијама може доћо до озбиљног обољења – ЛАЈМСКА БОЛЕСТ. |
| Еректилна дисфункција представља болест данашњице, о којој се још увек мало прича, а са медицинске стране много зна. Јавност још увек не даје много пажње овој болести/стању. Према дефиницији уролошке Европске асосијације, то је стање где долази до трајне немогућности постизања ерекције, да би задовољила сексуалну функцију. Дели се на минималну, умерену и комплетну. |
| У склопу акције превентивних прегледа које је организовало Министарство здравља и ове недеље прикључили су се Општа болница Панчево и Дом здравља. Наши најмлађи суграђани такође ове недеље могли су да се јаве педијатру, јер су прегледи били организовани и за њих. |
 |
Циљ обележавања овог датума био је тај да се ода почаст и признање свим добровољним даваоцима крви, плазме или тромбоцита који овим хуманим и несебичним чином помажу да се спасу милиони живота широм света. На овај датум истиче се димензија дељења и повезаности давалаца крви и пацијената. |
 |
Овом приликом, 16. јуна 2024.године у периоду од 8.00 до 17.00 часова, и у специјалистичком центру Опште болнице Панчево биће организовани превентивни прегледи за све грађане. И они без здравственог осигурања биће у прилици да без заказивања и упута, брзо и ефикасно спроведу |
 |
Мајмунске богиње су зоонозе. То је дволанчани ДНК вирус који припада роду „Orthopoxvirus" (овом роду припада још и Вариола вирус, „Vaccinia" вирус и Кравље богиње). |
| У панчевачкој болници примењена савремена РНК терапија намењена пацијентима код којих због лоше генетике нису деловали лекови за снижавање холестерола, што је довело до инфаркта и других болести срца и крвних судова. |
| Акутни мождани удар (инфаркт мозга, инсулт, шлог, мождана кап) је болест која настаје услед запушења крвног суда (акутни исхемијски мождани удар- 75-80% болесника) или прскања крвног суда и изливања крви у мозак или око мозга (акутни хеморагијски мождани удар - 20-25% болесника). |
 |
Зрачна терапија се користи као један од начина лечења пацијената оболелих од малигних тумора. Радиотерапија, односно зрачна терапија је техника у којој се користе X-зраци и честице великих енергија, које делују антитуморски. |
 |
Светски дан човекове средине (или околине) је дан који се обележава у целом свету сваког 5. јуна кроз разне активности и кампање, са циљем да се скрене пажња јавности на бројне еколошке проблеме и потребу очувања животне средине. |
 |
ИЦД је скраћеница за имплантабилни кардиовертер-дефибрилатор. Реч је о веома малој металној справи која се уграђује под кожу на грудима, а чије електроде се протежу до срца. ИЦД можда није ни видљив испод коже, али се може осетити. ИЦД може да осети откуцаје срца, може да препозна појаву малигне аритмије, а ако је открије, у стању је да одмах пошаље струјни удар у срце, који ће, у идеалном случају, „поново покренути“ срце и „бацити“ назад нормалан ритам. |
 |
Крварење је излазак крви из повређеног или оболелог крвног суда. Хемостаза представља прекид крварења, заустављање истицања крви. Крварење се може зауставити привремено или дефинитивно. |
| Туретов синдром је скум симптома који узрокују да људи праве изненадне покрете или звукове, назване тикови, које не могу да контролишу. На пример, неко са Тоуреттеовим синдромом може током неколико миута континуирано трептати или гутати ваздух изнова и изнова. Неки људи могу изговорити речи које не намеравају да изговоре. |
| Традиционално, 31. маја, обележава се Светски дан борбе против пушења, односно, конзумирања дувана. Кампања коју спроводи Светска здравствена организација има за циљ да подигне свест код људи, односно, упозори на здравствене и социјалне ризике који су у корелацији са конзумирањем дувана. Такође, циљ овакве кампање јесте и да поспеши усвајање адекватних мера, засноване на доказима, којима ће се укупна потрошња дувана и изложеност дувану смањити на минимум. |
 |
Сунчаница је акутно оштећење мозга изазвано сунчевим зрачењем. За време високих температура, често чујемо да нам је неопходна заштита од сунца, а препорука је да не излазимо по сунцу од 12-17 часова - али зашто? Какве последице може да остави дуго излагање сунцу? |
 |
Повреде високом температуром се најчешће догађају случајно, на радном месту, у саобраћајним и рударским несрећама, пожарима, али нису ретке ни у домаћинству. Опекотине настају деловањем врелих течности, пара пламена, топлотног зрачења, електричне струје, хемикалија и радиоактивног зрачења. Оштећења могу да захвате различите слојеве ткива. |
 |
Иако се често о томе не размишља, правилно чување лекова је важан услов за гаранцију њихове ефикасности. Да ли сте сигурни да чувате своје лекове у најбољим условима? Покушајте да одговорите на следећа питања и проверите да ли се придржавате основних правила. |
 |
Сезона годишњих одмора је на прагу. Одлазак на море, планину или у природу поред својих лепих има и непријатне стране. Најчешће непријатности су везане за кожу. |
 |
„После педесете, једном годишње мушкарци треба да ураде тумор маркер простате и ултразвук како бисмо били сигурни. Уколико се догоди да смо тумор открили на време, тада је и лечење извесно" говорила је за РТВ Панчево докторка специјалиста урологије Слађана Ковачевић, начелница Одељења урологије и ПР Опште болнице Панчево |
| После изузетног одзива током претходне акције када је у Србији прегледано око 23.000 грађана, Министарство здравља организовало је поново превентивне прегледе са циљем да се у раној фази болест дијагностикује, а тиме и да степен излечења буде већи. Грађани су у панчевачкој Општој болници и Дому здравља, као и у осталим здравственим установама широм Србије могли без упута, заказивања и здравственог осигурања да обаве основне лабораторијске анализе, измере крвни притисак, провере хормоне штитне жлезде и ураде тумор маркере простате. |
| Хипотермија представља стање у коме организам губи топлоту брже него што је продукује. Настаје на температури нижој од 35° Ц, као резултат продужене експозиције екстремно ниским температурама. Најчешћи узроци хипотермије су експозиција хладним временским условима или хладна вода.Сматра се постепено насталим стањем све док температура тела не достигне вредности ниже од 30 ° Ц. |
| Хипертермија је стање повишене унутрашње температуре. Предиспонирајући фактори за настанак неких од клиничких облика прегрејаности јесу висока амбијентална температура која смањује способност тела да губи топлоту радијацијом; висока релативна влажност, која смањује способност тела да губи топлоту испаравањем зноја; вежбе и напорна активност,старије особе, због узимања лекова, некретања, смањена могућност одржавања нормалне температуре, смањене могућности адаптације на промене температуре, смањеног осећаја жеђи; болести срца, дехидратација, гојазност, грозница, замор, дијабетес мелитус, хипертиреоза, Паркинсонова болест, узимање одређених лекова амфетамини и кокаин, који повећавају мишићну активност и алкохола који смањује способност тела да регулише топлоту. |
 |
Услед великог интересовања грађана, Министарство здравља у недељу, 26.маја, наставља акцију бесплатних превентивних прегледа, коју спроводи у циљу ране дијагностике и промоције превенције. |
 |
Светски дан хипертензије обележава се у мају, а такође ове године мај је проглашен за месец мерења крвног притиска са циљем да се апелује на грађане да мере крвни притисак, јер се на једноставан начин поставља дијагноза и уколко је потребно даје терапија. |
 |
Планета Земља је, због смеше гасова који чине њену атмосферу, разноврсних климатских услова, минералних богатства у саставу њених површних слојева, поседовања бројних водених површина, али и других значајних карактеристика, дом многих биљних и животињских врста. |
 |
Тортиколис је накренутост главе на једну страну. Може бити урођени и стечени. Урођени се јавља због скраћења једног од вратних мишића ( „m. sternocleidomastoideus") најчешће као последица положаја бебе у стомаку мајке током трудноће. |
 |
Грађани нису крили задовољсто што су на једноставан начин могли да провере своје здравље. Министарство здравља наставило акцију превентивних прегледа са циљем да се у раној фази болест дијагностикује. Грађани како у целој Србији тако у Општој болници Панчево су могли без упута, заказивања и здравственог осигурања уз преглед наших лекара измере крвни притисак, вредност шећера у крви, ураде ЕКГ и ултразвучни преглед абдомена. |
 |
Акција бесплатних превентивних прегледа, које спроводи Министарство здравља у циљу ране дијагностике и промоције превенције као најефикаснијег начина бриге о здрављу, биће настављена у недељу, 19. маја од 8 до 17 часова, у специјалистичком центру Опште болнице Панчево. |
| Породица би требало да представља стабилну социјалну заједницу у оквиру које, међу њеним члановима, влада поштовање, међусобно уважавање, подела одговорности, поверење и љубав. |
| Синусна брадикардија је синусни ритам са срчаном фреквенцом 60/мин. Синусна брадикардија може да се јави у физиолошким и патолошким стањима. |
| Сваког 15. маја се обележава се Међународни дан породице. Ово је важан дан који се сваке године обележава широм света, а има за циљ да се подигне свест о значају породице у нашим животима и у општем друштвеном контексту. |
| Артеријска хипертензија је хронично повишење артеријског крвног притиска изнад 140/90 ммХг код особа старијих од 18. година, мерено у амбулантним условима. Под дијагнозом артеријске хипертензије се подразумевају и нормалне вредности крвног притиска код болесника на редовној антихипертензивној терапији. |
| Међународни дан медицинских сестара обележава се 12.маја сваке године, сем што га прослављамо, подсећамо се и колико је улога медицинске сестре важна у правилном и квалитетном спровођењу здравствене неге и заштите у здравственој установи у којој радимо, посебно на одсеку на којем смо. Сложеност овог позива је препознала Флоренс Најтингејл, британска медицинска сестра, зачетница модерног сестринства, те је и 12.мај, датум њеног рођења, проглашен Међународним даном сестринства. |
| Национални дан добровољних давалаца крви се традиционално обележава сваког 11. маја, док се у свету он обележава сваког 14. јуна, још од 2005. године, када је Светска здравствена скупштина уврстила овај датум у свој Календар здравља. |
 |
Поводом Међународног дана сестринства у Народној башти организован је Базар здравља. Медицинске сестре и лекари организовали су акцију превентивних прегледа и омогућили суграђанима да провере своје здравствено стање, шетајући кроз Народну башту. На Базару здравља сви заинтересовани грађани су имали прилику да измере крвни притисак, шећер у крви, висину, тежину, одреде индекс телесне масе, утврде факторе ризика и добију здравствене савете. |
 |
Као и сваке године до сада, настављамо традицију обележавања Међународног дана сестринства. Oкупили смо се у најлепшем градском парку Народној башти како бисмо промовисали нашу професију и истакли значај наше струке у здравственом систему. |
| Процењује се да је око 60 до 85% људи широм света недовољно активно или потпуно физички неактивно. Неактиван начин живота доприноси укупној стопи морталитета и морбидитета. Овакав начин живота два пута повећава ризик од кардиоваскуларних болести, дијабетеса и гојазности. |
 |
Астма је хронична опструктивна запаљенска болест дисајних путева која узрокује проблеме при дисању. Карактеришу је јак имунолошки одговор и хронична упала трахеобронхијалног стабла. |
 |
Ринитис је запаљење носне слузокоже, које се испољава цурењем носа, кијањем или сврабом у носу. Дели се на алергијски, инфективни и друге. |
 |
Алергијска реакција представља претерану, несврсисходну и неспецифичну реакцију организма на неки стимулус или супстанцу, која иначе не би требало да буде штетна по организам. |
 |
Алергијска обољења спадају у најчешће болести савременог доба. Бројна истраживања показала су да око 25% укупне светске популације болује од неке алергијске болести. |
 |
Поводом обележавања Дана сестринства, обавештавамо Вас да ће се 10.05.2024 на платоу Народне баште у периоду од 9- 12 часова одржати БАЗАР ЗДРАВЉА. |
 |
Светски дан бабица се обележава сваке године 5. маја како би се истакла важност улоге медицинских стручњака из ове области. Гинеколошко-акушерске сестре су кључни чланови тима у пружању неге женама током трудноће, порођаја и постпорођајног периода, као и у дијагностици и лечењу гинеколошких обољења. |
| По милости Божјој православни Архиепископ пећки, Митрополит београдско-карловачки и Патријарх српски, са свим архијерејима Српске Православне Цркве – свештенству, монаштву и свим синовима и кћерима наше свете Цркве: благодат, милост и мир од Бога Оца, и Господа нашега Исуса Христа, и Духа Светога, уз радосни васкршњи поздрав: ХРИСТОС ВАСКРСЕ! |
| Међународна организација рада обележава овај дан организовањем кампања за подизање свести, која фокусира пажњу међународне јавности на проблеме у овој области и промоцију безбедности и здравља на раду. |
 |
На основу препорука и закључака које смо добили испред Министарства здравља Републике Србије обавештавамо вас да ће се сваког четвртка у 12.30 часова одржавати школица за труднице на Oдељењу гинекологије и акушерства. |
| Сваке године, 22-ог априла обележава се Међународни Дан планете Земље у циљу скретања пажње грађанима на значај очувања природе и спречавања негативних последица по животну средину. Данашњи дан се од 1970. године у целом свету обележава као Међународни Дан наше планете. |
| Последњих годину дана у јавности се доста говорило о акушерском насиљу - између осталог о односу између лекара и породиља. Говорило се о информисању жене о току медицинског захвата, као и о тражењу сагласности за медицински захват. |
 |
Сваког 20.априла обележава се Међународни дан заштите од буке са циљем да се смање нивои буке којима је становништво изложено. |
 |
Како би се олакшао и упростио поступак састављања јеловника за дијабетичаре - уведено је рачунање. Рачунање замењује мерење хране вагом. Пошто се 60% потреба добија из угљених хидрата, потребно је упознати угљенохидратну или шећерну јединицу. Треба знати рачунати колико сваки оброк има шећерних јединица, калорија, слатког индекса, итд. |
 |
Са првим излагањем сунцу на нашој кожи често се појављују алергијске реакције. Црвенило, свраб, осип, мехурићи или болни чворићи на кожи врло су непријатни, а јављају се неколико минута до неколико дана од првог излагања коже сунцу. |
 |
У условима нормалне исхране не долази до дефицита Ц витамина јер човек из воћа и поврћа задовољава 90 % потреба, млека и млечних производа 5 %, јаја, рибе и меса 1 % потреба. |
 |
Витамин Ц или аскорбинска киселина је витамин растворљив у води, а присутан је у свежем воћу и поврћу. Он је један од најиспитанијих и највише описаних витамина. Учествује у бројним биолошким процесима. |
 |
„Herpes labialis" („herpes febrilis") – је веома честа грозница. Може се појавити на уснама, носу, устима и образу. Узрокује га херпес-вирус тип 1. Херпес вирус тип 2 обично узрокује инфекцију на полним органима. Оба вируса могу узроковати појаву плика на лицу и полним органима. |
 |
Крпељи су паразити топлокрвних животиња, а ретко и човека. Шуме и пропланци пружају им дом, а људима који их посећују ради излета или због посла, могу узроковати неугодности. Значајни су јер могу преносити неке болести, али на срећу само мали број крпеља носи узрочнике болести. |
 |
Сваке године, 7 априла - на дан оснивања Светске здравствене организације, међународне организације основане са визијом да сваки појединац има право да оствари највиши могући ниво здравља, обележава се Светски дан здравља, као глобална платформа за подизање свести о здравственим питањима и мобилисање напора за промовисање здравијег живота. |
 |
Ларингитиси су запаљења гркљана, обично се јављају у склопу запаљенских процеса дисајних путева а ређе изоловано. |
 |
Већина инсеката који живе у нашем поднебљу немају отров који би непосредно при убоду угрозио живот човека. Најчешћи убоди су од пчеле, осе, стршљена и комарца, а на месту убода се јавља само оток и бол, а касније свраб. Међутим, ако у кратком времену дође до убода већег броја инсеката (рој) могу се појавити знаци тровања са оштећењем нервног система. |
 |
Проводимо прве дане пролећа који нам доносе тзв. „пролећни умор" који је последица мањка витамина Ц који током зиме нисмо довољно уносили услед једноличне исхране |
 |
Са доласком пролећа смо активнији и проводимо више времена у природи. Последњих година деца и одрасли се све више суочавају са симптомима алергије чији узрочници су алергени из природе: полен дрвећа, трава и корова. Ово су спољашњи инхалаторни алергени, а постоје и инхалаторни алергени из унутрашње средине: прашина, гриње, длака домаћих животиња. Поред инхалаторних алергена, алергијска реакција може се јавити и код уношења одређених намирница (нутритивни алергени), затим постоји алергија на лекове, као и алергија на контактне алергене, инсекте, хладноћу, топлоту, сунчево зрачење. |
 |
Главобоља и повишен крвни притисак били су први симптоми које је осетио Павловић Милан. Када су постали учестали, јавио се доктору Горану Војиновићу, нефрологу у Општој болници Панчево, који га је упутио на испитивање у Клинички центар, где је утврђено да су бубрези пред отказивањем. |
| Најчешће хронично респираторно обољење код деце предшколског и школског узраста је астма. Два пута чешће јавља код дечака него код девојчица, али се у периоду адолесценције овај однос изједначава. Продужен експиријум и свирање у грудима указују на астму. |
| Светски дан аутизма обележава се 2. априла последњих петнаест година. Циљ обележавања овог датума је пружање помоћи и повећањe разумевања за особе са аутизмом, дајући им подршку широм света. |
| Трикуспидна стеноза представља сужење трикуспидног ушћа, које отежава пуњење десне коморе срца током дијастоле. Најшечће настаје као последица реуматске грознице и често је удружена са трикуспидном регургитацијом, као и са реуматским обољењем митралног или аортног залиска. |
| Највећи хришћански празник започињемо Великим петком, најтужнијим даном хришћанства. Овај дан посвећујемо Христовом страдању. Проведимо га у миру и молитви у кругу својих породица. |
 |
Инконтиненција, односно невољно отицање урина из бешике, јавља се у свим старосним добима и код оба пола, али знатно чешће код жена. Велики број жена који се суочава са овим проблемом крије и стиди се. У Општој болници раде се операције које отклањају ове проблеме али су познати по томе што желе да уведу и нове иновативне методе. Недавно је на Одељењу Урологије урађена операција иновативном методом. |
 |
Сваке године, 24. марта, обележава се Светски дан борбе против туберкулозе како би се подигла свест јавности о разорним здравственим, друштвеним и економским последицама туберкулозе и појачали напори за окончање епидемије ове болести. |
 |
Међународни дан вода је први пут обележен 22. 03. 1993. одлуком Уједињених нација које су годину дана раније на својој Генералној скупштини донеле резолуцију о томе. Основни циљ овог акта био је подизање свести о глобалној кризи обезбеђивања здравствено безбедне воде за пиће у довољној количини за целокупну људску популацију. |
 |
21.марта — датума изабраног да представља хромозомски дефект који се налази код Дауновог синдрома (двадесет први дан трећег месеца) —обележавамо Светски дан особа са Дауновим синдромом, догађај створен да подигне свест јавности, промовише инклузивност, подстакне залагање и подржавају добробит оних који живе са Дауновим синдромом. |
 |
Национални дан борбе против рака дојке ће се обележавати сваке године, а датум 20. март је одабран као први дан пролећа, што симболизује буђење природе и стварање новог живота. Србија на овај начин постаје богатија за још један дан посвећен превенцији болести и очувању јавног здравља. |
 |
„Када бубрези откажу неопходна је хемодијализа од које и зависи какав ће бити квалитет живот сваком пацијенту. Постоје квалитетније методе дијализе које су скоро као да је пацијент добио буберг. Ова метода била је и раније доступна само млађим пацијентима сада је захваљући Републичком фонду за здравствено осигурање доступна већем броју пацијента, што је од великог значаја", истиче нефролог др Горан Војиновић шеф одсека Хемодијализе. |
 |
Панчевци су се до сада одлично показали на тесту хуманости. Како сазнајемо у Црвеном крсту Панчево, досадашњи озив грађана да буду хумани и дају крв сваке среде је задовољавајући |
| Бубрези су парни органи, који представљају централни део уринарног система. Смештени су у ретроперитонеалном простору на задњем зиду абдомена, и налазе се са обе стране кичменог стуба. Десни бубрег, потиснут јетром, постављен је мало ниже у односу на леви. |
 |
Процењује се да око 80 милиона људи широм света има глауком а 111,8 милиона људи има предиспозицију да добије глауком до 2040. године. У Србији је претпоставка да од ове болести болује око 100.000 људи јер не постоје прецизни подаци о оболелима јер глауком није болест која се обавезно пријављује. |
 |
Време, у ком живимо, не даје много простора да човек застане,осврне се око себе и укаже довољно пажње онима који је заслужују. Сваким даном схватамо значај жртве, коју су неки људи дали да се изборе за женска права. |
| Повишен крвни притисак је пратилац гојазности у детињству. Постоје ставови о позитивном утицају смањења телесне тежине на снижење артеријског крвног притиска код гојазне деце али нема јасних доказа о дугорочној користи од губитка телесне масе на одрживост регулације крвног притиска. |
| Централно место у лечењу гојазности, хипертензије и резистенције на инсулин код деце представља регулација енергетске равнотеже у склопу промене начина исхране, повећања физичке активности и избегавања претераног седења. Рана идентификација деце са ризиком развоја метаболичког синдрома и даљом прогресијом у дијабетес типа 2 и кардиоваскуларно обољење касније у животу, од великог је значаја за њихову даљу будућност. |
 |
У Панчеву 19.04 и 20.04.2024.године биће одржан међународни форум ортопеда у хотелу Тамиш са темом "CONTROVERSIES IN TRAUMA SURGERY". |
 |
Ебола је хеморагијски филовирус облика штапа за хокеј, прстена или слова У, а припада једној од четири групе ове категорије, из фамилије Филовиридае. То су РНК вируси са полиморфним, понекад и филаментозним вирионом 150-300 нм у дијаметру. Геном се састоји од једноланчане РНК. Имају двослојну липидну мембрану. |
 |
Вирус хепатитиса Ц (ХЦВ) припада РНК вирусима, фамилија „Flaviviridae". Геном чини једнострука РНК а омотач протеини, величине је 35-50 нм. Показује хиперваријабилност регија генома и до сада је описано 12 генотипова. |
 |
Други назив за мононуклеозу је болест пољупца зато што се преноси директним контактом са пљувачком заражене особе. |
 |
Грип и прехлада су вирусне болести дисајних путева. Спадају у капљичне инфекције. Иако симптоми могу бити слични, грип не треба олако схватити – то је озбиљна болест која може изазвати компликације. |
 |
„Промуклост која траје више недеље не треба игнорисати, већ потражити помоћ лекара који ће утврдити да ли се ради о безазленом отоку гласних жица, који се лако лечи, или су у питању промене које могу указати и на малигна обољења", истако је начелник ОРЛ одељења, доктор Вељко Божић. |
| Постоји више од 6000 различитих ретких болести, које тренутно погађају око 300 милиона људи широм света, а пацијентима с ретким болестима у просеку је потребно око пет година да добију дијагнозу. Ретке болести не погађају само пацијенте, већ и њихову породицу, пријатеље и познанике. На пример, две трећине чанова породице проводе више од два сата дневно на пословима повезанима с болешћу члана породице, а седам од десет смањује или прекида своје професионалне активности у циљу адекватне неге. |
| У циљу обележавања Међународног дана ретких болести, данаћ ћемо рећи нешто о неуролошкој болести која је ретка, али која је последњих година центар пажње многих светских неуролошких конгреса. Пре него што кажемо нешто о Фридрајховој атаксији, подсетићемо да је Република Србија прихватила дефиницију Европске комисије, према којој су ретке болести оне које се јављају код мање од пет особа на 10.000 становника. |
| Међународни дан ретких болести обележава се крајем фебруара сваке године од 2007. године, а када је преступна година, одржава се 29.фебруара баш због тога што је редак дан. Самом дану претходе активности у циљу упознавања јавности са проблемима и изазовима са којима се срећу оболели од ретких болести и њихове породице. |
 |
„Крајници су прва одбрана и заштита од вируса и бактерија тако је било раније", напомиње начелник ОРЛ одељења доктор Вељко Божић и додаје да углавном виђају крајнике који се нису ни развили већ представљају могућност да се развијају бактеријске инфекције. Зато су међу најчешћим операције крајника на хирушком Одељењу за ухо, грло и нос |
 |
Месец фебруар посвећен је оболелима од ретких болести у Србији. Међу болестима издваја се и цистична фиброза, наследни поремећај који изазива тешко оштећење плућа, дигестивног система и других органа у телу. Удружење „Цистична фиброза Србије" које окупља оболеле од ове болести, као подршка у њиховој борби са овом доживотном болешћу у Народној башти засађено је 65 ружа за пацијенте који живе у Панчеву. |
| Формирање калкулуса у мокраћном систему и морбидитет који он изазива данас поприма пандемијске размере и у константном је порасту. Калкулус се најчешће формира код особа који живе у земљама са топлом и сувом климом, а преваленција се креће између 2% и 20%. |
| Већина кардиоваскуларних болести је узрокована факторима ризика који се могу контролисати, лечити или модификовати, као што су:висок крвни притисак, висок ниво холестерола, прекомерна ухрањеност/гојазност, употреба дувана, физичканеактивност и шећерна болест. Међутим, постоје и неки фактори ризика који не могу да се контролишу. Међу најзначајније факторе ризика, који су одговорни за смртност од КВБ, убрајају се повишен крвни притисак(коме се приписује 13% смртних случајева на глобалном нивоу), затим употреба дувана (9%), повишен ниво шећера у крви (6%), физичка неактивност (6%) и прекомерна телесна маса и гојазност (5%). |
 |
„Acinetobacter" је Грам негативан, полиморфан, стриктни аероб, распрострањен у природи као сапрофит или представља део физиолошке флоре човека (кожа, дисајни путеви и генитални тракт). То су кратки здепасти, а понекад и округласти бацили. Често имају капсулу. Каталаза су позитивни а оксидаза негативни. Често је присутан у болничкој средини (лавабои, катетери, ваздух и др). |
 |
Протеуси су широко распростарњени у природи, присутни су у земљишту, води и намирницама. Прилагођени су и паразитском начину живота. Типични су представници опортунистичких бактерија, што значи да почињу да се размножавају када падне имунитет организма. |
|
„Burkholderia mallei" је аеробна, Грам негативна, непокретна бактерија. Не ствара капсулу. Колоније су ситне, подсећају на капљице меда. Ова бактерија је интересантна, јер се сматра потенцијалним биолошким оружјем у биолошком тероризму. |
 |
„Burkholderia pseudomallei" („Malleomyces pseudomallei", „Actinobacillus pseudomallei") је штапићаста, Грам негативна, покретна бактерија, присутна на тлу и у водама у тропским пределима. Ова бактерија је интересантна, јер се сматра потенцијалним биолошким оружјем у биолошком тероризму. |
 |
„Mycoplasma pneumoniae" изазива интерстицијалне (атипичне) пнеумоније. Директно оштећује респираторни епител токсинима, ензимом (пероксиадаза). Инкубација болести је 2 - 3 недеље. Инфекција започиње температуром, малаксалошћу, главобољом. Од стране респираторног система јављају се кашаљ, бол иза грудне кости. |
 |
Светска здравствена организација и Међународно удружење за борбу против рака већ традиционално обележавају Светски дан борбе против рака сваког 4. фебруара. |
 |
У Србији се сваког 31. јануара обележава Национални дан без дувана, а ове године под слоганом „365 дана без дувана”. У свету због употребе дувана превремено умре око 8 милиона људи. |
 |
Врсте из рода „Enterobacter" изазивају опортунистичке инфекције у случају пролазне или трајне имунодефицијенције домаћина, колонизације нових ткива и пораста вируленције. Најчешће изазивају инфекције уринарног тракта, мада нису ретке ни примарне или секундарне инфекције респираторног система. |
 |
„Salmonella typhi" је Грам негативан бацил из фамилије „Enterobacteriaceae", величине 2 - 4 микрона, покретан обавијен трепљама, аспороген, осетљив на хемијске и физичке агенсе. Температура од 55°С га убија за 30 минута, а отпоран је на ниске температуре. |
 |
Салмонела су грам негативни бацили из фамилије „Enterobacteriaceae", величине 2 - 4 микрона, покретне обавијене трепљама, аспорогене, осетљиве на хемијске и физичке агенсе. Температура од 55°C их убија за 30 минута, а отпорне су на ниске температуре. |
 |
Салмонела је род бактерија. Постоји више подела ове бактерије, а због места на ком „живе“ спадају у групу патогених цревних бактерија. Од њих добијамо обољење које се назива салмонелоза, које често називамо по њеном узрочнику – салмонели. |
 |
Током прошле године у Очној болници Опште болнице Панчево обављено је близу хиљаду операција катаракте. Тренутно је на листи око 200 пацијeната који ће бити оперисани у наредна три месеца. |
| У великом броју рандомизовано контролисаних и опсервационих студија обухваћених метаанализама утврђено је смањење ризика за појаву рецидивантних епизода калкулозе чак од 60% до 80% уколико је дошло до значајно повећаног уноса течности, и то првенствено воде. |
| Национални дан без дуванског дима обележава се 31. јануара са циљем да се јавности скрене пажња на штетност цигарета и дуванског дима. |
 |
Да је пас ујео човека прича је коју можемо да чујемо, али да човек уједе човека ретко се среће, бар тако мислимо. Другачију причу нам је потврдио доктор Вељко Божић, оториноларинголог и начелник ОРЛ одељења Опште болнице Панчево. |
 |
Од 2007. године, сваке године трећа недеља јануара се обележава као Европска недеља превенције карцинома грлића материце. Ова иницијатива је покренута од стране Европске асоцијације за борбу против карцинома грлића материцe (European Campus Card Association-ECCA) |
 |
Toком празника већина нас жели да проведе време са својим најближима, међутим неки од нас ове године нису имали ту могућност, нажалост међу њима били су и наши најмлађи. На Дечијем одељењу Опште болнице Панчево било је оних о којима су наши здравствени радници бринули и помагали им да у нову годину уђу здравији и јачи. |
 |
„Gardnerella vaginalis" је мали Грам негативан, непокретан бацил. У нормалним условима налази у материци, као и дебелом цреву, а код њеног прекомерног размножавања (стрес, промена полног партнера, губитак природне флоре) настаје болест - бактеријска вагиноза или амински колпитис. |
|
Род „Haemophilus" чине мали, непокретни, аспорогени Грам негативни бацили, за чије култивисање је неопходна крв у подлози са факторима „X и V. Haemophilus influenzae" има спољашњу мембрану и продукује ендотоксин. На основу грађе полисахарида облици са капсулом су подељени на 6 серотипова. |
 |
Род „Clostridium" чине бројне бактеријске врсте. То су Грам позитивни бацили који у старим културама испољавају Грам лабилност. У препаратима културе се виде као дуги и танки штапићи, распоређени појединачно или у виду пакета чиода, са округлом терминалном спором која својом величином деформише тело бактерије, тако да личе на чиоду, палицу за добош или шибицу. |
 |
„Mycobacterium tuberculosis" припада роду „Mycobacterium", а фамилији „Mycobacteriае". Немогућност одбојавања алкохолом и киселином (ацидоалкоххолорезистенција) и богатство ћелијског зида липидима су главне карактеристике рода. |
 |
Крајем прошле године у Општој болници Панчево запослен је велики број лекара и медицинских сестара захваљујући одговорном пословању менаџмента болнице. У специјалистичком центру се сад указала могућност да се лакше долази до појединих лекара специјалиста. |
 |
Данас обележавамо Нову годину према Јулијанском календару, код нас познатија као Српска Нова година, то је традиција коју са предака преносимо на будућа поколења |
| Већина кардиоваскуларних болести је узрокована факторима ризика који се могу контролисати, лечити или модификовати, као што су:висок крвни притисак, висок ниво холестерола, прекомерна ухрањеност/гојазност, употреба дувана, физичка неактивност и шећерна болест. Међутим, постоје и неки фактори ризика који не могу да се контролишу. Међу најзначајније факторе ризика, који су одговорни за смртност од КВБ, убрајају се повишен крвни притисак(коме се приписује 13% смртних случајева на глобалном нивоу), затим употреба дувана (9%), повишен ниво шећера у крви (6%), физичка неактивност (6%) и прекомерна телесна маса и гојазност (5%). |
| Чир на желуцу и дванаестопалачном цревује оштећење(дефект) слузокоже желуца и дванаестопалачног црева(налик рани на кожи).Настаје као последица нарушавања равнотеже између одбрамбених фактора и штетних фактора слузнице желуца, због чега долази до продора желудачне киселине кроз заштитни слој слузнице и стварања чира (улкуса). |
 |
Током празника број пацијента у Пријемно-ургентној служби Опште болнице Панчево није се смањивао. У просеку је дневно прегледано, само у овој служби, до сто пацијента. Помоћ је најчешће указивана хирушким и интернистичким пацијентима. |
| Бадњи дан и Бадње вече, који најављују Божић, празник рођења Исуса Христа, желимо да проведете у миру са својим најближима. У години има много дана али нису сви исти. Нека вам данашњи Бадњи дан донесе мир у дом и радост у срце. Срећан празник уз пуно љубави и топлине! Светлост данашњег празника у дом нека унесе прегршт најлепших осећања, душа нека вам буде испуњена миром, а срце љубављу! |
 |
„Bartonella henselae" је мали, полиморфни Грам негативни бацил који се култивише на обичним хранилиштима. Осетљив је на већину антибиотика. |
 |
„Тreponema carateum" је спирохета (бактерија спиралног облика). Анаеробни је ткивни паразит, веома неотпорна и ван живог организма брзо угине. Има танак и дугачак облик, са зашиљеним крајевима и правилним спиралним навојима, чији број варира од 4 -14. |
 |
„Treponema pertenue" је спирохета (бактерија спиралног облика). Има танак и дугачак облик, са зашиљеним крајевима и правилним спиралним навојима, чији број варира од 4-14. |
 |
„Actinomyces israelii" је спорогена Грам позитивна анаеробна бактерија. Због своје филаментозне структуре „Actinomyces israelii" дуго је сврставана међу гљиве. Припада сапрофитној флори човека и животиња и најчешће се налази у устима, ждрелу и дебелом цреву. |
 |
Инфекције уринарног тракта су честе у детињству. Могу се јавити код свих узраста деце и захватити различите делове уринарног система. Чешће су код девојчица него код дечака, а према узрасној групи су најчешће код деце до 5 година живота. |
 |
Само седам минута после поноћи у породилишту Опште болнице Панчево је рођена прва беба и то девојчица. Од почетка године још двадесет четири бебе су рођене. То су најлепше вести, како за родитеље и родбину тако и за све нас јер је наш град богатији за те мале дивне становнике. |
| Долазак Нове године доноси са собом чаролију и наду за све нас. То је време када се свет окреће обећањима и жељама за бољом будућношћу. Зато би требало заборавити на све лоше тренутке и свима опростити. |
 |
Залихе крви су на минимуму, највише недостаје нулта крвна група. Прва акција добровољног давања крви је 3. јануара у просторијама Црвеног крста Панчево. |
| Божић је најлепши и свакако најрадоснији дан у години за све који искрено верују и поштују Христа Бога. На тај дан рођен је Господ Исус Христос.Остварите оно што желите и сачувајте оно што волите. |
 |
Сигурно сте чули да самостално вађење крпеља није препоручљиво и да је одлазак код доктора обавезан. Ово је тако зато што постоје крпељи који су заражени, а да то једноставно не може бити уочљиво на самом крпељу или при уједу, обзиром да се не разликује од уједа незараженог крпеља. |
 |
Пробиотици су живе бактерије и квасци које су добре за пробавни систем и здравље целог организма. У телу има много бактерија, неке од њих су добре, док су друге лоше. Пробиотици спадају у добре бактерије јер користе организму да буде здрав, а пре свега цревима и целокупном систему за варење. |
 |
Члан удружења „Леука" тренутно ради о Општој болници Панчево, добровољни је давалац тромбоцита где се сусреће са хематолошким болесницима и зна шта значи донорство. „Моје радно искуство у Општој болници Панчево помогло ми је да схватим колико је битно добровољно давалаштво зато што ми се не мало пута десило да је мојим пацијентима неопходна трансфузија тромбоцита, а ја нисам био у могућности да им то обезбедим", каже др Видоје Крсмановић лекар Опште болнице Панчево |
| Традиционална награда ''Капетан Миша Анастасијевић'' додељена је у Галерији Матице српске најуспешнијим појединцима и институцијама из различитих области друштвеног живота. Међу лауреатима нашли су се и покрајинска секретарка за финансије Смиљка Јовановић, као и дирекор Опште болнице у Панчеву, др Слободан Овука. |
 |
У претходних седам година на сваком одељењу увели смо нове иноватовне методе, операције и повећали број услуга, а запослили смо и стотину младих лекара и тако успешно пребродили смену генерација |
| Дана 10. децембра 2023. године обележава се 75 година од једног од најреволуционарнијих глобалних преокрета: Универзалне декларације о људским правима. Овај значајан документ садржи неотуђива права на која свако има право као људско биће - без обзира на расу, боју коже, веру, пол, језик, политичко или друго мишљење, национално или социјално порекло. Овогодишњи слоган дана људских права је „Слобода, једнакост и правда за све.“ |
 |
Опремљеност Опште болнице у Панчеву значајно је унапређена великодушном донацијом нове операционе лампе. Овај драгоцени допринос болници омогућен је захваљујући напорима угледних привредника из Панчева и Ротари клуба Панчево, у сарадњи с ротаријанцима из Сједињених Америчких Држава, Велике Британије, Финске, Чешке и уз подршку УСАИД-а. |
 |
Током два дана викенда око 100 пацијена је затражило помоћ у амбуланти на ОРЛ оделејењу Опште болнице. Поред збрињавања пацијента који су доживели саобраћајну незгоду углавном су били лаки случајеви, највише деце због упале уха. |
 |
„Treponema pallidum" је спирохета, има танак и дугачак облик, величине до 15 μм. Креће се карактеристичним покретима око замишљене осовине бактерије. Антигенска грађа није детаљно позната. Сигурно је да „Treponema pallidum" стимулише параметре, како хумоталног тако и ћелијског имунског одговора. Изазивач је једне од најтежих полних болести и стриктни је паразит човека. |
 |
„Klebsiella pneumoniae ss. pneumoniae" припада врсти „Klebsiella pneumoniae", роду „Klebsiella", а породици „Enterobacteriaceae". Све „Klebsiella"-е су Грам негативни бацили са заобљеним крајевима. Распоређују се појединачно или у виду парова. Немају флагеле и непокретне су. |
 |
Ешерихија коли чини знатан део физиолошке микрофлоре цревног тракта људи и животиња. Првенствено борави у дебелом цреву. |
 |
Хелико бактерија - „Helicobacter pylori" је веома ситан, у облику запете, изразито покретан и Грам негативан бацил. Хелико бактерија је спирална бактерија која је нађена на слузници желуца. Једина је бактерија која може преживети у изразито киселом желудачном садржају, са врло мало кисеоника, при температури од 37 C. |
 |
„Staphylococcus aureus" - златни стафилокок је Грам - позитивна округла бактерија. Факултативно је анаеробни организам. Непокретан је и не ствара поре. |
| Међународни дан особа са посебним потребама се обележава сваке године 3. децембра од 1992. године како би се промовисало пуно и равноправно учешцће особа са посебним потребама и предузеле мере за њихово укључивање у све аспекте друштва и развоја. |
 |
У Специјалистичком центру Опште болнице еминентни дерматолози из Српског лекарског друштва заједно са панчевалким дерматолозима у суботу ће организовати едукацију за пацијенте са псоријазом и представити лечење савременом биолошкоом терапијом запацијенте са тежим обликом псоријазе. |
| Миксом је најчешћи примарни тумор срца и најчешћи бенигни тумор срца. Миксоми представљају око 50% свих примарних тумора виђених на аутопсијама.Најчешће су локализовани у левој преткомори у преко 86% и најчешће су солитарни.По учесталости следи локализација у десној преткомори. Ретко су локализовани у коморама и тада су у близини атриовентрикуларних (АВ) ушћа. |
| Један од тумор-маркера који већ две деценије чини минимум стандарда за дијагнозу и праћење пацијената са карциномом простате је простата-специфични антиген (ПСА). |
| Дерматовенеролошка секција Српског лекарског друштва спроводи пројекат „За живот без псоријазе“са циљем да се унапреди лечење пацијената са псоријазом у Србији. У оквиру пројекта, Општа болница Панчево организује 2. децембра од 10-14 сати едукацију за пацијенте са псоријазом. Едукацију ће обављати проф. др Душан Шкиљевић из Универзитетског клиничког центра Србије и дерматолози из Опште болнице Панчево, др Слађана Томовић, др Маја Митровић и др Зоран Недић. Моле се сви заинтересовани да се пријаве на телефон број 013 25 17 883. |
 |
25. новембар одабран је као Међународни дан борбе против насиља над женама у знак сећања на сестре Мирабал које је 1960. године у Доминиканској републици на бруталан начин убио диктатор Рафаел Трухиљо. |
 |
У нашем операционом блоку свакога дана се раде операције из области урологије, опште хирургије, гинекологије, ортопедије и пластичне хирургије. Имамо такође и операционе сале на ОРЛ и Офталмолошком одељењу које су одвојене локацијски од нашег блока. Свакога дана имамо планиране операције и циљ је да на време оперишемо пре него што то постане хитно. |
 |
Суграђанима је упућен апел да уколко су у могућности дођу на редовнe акцијe добровољног давања крви у просторије Црвеног крста Панчево јер недостају све крвне групе. |
 |
Запошљавање лекара и младих кадрова наставља се у Општој болници Панчево, за последњих 7 година запослено је преко стотину младих лекара и многи од њих су тренутно на специјализацији. Доктор Слободан Овука директор Опште болнице Панчево, истиче да је важно што је скоро сва опрема обновљена у болници, али све то не би било довољно уколико не бисмо имали ко да нас лечи. |
| Гастритис је хистолошки доказана инфламација слузокоже желуца. Дели се на акутни и хронични гастритис. Етиолошка подела гастритисе дели на инфективне и неинфективне. Откриће Хеликобактер пилори инфекције потпуно је променило поглед на етиологију гастритиса. Данас се зна да је најчешћи узрочник (у преко 90% случајева) инфективног гастритиса Хеликобактер пилори, а потом Хеликобактер хеилмани и ентеровируси. |
| Виплова болест представља ретко, хронично мултисистемско обољење, највероватније инфективне етиологије. Болест захвата танко црево, изазивајући малапсорпциони синдром, али може да захватати и различите зглобове, кардиоваскуларни и централни нервни систем и очи. |
 |
Данас се обележава Светски дан превремено рођених беба, како би се подигла свест о изазовима превременог порођаја и указало на последице са којима се суочавају превремено рођене бебе и њихове породице. |
 |
Цијаноза представља плаву, модру пребојеност коже и слузокожа. |
 |
Палпитације представљају осећаје јаког и убрзаног лупања срца. |
 |
Нарцистички родитељи постоје одувек, то није новина савременог доба - али се тек у новијем добу говори о томе. Овај текст се бави најчешћим последицама одрастања уз нарцистичког родитеља у пракси. |
 |
Биполарни поремаћај се карактерише променама расположења, од дубоке депресије до екстремне еуфорије. Оне се понекад брзо смјењују, а понекад поједина фаза траје данима. Известан број особа с овим поремећајем осећа само депресију, са тек повременом тзв. маничном фазом. |
| Светски дан борбе против опструктивне болести плућа обележава се сваке године 15. новембра и за циљ има подизање свести о обољевању и могућности превенције обољевања. |
| Светски Дан борбе против дијабетеса (WDD) се обележава сваке године 14. новембра, на рођендан сер Фредерика Бентинга, који је 1922. заједно са Чарлсом Бестом открио инсулин. Представља највећу светску кампању усмерену на подизање свести о дијабетесу. |
 |
Дана 14. новембра 2023.године обележена је лекарска слава св. Козма и Дамјан -Врачеви, сечењем колача уз присуство свештенства СПЦ, менаџмента Опште болнице Панчево, Дома здравља Панчево и Завода за јавно здравље Панчево кумова славе и многобројних здравствених радника. |
 |
Новембар је месец борбе против рака плућа, и његовим обележавањем пружа се могућност заједници да подигне свест о факторима ризика за настанак ове болести и истакне начине за смањење терета који ова болест доноси широм света. Рак плућа брзо расте, рано метастазира, обично се касно открива те је постао један од највећих здравствених проблема на глобалном нивоу. |
 |
„Један велики професионализам људи, од спремачице до лекара специјалиста допринели су да добијем ову награду. Свега не би било да нисмо имали подршку државног врха и председника Алексаднара Вучића захваљујући чијем личном залагању је урађена реконструкција интерног одељења, добили смо нову опрему, а запослен је и велики број нових људи“ |
| Велики кашаљ је болест која је већ помало заборављена а сада се поново појавила у Србији. |
| Псоријаза је хронична, неинфективна и рецидивирајућа болест коже. Генетски је предиспонирана, али до развоја болести увек доводи већи број фактора који здружено делују. Најчешћи фактори који представљају „окидач“ за испољавање псоријазе су: стрес, инфективни агенси, хронична микротраума ( притисак при ослањању на лактове,...) лекови( Б блокатори, антималарици...)... |
| Рак дојке је најчешћи малигни тумор код жена. На првом је месту на листи узрока смрти жена од малигних тумора. Годишње се у Србији региструје око 4000 новооболелих и око 1570 умрлих жена од ове болести. |
 |
Нажалост болест брзо напредује и за кратко време бубрези отказују зато је погрешно одлагати хемодијализу. Убедити младог човека који још има снаге је тешко, али како време одмиче пацијент сам осећа замор, не може да спава, бори се за дах и онда схватају да морају себи да помогну. |
 |
Рад ортопеда током операција после више деценија у Општој болници Панчево је олакшан. Уграђене су нове операционе лампе уместо старих које су уграђене када је изграђена и сама панчевачка болница, захваљући акцији у коју се укључио велики број привредника и грађана скупљена су средства за замену старе опреме. |
 |
Тромбофилија представља стање појачаног згрушавања (коагулације) крви, које може изазвати тромбозу – угрушке крви у крвним судовима. Не сматра се врстом болести, јер многи људи, код којих је дијагностикована, немају проблем са својим стањем. Тек пошто се уради анализа крви и установи да је потребно бити опрезан, приступа се адекватној терапији уз редовно контролисање стања. |
 |
Тромбофилија је стање које повећава ризик од стварања крвних угрушака. Тромбофилија није болест, већ стање повећане склоности за настанак тромбозе у циркулацији. |
 |
Упорност, истрајност и вера били су довољни да Ненад Мишчевић и Радован Перовић из Старчева пешице стигну до Острога и укључе у своју акцију све хумане људе и прикупе преко милион и по динара за куповину нових апарата за Дечије интерно одељење Опште болнице Панчево. |
 |
Захваљујући јавном конкурсу Покрајинског секретаријата за здравство за доделу средстава за изградњу, одржавање и опремање здравствених установа чији је оснивач Аутономна покрајина Војводина, Општа болница Панчево добила је прилику да набави два високорезолуциона 12-канална ЕКГ апарата са припадајућим системима и опремом. |
 |
Општа болница Панчево може се, са изузетним поносом, похвалити да је набавила значајну медицинску опрему за одсек гастроентерологије са ендоскопском дијагностиком. Ова изузетно вредна набавка реализована је из средстава која су нашој болници додељена након спроведеног јавног конкурса Покрајинског секретаријата за здравство за доделу средстава за изградњу, одржавање и опремање здравствених установа чији је оснивач Аутономна покрајина Војводина. |
 |
Светски дан менопаузе настао је као средство за подизање свести о фази у животу жене када престане менструација. Први светски месец посвећен менопаузи био је у октобру 2014. године. Међународно друштво за менопаузу га је промовисало и покренуло кампању под називом „Превенција болести након менопаузе.“ Циљ је био да се подигне свест о хроничним болестима за које је већа вероватноћа да ће захватити жене након менопаузе. |
| Светски дан против остеопорозе обележава се сваке године са циљем да се подигне свест о превенцији, дијагностици и лечењу остеопорозе. Остеопороза представља системски скелетни поремећај који носи повећан ризик од прелома због смањене снаге и густине кости. |
 |
У Општој болници Панчево почетком месеца 2. октобра отпочета је редовна вакцинација за сезону 2023/24 против вируса грипе. Вакцинација се врши четворовалентном вакцином „INFLUVAC TETRA". |
 |
Најбезбедији и најефикаснији начин индивидуалне и колективне заштите од грипа је вакцинација сваке сезоне. Као што је познато, грип је честа респираторна болест која се у највећем броју случајева испољава са симптомима прехладе, као што су цурење носа, бол у грлу или повишена температура. Оно што грип разликује од прехладе је да се јавља нагло и да има додатне симптоме у виду бола у зглобовима, малаксалости, грознице, главобоље, губитка апетита, повраћања, дијареје или кашља. Грип је веома озбиљна болест, мада многи људи мисле да је грип само прехлада. Он може довести до тешких компликација које захтевају болничко лечење, а у неким случајевима и до смртног исхода. |
 |
Јесен и зима не доносе нам само хладније време, кишу и снег већ и појаву прехладе и/или грипа. Сезонски грип се јавља током хладнијег дела године, односно током јесени и зиме. Због тога се често тај период и назива „сезона вируса”. Сваке године од грипа оболи око 30% популације на глобалном нивоу, 3–5 милиона развије тешку клиничку слику која захтева хоспитализацију, а 250–650 хиљада људи умре од последица ове болести. |
 |
Сваког 17. октобра од 1987. године обележава се Међународни дан борбе против сиромаштва. Циљ обележавања овог датума је ширење свести о потреби искорењавања сиромаштва у целом свету, а нарочито у земљама у развоју. Према подацима УНИЦЕФ-а, 22 000 деце у свету дневно умре због сиромаштва. |
| Хронична бубрежна слабост је прогресивно оштећење свих бубрежних функција које води ка терминалној фази болести где симптоматска терапија није довољна. Тада је за продужетак живота неопходно применити једну од метода замене бубрежне функције (хемодијализа, перитонеумска дијализа и трансплантација бубрега). |
| Светски дан вида обележава се сваке године 14. октобра с намером да се упозори на проблеме слепих и слабовидих особа и особа са оштећеним видом, те да допринесе решавању тог глобалног здравственог проблема. Чуло вида је важно за живот сваког човека и представља изузетно софицтициран орган који може да се пореди са фотоапаратом. |
 |
Веома је важно имати довољно крви у сваком моментy за грађане који се лече у Општој болници Панчево или некој другој здравствено установи. Са једним давањем крви може се некоме знатно побољшати здравствено стање, а није редак случај ни да се некоме спасе живот. Зато је наша дужност да подигнемо свест грађана Панчева на важност добровољног давања крви. |
| Генерална скупштина Уједињених нација је на иницијативу међународне коалиције „Прање руку сапуном“ прогласила 2008. годину Међународном годином санитације и обележен је први Светски дан чистих руку - 15. октобар, који је прихваћен ид стране влада, међународних институција, невладиних организација, приватних предузећа и појединаца у више од 70 земаља широм света. Светски дан чистих руку биће централни догађај у активностима које треба да дају подстицај и мобилишу милионе људи широм света да перу своје руке сапуном |
| Организација за храну и пољопривреду као специјализовану агенцију уједињених нација основана је 1945. године. Организација ради у преко 130 земаља широм света. Циљ организације је да се постигне сигурност хране за све и да обезбеди да људи имају редован приступ довољно квалитетној храни и да воде активан, здрав живот. |
| Два Панчевца Ненад Мишчевић и Радован Петровић, у оквиру хуманог ходочашћа „ За нашу децу, пут ка свецу “ прешла су пут од Панчева до манастира Острог, дугачак 444 км у циљу прикупљања средстава за потребе Дечијег одељења Опште Болнице Панчево. Током пешачења које трајало од 29. априла до 09. маја 2023. године, на рачун ОБ Панчево пристигле су значајне донације како од правних тако и од физичких лица, чиме је пружена подршка набавци опреме за потребе наших најмлађих пацијената. Од прикупљених средстава набављена је следећа медицинска опрема: два оксиметра, два ЕКГ апарата, једна инфузиона пумпа, један дефибрилатор и један пацијент монитор. |
 |
Током последњих седам година у Служби Ортопедије са трауматологијом Опште болнице Панчево начињени су крупни кораци у смислу унапређења рада и лечења пацијената. До 2016. године, просечан број операција у Служби Ортопедије са трауматологијом је на годишњем нивоу био 450. Постепеним повећавањем, 2022. године смо успели да достигнемо број од 1100 операција годишње. |
 |
Исхемијски колитис је оштећење сегмената дебелог црева, које настаје као последица мезентеричне васкуларне оклузије. |
 |
Дивертикулуми танког црева су локализована проширења цревног зида која су у вези са луменом црева. |
 |
Бенигна билијарна стеноза је у највећем броју случајева последица хируршке трауме. Много ређи узроци су спољне тупе повреде абдомена и ерозија зидова дуктуса жучним каменцима. |
 |
Појава крви у столици није нормална и не треба је игнорисати. Као што није нормално ни крврарење из носа тако није ни крв у столици, али се људи много раније јављају лекару због крварења из носа него због крварења из дебелог црева. Ово је, разумљиво, велика грешка. |
 |
Хронични гастритис представља запаљење желудачне слузнице коју карактерише лимфоплазмацитама инфилтрација. Ово обољењеје често локализовано и неправилно распоређено дуж желудачне слузокоже. |
 |
Под улкусом (чиром) се подразумева локална ерозија, разједина слузокоже са продирањем ка мишићном слоју и дубље, што може довести до настанка перфорације, пуцања чира или, ако оштети крвни суд, до крварења. |
 |
Дијагностика „Helicobacter pylori” ( „H.pylori") инфекције је једна од најчешће примењиваних дијагностичких процедура у гастроентерологији, јер је инциденца и преваленца ове инфекције врло висока. Постоје неинвазивни и инвазивни дијагностички тестови. |
 |
Акутно гастроинтестинално крварење означава појаву крви у дигестивном систему и спада у ред високих приоритета прехоспиталног и хоспиталног лечења. Манифестује се повраћањем крви, ректалним крварењем и црном катранастом столицом. |
 |
Захваљујући индивидуалној терапији која се примењује у амбуланти за терапију бола др Биљана Гавриловић, специјалиста за терапију бола, успева да пацијентима олакша и ублажи бол или их потпуно обезболи. |
| Светски дан менталног здравља 2023. је прилика да се људи и заједнице уједине иза слогана који је ове године „Ментално здравље је универзално људско право“. Неопходно је унапредити знање, подићи свест и покренути акције које промовишу и штите свачије ментално здравље као универзално људско право... |
| Потребно је стално подизати свест јавности о доприносу старијих људи у друштву и њиховом значају. Потребно је ,,раскринкати" стереотипе да су старије конзервативне, беспомоћне, болесне, да мање вреде, да су неспособне за рад. А да би се борили против сререотипа и предрасуда потребна нам је помоћ самих старијих и разумевање млађих особа. |
| У данашњем свету, где је брза храна постала неизбежан део свакодневног живота, поставља се питање: како промовисати здрав начин исхране? Један од одговора на ово питање долази кроз иницијативу која је постала глобални феномен - Национални месец здраве исхране, који се обележава широм света током октобра. Ова манифестација има за циљ да подигне свест о важности здраве исхране и њеног утицаја на опште здравље и добробит. |
| Амиотрофична латерална склероза је неуродегенеративно обољење прогресивног тока и непознатог узорка које се клинички манифестује упоредним оштећењем централних и периферних моторних неурона. |
| Лекари опште медицине су камен темељац у лечењу гојазности. Они су први који процењују пацијенте, дијагностикују гојазност и лече пратеће болести. Они су неизоставни део тима за гојазност и играју кључну улогу у свеобухватном и континуираном третману ових болесника. У идеалном случају, први задатак лекара опште медицине је превенција гојазности. Примарна превенција гојазности је од суштинског значаја, а када се дијагноза гојазности постави захтева сложену, тешку и скупу терапију. |
| Велику важност коју за свако савремено друштво носе болести срца и крвних судова, најбоље описује неколико следећих чињеница: у свету представљају водећи узрок смрти, значајан број ових болести може се спречити упражњавањем здравих стилова живота и сваки здравствени систем може остварити значајну корист уколико се више пажње и ресурса посвети превенцији и контроли кардиоваскуларних болести. |
| Интервентна кардиологија је направила велики помак у лечењу кардиоваскуларних болесника. Спада у област кардиологије која подразумева инванзивну дијагностику и терапију срчаних болести у катетеризационим салама. Методама интервентне кардиологије баве се кардиолози који су специјализовани за ову област. |
 |
Светски дан контрацепције се обележава сваке године 26. септембра. Kампања је покренута 2007. године на глобалном нивоу, са циљем да се истакне важност употребе различитих метода контрацепције и одговорног сексуалног понашања тако да се омогући свим сексуално активним особама, посебно младима, информисан избор о њиховом сексуалном и репродуктивном здрављу. |
| Последњих недеља повећан је број пацијента код којих је потврђен Ковид -19. Појавила се подваријанта омикрона, названа Ерис. На инфективном одељењу Опште болнице Панчево за сада су два пацијента. |
| Светски дан борбе против Алцхајмерове болести обележава се 21. септембра сваке године, када научна и стручна јавност, оболели и њихови ближњи апелују на друштвену заједницу да се уједини у борби против ове болести. |
| Светски дан прве помоћи има за циљ подизање свести о томе како прва помоћ може спречити повреде и спасити животе у свакодневним и кризним ситуацијама, као и промовисање приступачности прве помоћи. Светски дан прве помоћи глобално се обележава сваке друге суботе у септембру. |
| Пиогени гранулом је бенигна израслина на кожи која се најчешће јавља код деце и млађих особа, мада се може јавити и у старијем узрасту. Обично се јавља на прстима шака и на лицу, нарочито на уснама, очним капцима, а може се јавити и на гениталијама. |
| Комедо младеж је бенигна кожна промена која се састоји од груписаних, проширених фоликуларних отвора. Ови отвори су испуњени меканим кератином који у контакту са ваздухом потамни и има изгледа црних тачкица које се зову комедони, зато се и назива Комедо младеж. У народу комедони су познати као митисери ( митесери). Комедони су једна од главих карактеристика при појави бубуљица у пубертету, па се за ову врсту младежа често каже и да је акнеиформни младеж. |
| Реч самоубиство или суицид води порекло од латинског sui, себе, и caedere ,сећи, убити. У литератури реч suicidium први пут споминје сер Т. Браун у књизи ,,Religia medici“ 1642. године, а Дефонтн то чини 1737. Године. Класично се дефинише као чин којим човек сам себи одузме живот. |
 |
Мучнина, повраћање и општа слабост, дете то веома брзо доводи до опште лошег стања. Некада је неопходно и болничко лечење. Тренутно има малишана који бораве на Дечијем интерном одељењу Опште болнице Панчево |
 |
„Ко има неки анамнестички податак да је имао гушења, да се осипа, има неке алергијске манифестације на боравак у природи, на контакт са неким биљкама, не би било лоше да попије антихистаминик или да га бар понесе па да тог момента узме тај антихистаминик, таблете или сируп. Али то би неминовно требали сви да имају у кућној апотеци, јер ми смо кренули од алергија на јагоде, па све сад иде периодично, како неко ново воће или ново поврће долази тако се алергије јављају на друге биљке" |
 |
Особе са нарцистичким поремећајем изузетно утичу на људе у својој околини. Један од облика емоционалног злостављања који примењују је третман ћутањем. Емотивни партнери особа са нарцистичким поремећајем третман ћутањем могу доживети као тежак облик кажњавања. |
 |
Емоционално преједање подразумева конзумирање хране које не прати физиолошке и биолошке потребе. Дакле, ради се о нездравом обрасацу исхране који у ширем смислу јесте класификован у психијатријске поремећаје из групе поремећаја исхране. |
 |
Хипохондрија се може дефинисати као преокупираност страхом или мислима да је особа оболела од неке теже болести, што је последица погрешног тумачења телесних симптома. Преокупираност болешћу стално постоји упркос разуверавања да болест није присутна и одговарајућим прегледима и испитивањима која искључују постојање те болести. |
 |
На почетку болести, оболела особа има осећај сигурности и моћи (“могу да једем колико хоћу а да се не угојим, боља сам од других”). Међутим, то осећање може трајати неко време, можда и годинама, док особа у потпуности не изгуби контролу над својим понашањем, када булимичне кризе постану свакодневне и дешавају се више пута дневно. |
 |
Многи од нас имају своје мале ритуале, често с разлогом да рутина помогне у спречавању заборавности. Али понекад поприме свој посебан ток- увек закључавање врата на посебан начин, или сервирање хране на посебан начин. За неке људе, овакви ритуали могу измаћи контроли и њиховим животима овлада стална брига о малим стварима и потреба за извођењем бескрајних ритуалних радњи. |
 |
Међународни дан младих обележава се сваког 12. августа, са циљем скретања пажње међународне заједнице на питања младих као и на потенцијал младих као партнера у данашњем глобалном друштву. Указује се на значај улоге младих људи у друштву, као и да подстакне младе на организовање активности у циљу скретања пажње јавности о свом положају. |
 |
Светска недеља дојења обележава се у првој недељи августа и то је глобална иницијатива, чији је циљ подизање друштвене свести о значају дојења. Акценат је на указивању имунолошке, нутритивне и емоционалне компоненте у психофизичком развоју одојчета, али и мајке, које се остварују кроз процес дојења. |
 |
Ако имате изненадну потребу за мокрењем коју не можете да контролишете, тада се код вас вероватно ради о уринарној ургентној инконтиненцији. За овај поремећај окривљује се лака инфекција мокраћних канала. |
 |
Циститис представља запаљење мокраћне бешике најчешће изазвано бактеријама, али може настати и због инфекције вирусима, гљивама, деловањем токсичних агенаса, лекова и др. |
 |
Хиперхидратација се описује као тровање водом. Постоје екстраћелијска хиперволемија и хипоосмалитет са прелазом течности у ћелије – интраћелијска хиперхидратација |
 |
Бол при мокрењу, често мокрење или заостајање мокраће (неспособност да се потпуно испразни бешика) најчешћи су проблеми ове врсте. |
 |
Крв у мокраћи (хематурија) без икаквих болова, па макар се јавила и при само једном мокрењу, често је знак присуства малигног тумора на бубрегу или мокраћним потевима и бешици. |
 |
Акутна упала бубрега је инфекција горњег дела уринарног тракта која најчешће настаје продором бактерија из мокраћне бешике путем мокраћовода у бубрег. Пре свега је погођена цревна област и бубрежна карлица или нешто ређе бубрежне тубуле. |
 |
Камен у бубрегу (Нефролитијаза) се дефинише као присуство камена у сабирним тубулима, у чашицама и карлици бубрега. Каменци су клинички значајни јер могу изазвати опструкцију нормалног протока мокраће, поспешити настанак уринарне инфекције, а могу изазвати и јак бол. |
 |
И мушкарци и жене имају мокраћну бешику и уретру, али је она различите грађе. Због тога су неке болести чешће код жена него код мушкараца. На пример, како је уретра код жена у блиском контакту са вагином и анусом, који често садрже бактерије, и како је краћа него код мушкараца, инфекције мокраћне бешике (циститис) и уретре (уретритис) су много чешће код жена. |
 |
Макроскопска хематурија се карактерише смеђкастим или црвеним обојењем урина, које не мора увек бити знак еритроцита у урину (може се јавити после поједине врсте хране, нпр. цвекла). Хематурија може бити инцидентна (после трауме, тежак физички рад), интермитентна (код калкулозе, инфекције уринарних путева) или стална (код паренхимских обољења бубрега) |
 |
Поред хитних хируршких интервенција свакога дана у Општој болници Панчево, ради се редовним програмом. Ни током лета нема смањења. Без обзира што је време годишњих одмора радимо пуном паром |
 |
Симтпом може бити неко чешће мокрење, бол, пецкање при мокрењу, па чак и мокрење крви што обично натера оболеле код нас. То делује драматично, али ако се ради о упали и када имамо бол и сличне симптоме, знамо да је то упалног карактера и не треба нас забрињавати. |
 |
Пиларна кератоза је незаразно обољење коже. Може се некада наћи и под другачијим називом као што је Фоликуларна кератоза или Лихен пиларис, док је у народу познатије као „гушчија кожа“. Тачан узрок настанка промена није утврђен, али је веома могуће да је у питању генетско и наследно обољење, пошто се промене могу наћи и код других чланова породице, а често се јавља код близанаца. |
 |
Хепатитис је вирусно запаљење јетре. Изазивају га вируси хепатитиса (А,Б,Ц,Д,Е). Код неких особа болест добија хроничан ток и временом може довести до цирозе или тумора јетре. Од тегоба може се јавити жутица, уз појаву тамне мокраће и светле столице те малаксалост, слаб апетит, главобоља, мучнина, гађење на масну храну, симптоми слични грипу. |
 |
Сомноленција је најблажи облик квантитативног поремећаја свести, када је болесник поспан, незаинтересован за догађаје у околини. |
 |
Ступор означава одсутност сваке вољне активности, таква особа не реагује ни на какве дражи, не изводи покрете, личи на непокретну лутку. |
 |
Дизартрија се описује као органски поремећај говора који се испољава сметњама у стварању гласова, а који се заснива на нервно - мишићном оштећењу говорне мускулатуре. |
 |
Реч алексија настала је од грчког префикса "а-" (без, не) и речи "lexis" (реч). Алексија је неуролошки поремећај који се карактерише немогућношћу читања или разумевања писаних речи. |
 |
Кома је последица тешког поремећаја функције виталних органа (централни нервни систем, срце, плућа, бубрези, ендокрини поремећаји) изазвани различитим ноксама као што су трауме, тровања, инфекције, поремећаји циркулације, метаболизма, тумори и др. |
 |
Кројцфелд—Јакобова болест спада у спонгиоформне енцефалопатије. Ово је веома тешко обољење које увек завршава летално, а јавља се најчешће код старијих људи (преко 60 година). |
 |
Приликом инфекције вирусом Мумпса (вирус заушака) може настати и инфекција и запаљење можданица (менингитис). |
 |
Мишићне дистрофије су примарна, наследна обољења мишића дегенеративне природе. Најчешће почињу у млађем животном добу и развијају се годинама да би после краће или дуже еволуције учиниле болесника озбиљно хендикепираним и зависним од околине. Имају знатно скраћен животни век и умиру од компликација. |
 |
„Nervus facialis" инервише мимичну мускулатуру. Најважнији мишићи које инервише су „m. frontalis" (набирање чела), „ m. orbicularis oculi" (затварање очију), „m. orbicularis oris" (показивање зуба) и „m. platysma". Остале функција овог живца су парасимпатичка инервација жлезда, густативна инервација предње две трећине језика и сензибилитет бубне дупље. Најчешће обољење „n. facialisa" је Белова парализа. |
 |
Пилонидални синус је хронична инфекција коже интерглутеалне регије,најчешће се налази 2-3 цм изнад ануса. Узрокована је реакцијом длачице које урастају у размекшано ткиво ове регије. |
 |
Веома су честе упале уха током лета, посебно код деце. Зашто се то дешава и колко честе упале уха могу да доведу и до проблема са слухом, објашњава начелник ОРЛ одељења, доктор Вељко Божић. |
 |
Године 2017. објављен је опсежан текст, иницијатива организације „МС Brain Health" „Здравље мозга - Код мултипле склерозе време је важно“ (www.msbrainhealth.org/report). Ову иницијативу је подржало више од 50 референтних организација широм света, међу којима је и Амерички одбор за терапију и истраживања МС, кључна светска и европска удружења пацијената, као и Друштво МС Србије. |
 |
Мултипла склероза (МС) је најчешће неуролошко обољење младих људи. Оболевају особе у доби између двадесете и четрдесете године живота, у време кад се људи налазе у личном, породичном и професионалном успону и постижу најбитније ствари у животу.Мултипла склероза болест код већине оболелих карактерише смењивање погоршања и ремисија, различите дужине трајања (од пар месеци, до више година) и то је релапсно – ремитентна форма МС. |
 |
Анеуризма је абнормално проширење крвних судова. Церебрална анеуризма је абнормално проширење крвног суда у мозгу. На бази мозга налази се сплет артерија од кога се даље рачвају артерије које прокрвљују мозак. Рачве тих артерија најчешћа су места на којима настају анеуризме. Могу се јавити код свих, па тако и у деце, али се најчешће јављају у одраслих од 35 до 60 година, нешто чешће у жена. |
 |
Вртоглавица је поремећај оријентације у простору који се манифестује снажном илузијом кретања у простору. То је неодређен израз који болесници употребљавају да би описали неколико различитих субјективних стања. Уз привид кретања често је присутан и функционални окуломоторички поремећај (нистагмус), рушење у стајању и ходању и мучнина. |
 |
Доласком лепог времена честим боравком у природи, нажалост ни повреде нису ретке, поред пацијената који најчешће помоћ током ноћи потраже због срчаних тегоба, буде и оних којима је због повреда или и уједа кућних љубимаца пружена помоћ у амбуланти. |
| Светски дан становништва обележава се 11. јула од 1987. године, када се на нашој планети родио петомилијардити становник. Тог дана, за време Универзијаде у Загребу, родио се Матеј Гашпар, а Генерална скупштина Уједињених нација одлучила је да Матејев рођендан прогласи Светским даном становништва. |
 |
Јувенилни идиопатски артритис (ЈИА) је запаљење једног или више зглобова са почетком пре 16. ог рођендана, у трајању дужем од 6 недеља и уз обавезу искључивања артритиса друге етиологије. |
 |
Ванзглобни реуматизам обухвата разнородна обољења чија је главна заједничка карактеристика да примарно не захватају саме зглобове него тетиве, тетивне омотаче и припоје (ентезе), бурзе, капсуле зглобова. |
 |
Захваљући пројекту који спроводи компанија НИС „Заједници заједно“ у панчевачко породилиште стигла је најсавременија опрема, ЦТГ ултразвучни апарат и порођајни сто чија је вредност 15 милона динара. |
| Ласер је акроним од Lighth Amplified by Stimulated Emission of Radiation,енглеског назива за појаву појачања светлости помоћу стимулисане емисије зрачења. Ласер мале снаге представља светлосну терапију која имафотохемијски, а не термички ефекат. Механизам дејства ласера мале снаге заснива се на фотобиомодулацији која се фотохемијски одвија на ћелијском и субћелијском нивоу а чине је два супротна процеса фотобиостимулација и фотобиоинхибиција. Ниске дозе стимулишу фотобиостимулацију, а високе фотобиоинхибицију. |
| Интерферентне струје су амплитудно модулисане наизменичне струје ниске фреквенције које настају укрштањем двеју струја средње фреквенције. Наиме преклапањем две средње фреквентне струје, од којих је једна са фиксном фреквенцијом од 4000Hz,а друга са промењивом фреквенцијом од 4000Hz до 4100Hz и са помаком у фази, у дубини ткива настаје интеференција од потпуног поништавања до сумирања амплитуда у предвидивој и ниској фреквенцији.Тиме се постиже ефекат нискофреквентних струја,а избегнут је кожни отпор и непријатни кожни осећај. |
| Терапија ултразвуком подразумева примену ултразвучних таласа фреквенце изнад чујности људског уха у опсегу од 16кHz до 20кHz у терапијске сврхе. |
 |
Служба за физикалну медицину и рехабилитацију Опште болнице Панчево добила је после дугог низа година нову медицинску опрему, и то чак три апарата. Набавка ове опреме финансирана је из сопствених средстава установе, а то је било могуће реализовати захваљујући економичном, домаћинском пословању руководства Опште болнице Панчево. |
 |
Након учешћа на јавном конкурсу Покрајинског секретаријата за здравство за доделу средстава за изградњу, одржавање и опремање здравствених установа чији је оснивач Аутономна покрајина Војводина, Општа болница Панчево добила је значајна средства за набавку нове, најсавременије медицинске опреме. Служба за интерну медицину Опште болнице Панчево постала је богатија за два високорезолуциона 12-канална ЕКГ апарата са припадајућим системима и опремом. Нови високорезолуциони 12-канални ЕКГ апарати са припадајућим системима и опремом занчајно ће утицати на подизање нивоа квалитета рада наших запослених али и задовољства корисника наших услуга. Нови ЕКГ апарати са напредном технологијом, опцијама и алатима, а с обзиром на стручност и обученост нашег кадра, подићи ће на један виши ниво дијагностичке ЕКГ прегледе. |
 |
Општа болница Панчево континуирано наставља са занављањем медицинске опреме. Захваљујући јавном конкурсу Покрајинског секретаријата за здравство за доделу средстава за изградњу, одржавање и опремање здравствених установа чији је оснивач Аутономна покрајина Војводина, Општа болница Панчево добила је прилику да набави два нова апарата и за Службу за офталмологију, а који ће омогућити ефикасније обављање прегледа, односно утицати на још веће скраћење листе чекања за операцију катаракте. Набављен је најсавременији ултразвучни апарат за факоемулзификацију са две ултразвучне сонде, као и апарат за компјутеризовано видно поље. |
| Перианална фистула је комуникација у виду канала са спољашњим и унутрашњим отвором између аноректума и перианалне коже. Перианална фистула може настати након дренаже перианалног апсцеса, фистула се развија у 50% пацијената са апсцесом.Не постоји начин да се предвиди да ли ће након дренаже апсцеса настати перианална фистула. |
| Резолуцијом 42/112, 1987. године Генерална скупштина Уједињених Нација је прогласила 26. јун Међународним даном против злоупотребе и незаконите трговине дрогама. Овај дан обележава се на глобалном, националном и локалном нивоу у многим земљама света у циљу мобилисања појединаца и заједнице за активан однос у сузбијању проблема злоупотребе дрога. Слоган кампање за 2023. годину је „Људи на првом месту: зауставите стигму и дискриминацију, појачајте превенцију”. |
 |
Најчешће је наследна. Симптоми нису изазвани психолошким или медицинским проблемима већ услед клинички значајног стреса или немогућности социјалног функционисања. |
 |
Узрок је непознат, мада се сматра да су предиспонирајући фактори: генетска предиспозиција, стрес, узраст између 20 и 55 година и мушки пол. Сматра се да је неурастенија најчешћи облик неуроза. Неурастенија се манифестује нервном слабошћу све до потпуне исцрпљености снага. Код неурастеније се активирају потенцијална жаришта инфекција, појављују се проблеми са холестеролом, чиром на желуцу или дванаестопалачном цреву. |
 |
Халуцинације су врло честе код болесних од схизофреније, маније, пострауматских поремећаја, делиријума, деменције. Други узроци могу бити интоксикација или опијеност марихуаном, ЛСД-ом, кокаином, креком, хероином, алкохолом. Некада се халуцинације јављају и код тешких болести као што су инсуфицијенција бубрега и јетре и тумори мозга. |
 |
Тријажа представља разврставање повређених и оболелих у одговарајуће групе. Тријажни системи који се користе у условима масовних несрећа морају омогућити брзо препознавање, без потребе детаљног прегледа, оних особа које ће имати највећу корист од раног збрињавања и брзог транспорта у болницу. |
 |
Збрињавање болесника са акутним болом у грудима један је од највећих изазова за лекаре и друго медицинско особље у хитним службама. Иако је често бенигног порекла, важност му даје чињеница да се њиме манифестује велики број животно угрожавајућих болести, пре свих акутни коронарни синдром (АКС) и акутни инфаркт миокарда (АИМ) са ST елевацијом (СТЕМИ), дисекција аорте, плућна емболија, тампонада срца и пнеумоторакс, код којих брзина постављања тачне дијагнозе и започињања лечења имају велики утицај на морталитет. |
 |
Познавање мера основног одржавања живота која представља важну карику у пружању прве помоћи код престанка срчаног рада су део опште културе једног друштва. Овај реанимациони поступак има за циљ да потпомогне оксигенацију крви у плућима и њену допрему до ткива и органа, пре свега до ћелија мозга које су најосетљивије на исхемију и хипоксију. |
| С обзиром на то да су родитељи ипак само људи, сасвим је разумљиво да нису савршени и да с времена на време знају да погреше. Међутим, проблем настаје када њихови поступци почну да траумирају дете и на њега остављају дубоке последице. |
| Међународни дан добровољних давалаца крви обележава се сваке године 14. јуна, а у циљу подизања свести о потреби добровољног давалаштва, унапређења процеса траснфузија, побољшања и унапређивање трансфузиологије као науке, побољшавање услова давања као и повећања броја добровољних давалаца, као и истицање добровољаца као људи киоји својом хуманошћу чувају туђе животе. |
| Апендицитис је упала слепог црева (апендикса). Слепо црево је узани део црева у облику црвуљка, дужине неколико центиметара. Једним крајем слепо црево везано је за почетни део дебелог црева, а други крај му се слепо завршава. У апендиксу се ствара мала количина слузи, која се излучује у почетни део дебелог црева, а зид слепог црева чини лимфатично ткиво, за које се претпоставља да у детињству има улогу у формирању имуног система организма. |
| Мождани удар означава нагло настали фокални, неконвулзивни неуролошки пормећај који траје дуже од 60 минута. Основна карактеристика можданог удара је нагли почетак неуролошких симптома. Повремено се радиолошки откривају неми инфаркти који су се развили без јасних клиничких манифестација. |
| Светски дан човекове средине (или околине) је дан који се обележава у целом свету сваког 5. јуна кроз разне активности и кампање, са циљем да се скрене пажња јавности на бројне еколошке проблеме и потребу очувања животне средине. |
 |
Свирање у грудима може бити и симптом (када га чују друге особе) и знак (када се чује само стетоскопом). За овај симптом се често употребљава енглески термин "wheezing" (визинг). |
 |
Стридор је високотонско инспиријумско континуирано звиждање, које је проузроковано опструкцијом ларинкса и/или трахеје. |
 |
Хипервентилација је симптом и представља убрзано и продубљено дисање. Хипервентилација се јавља као симптом срчаних, пулмоналних обољења, али такође и у току паничних и анксиозних напада. |
 |
Криптококоза је обољење које се најчешће јавља код оболелих од АИДС - а, а које узрокује гљивица "Cryptococcus neoformans". |
 |
Повреде вратног дела трахеје су скоро увек удружене са повредама ларинкса. Код затворених повреда доминантан симптом је гушење, а код отворених и пенетрантних повреда карактеристична је појава пенушаве крви са шиштањем ваздуха кроз отвор. |
 |
Клиничку слику карактерише периодично прогресивно отежано дисање са стридором и кашљем, болесник седи са подигнутом главом и избегава напор. Када је стеноза екстремна настају диспнеја (отежано дисање), инспираторни стридор, цијаноза, страх од угушења, кашаљ и замор. |
| Као и сваке године до сада, 31. маја, се обележава Светски дан борбе против пушења, односно, конзумирања дувана. Кампања коју спроводи Светска здравствена организација има за циљ да подигне свест код људи, односно, упозори на здравствене и социјалне ризике који су у корелацији са конзумирањем дувана. Такође, циљ овакве кампање јесте и да поспеши усвајање адекватних мера, засноване на доказима, којима ће се укупна потрошња дувана и изложеност дувану смањити на минимум. |
 |
Спондилоза је резултат дуготрајног дегенеративног процеса са хипертрофичноим променама, стварањем остеофита (коштани трнови) који могу да проминирајуу у кичмени канал и да доведу до дегенеративних промена на кичменој мождини. |
 |
Кифоза представља деформитет кичменог стуба са постериорним избочењем, најчешће у торакалном делу кичме. |
 |
Гонартроза представља артрозу коленог зглоба. Артроза је дегенеративна промена зглобне хрскавице, која затим узрокује промене и на осталим деловима зглоба (зглобна чаура, кост), а пре или после се карактерише болом и оштећеном функцијом зглоба. |
 |
Коксартроза представља артрозу кука. Артроза је дегенеративна промена зглобне хрскавице, која затим узрокује промене и на осталим деловима зглоба (зглобна чаура, кост), а пре или после се карактерише болом и оштећеном функцијом зглоба. |
 |
Микобактерије могу бити проузроковачи инфекције зглобова и костију. Захватање скелетне мускулатуре има спору клиничку еволуцију. Локалне инфламаторне промене неопажено, подмукло доводе до деструкције и могу спонатно да прелазе кроз фазе егзацербације и ремисије. Системски симптоми су често одсутни. |
| Уједињене нације прогласиле су 22. мај за Међународни дан биодиверзитета. Конвенција о биодиверзитету је усвојена 1992. године у Рио де Жанеиру на Самиту о заштити животне средине.Тада је установљена платформа за заустављање смањивања биодиверзитета који подразумева разноврсност гена, врста и екосистема на Земљи. Главни циљеви овог документа су очување биолошке разноврсности, одрживо коришћење његових компоненти и расподела добробити од коришћења ресурса. |
| Мелена је црна столица као катран,карактеристичног мириса.Може бити у виду црне течне столице- свежа мелена која ожначава скоро крварење,или као формирана црна столица стара мелена. |
| Светски дан борбе против хипертензије обележава се широм света 14. маја. Овај дан се обележава како би се грађанима скренула пажња на значај редовног мерења крвног притиска, и како би се, уколико крвни притисак одскаче од установљених параметара, правовремено поставила дијагноза и одредила терапија. Недијагностикована или лоше лечена хипертензија доводи од оштећења виталних органа и система (срца, мозга, бубрега, периферних артерија), који зависе од тежине и трајања хипертензије и коморбидитета. |
 |
Према Националном календару здравља у Србији се од 1991. године у трећој недељи маја обележава Национална недеља здравља уста и зуба. |
 |
Болест почиње у тинејџерском или раном одраслом добу. Иако је код многих оболелих она хронично обољење, многи болесници могу да воде испуњен и активан живот, посебно захваљујући новим могућностима лечења. |
 |
Први симптом акутне интестиналне опструкције је нагао, оштар, грчевит абдоминални бол. Између епизода колика болесник се може осећати доста добро. Ускоро по појави бола долази до муке, а потом и до повраћања, што може привремено да донекле олакша болове. |
 |
Специјалистички центар Опште болнице Панчево и остале службе у болници раде по устаљеном режиму, прегледи се заказају код изабраног лекара путем изиса. Почињу да стижу апарати од новца који је обезбеђен од Покрајинског секретаријата за здравство. |
 |
Поводом Међународног дана сестринства који се обележава 12. маја, одржан је Базар здравља. Медицинске сестре из Дома Здравља Панчево, Опште болнице Панчево и Завода за јавно здравље Панчево, свој дан обележиле су радно јер су организовале превентивне прегледе за суграђане. |
 |
Због погоршања временских услова, Базар здравља ће се одржати на платоу Дома Здравља. |
| “Јединствена улога медицинске сестре је помагати појединцу, болесном или здравом, у обављању оних активности које придоносе здрављу или опоравку (или мирној смрти), а које би појединац обављао самостално када би имао потребну снагу, вољу и знање.” Вирџинија Хендерсон |
| Национални дан добровољних давалаца крви традиционално се обележава сваког 11. маја, док се у свету он обележава сваког 14. јуна, још од 2005. године, када је Светска здравствена скупштина уврстила овај датум у свој Календар здравља. |
 |
Две трећине људи који умру у Србији, умиру од болести које би се могле спречити примарном превенцијом, при чему је битна промена понашања који је глобални изазов јавног здравља. |
 |
Нешто вам се дешава, али не можете схватити је ли само умор, сметеност или нешто озбиљније. Ако се не можете насмејати, изговорити једноставну реченицу, исплазити равно језик или подићи руке, зовите Хитну. |
 |
Алцхајмерова болест је примарно дегенеративно обољење мозга, непознатог узрока, са карактеристичним променама у мозгу. Типичне промене су амилоидни (сенилни) плакови – густе наслаге протеина изван и око неурона у мозгу и неурофибриларне клубад – несолубилни завијуци влакана унутар неурона. |
 |
Епилепсија је назив за неуролошко обољење, које се манифестује повременим моторним, сензорним, неуропсихичким и доживљајним поремећајима, уз губитак свести. Епилепсија је обољење у чијем се лечењу користе различити терапијски приступи. |
 |
У циљу промоције, унапређења и очувања здравља становништва, саветима за грађане о здравом начину живота, Општа болница Панчево ће се представити на Базару здравља, који ће се одржати у Народној башти у ПЕТАК 12.05.2023. у периоду од 08 до 12 часова. |
 |
Хиперлипидемија спада у дислипидемије и означава пораст холестерола и/или триглицерида са ниским вредностима ХДЛ (high density lipoprotein) у плазми, што доприноси бржем настанку атеросклерозе. |
 |
Дијабетес је најчешћи узрок слепила код радно способне популације старости од 20-65 година. Слепило је 25 пута чешће код дијабетичара него код опште популације и његова инциднција је 50-65 на 100.000 популације дијабетичара годишње у Европи. Међутим, брижљивом негом, оштећење вида услед дијабетеса може се спречити код великог броја пацијената. |
 |
Хипертензија је повезана са бројним нежељеним догађајима. Вероватноћа да до њих дође зависи од висине крвног притиска и трајања хипертензије. Ризик расте са повећањем крвног притиска већ од вредности 110/75 mmHg, у свим добним групама. Пораст укупног кардиоваскуларног ризика повезаног са хипертензијом зависи и од присуства или одсуства других фактора ризика. |
| Светска здравствена организација (СЗО) је у циљу подизања свести целокупне светске јавности о значају и важности редовне физичке активности у очувању и унапређењу доброг здравља и благостања дана 10. маја 2002. године покренула глобалну иницијативу за обележавање међународног дана физичке активности.Тај дан је познат под слоганом „Кретањем до здравља“, а односи се на умерену физичку активност без обзира на садржаје, место и време извођења. Циљна група је целокупна популација уважавајући све различитости у смислу узраста, пола, верске, расне, социјалне, економске и етичке припадности. |
| Сваке године у мају обележава се Светски дан борбе против астме са циљем подизања свести o астми широм света. Светска здравствена организација препознаје да је астма од велике важности за јавно здравље. |
| Занимање старо колико и човечанство, и упркос свим напредовањима у медицини, улога бабице ће трајати вечно.Њен значај се мери према рађању новог бића и ојачавању структуре породица и заједнице. Оне представљају спону између лекара и пацијента и присуствују фази највећег бола и највеће радости. |
| Током празника није био повећан број пацијента који су због болести били прегледани у Специјалистичком центру Опште болнице Панчево. Највише посла било је за ортопеде, најчешће због повреда у природи у којој је већина боравила током мајских празника. |
 |
Мениереова болест или хидропс лабиринта је болест унутрашњег ува и карактерише се нападима вртоглавице, шумом у ушима и ослабљеним слухом, а настаје због поремећаја микроциркулације у лабиринту ува. Наглувост је промењива, али с временом напредује. |
 |
Међу псеудотуморима ларинкса најбројнији су полипи. Под полипима се подразумевају псеудотумори непознате етиологије у чијој је основи присутна пролиферација измењеног епитела уз промене у субепителном слоју изазване запаљенским процесима. |
 |
Трећи крајник је лимфно ткиво смештено у средини задњег зида носног ждрела. Аденоиди су присутни при рођењу и од тада се повећавају, расту до 5-7. године и дају симптоме хркања, зачепљености носа и тешкоће с дисањем. |
 |
Крајници су лимфни чворови, који се налазе са обе стране ждрела и имају улогу у имуном систему организма. Акутна упала крајника није ретка појава, нешто чешће се јавља у дечијем узрасту него код одраслих. |
 |
Акутни фарингитис (pharyngitis acuta) се ретко јављају изоловано, самостално, већ у склопу запаљенских обољења слузнице носа и синуса, усне шупљине и крајника, најчешће као пропратни симптоми код већине инфективних болести. |
 |
То је акутна или хронична инфекција најчешће дела коже спољашњег ува услед локалних или општих узрока. |
 |
Полиурија је симптом код многих обољења и означава излучивање мокраће у количини већој од 3 литра у 24 сата. |
 |
Хематурија представља присуство крви (еритроцита) у мокраћи. У односу на број еритроцита у урину постоје микро и макроеритроцитурија (макроскопска хематурија). |
 |
Мокраћна бешика се налази између пубичне кости и материце. Она представља кесу растегљивих зидова у којој се скупља мокраћа створена у бубрезима. Када се зидови бешике скупе мокраћа се потискује у уретру, која представља узану цев дугачку само 2.5 - 3цм. |
 |
Камен у бубрегу (Нефролитијаза) се дефинише као присуство камена у сабирним тубулима, у чашицама и карлици бубрега. Каменци су клинички значајни јер могу изазвати опструкцију нормалног протока мокраће, поспешити настанак уринарне инфекције, а могу изазвати и јак бол. |
| Европска недеља имунизације традиционално се сваке године обележава последње недеље априла. У исто време ове године се на глобалном нивоу обележава и Светска недеља вакцинације (24.-30.априла 2023). Ове године слоган недеље вакцинације гласи ,,Велика надокнада вакцинације“ (енг. The big catch up) и има за циљ да истакне потребу колективног деловања у сврху надокнаде пропуштених доза вакцинације и повећања заштите од болести које се могу спречити вакцинацијом. |
| 20.ог априла сваке године обележава се Међународни дан заштите од буке. Циљ обележавања је да се кроз различите активности ради на подизању свести о овом проблему. Процењује се да у Европској Унији, око 56 милиона људи (око 54%) живе у средини изложеној саобраћајној буци већој од дозвољене просечне вредности, која се сматра ризичном за здравље. |
| Међународна организација рада обележава овај дан организовањем кампања за подизање свести, која фокусира пажњу међународне јавности на проблеме у овој области и промоцију безбедности и здравља на раду. |
| Сваке године, 22-ог априла обележава се Међународни Дан планете Земље у циљу скретања пажње грађанима на значај очувања природе и спречавања негативних последица по животну средину. Данашњи дан се од 1970. године у целом свету обележава као Међународни Дан наше планете. Значај обележавања тог датума је упозорење на опасности које прете животу на Земљи, екосистемима и урбаним зонама, услед развоја индустрије, повећане потрошње енергије, глобалног загревања и климатских промена, како би светска популација постала свесна своје одговорности према планети на којој живимо и тако смањила негативан утицај на животну средину. |
| Највећи хришћански празник започињемо Великим петком. На овај свети дан, нека нас жртва Исуса Христа подстакне на живот са добротом према другима. Сетимо се жртве Исуса Христа и покушајмо живети живот пун љубави и опраштања. |
 |
Панчевачка болница у којој се лече пацијенти из Јужног Баната, од Порајинског секретаријата за здравство, добила је 54 милиона динара за обнављање опреме и куповину нових апарата који ће омогућити бољу дијагностику и квалитетније лечење. |
 |
Инфаркт је реч која потиче од латинскиг глагола „Infacere" што значи испунити, набити. У медицинском значењу, инфаркт је сложен и непредвидљив процес где услед зачепљења крвотока тромбом (крвним угрушком) у неком органу или делу органа долази до исхемије и пропадања ткива. |
| Највећи хришћански празник започињемо Великим петком, најтужнијим даном хришћанства. Овај дан посвећујемо Христовом страдању. |
 |
На Светски дан здравља, 7. априла 2023. године, Светска здравствена организација обележава 75. годишњицу од оснивања, под слоганом „Здравље за све“. Још 1948. године земље света су се удружиле и основале СЗО како би унапређивали здравље, очували свет безбедним и служили рањивим друштвеним групама тако да свако и свуда може да постигне највиши ниво здравља и благостања. |
| Светски дан особа са аутизмом обележава се свуда у свету 2. априла, како је одредила генерална скупштина Уједињених нација,како би истакла потребу да се помогне у побољшању квалитета живота особа са аутизмом, те како би они могли да воде пун и смислен живот као саставни део друштва.Неке нације, попут Уједињеног Краљевства, обележавају седмицу свести о аутизму која сваке године пада око Светског дана аутизма. Друге земље, попут САД током целог априла обележавају Светски месец посвећен људима са поремећајем на спектру аутизма. |
 |
Акутна дилатација желудца представља изненадно накупљање велике количине желудачног садржаја и гасова који се не ресорбују и не транспортују у ниже партије дигестивног тракта у одсуству органске опструкције желудца. |
 |
Алкохолни хепатитис је токсично запаљењско обољење јетре које се може испољити у акутном и хроничном клиничком облику. |
 |
Полицистична болест јетре је конгенитално обољење. Цисте јетре су удружене са цистама у бубрегу, а могуће су и у другим органима (плућа, панкреас, слезина, јајници). |
 |
Хемобилија је крварење у билијарни тракт као последица трауме или оперативних повреда јетре и жучних путева, са успостављањем патолошких комуникација крвних судова и жучних канала. |
 |
Апсцес јетре је ретко обољење најчешће узроковано гастроинтестиналним, а ређе системским инфекцијама. |
 |
Хемороиди су једно од најраспрострањенијих обољења. Према старистичким подацима од хемороида пати 12% становништва, а од свих болести дебелог црева они чине 40%. Подједнако се јављају и код жена и код мушкараца. У узрасту од 25 - 50 година их има највише. |
 |
У оквиру конкурса „Заједници заједно“ за 2022.годину, финансираног од стране НИС а.д. Нови Сад, Општој болници Панчево одобрена су средства у износу од 15.000.000,00 динара за опремање болнице новим ултразвучним и ЦТГ апаратом и порођајним столом, а у циљу проширења капацитета за процес вантелесне оплодње као и за квалитетнији порођајни процес. |
| Сваке године 24. марта обележава се кампања Светског дана борбе против туберкулозе са циљем да се скрене пажња да велики број људи и даље болује од туберкулозе и да запостављање континуираних напора за контролу ове болести може бити опасно. |
| Светски дан вода обележава се сваке године 22. марта и посвећен је фокусирању пажње на значај воде. Овај дан прославља воду као основни ресурс живота и подиже свест о томе да 2,2 милијарде људи у свету и даље нема доступну здравствено безбедну воду за пиће. Све активности се предузимају у циљу решавања глобалне кризе обезбеђивања довољне количине здравствено безбедне воде за пиће доступне свима. Основни фокус Светског дана воде је подршка постизању 6. глобалног циља одрживог развоја: „Вода и санитација за све до 2030. године“. |
| Да ли сте знали да Даунов синдром погађа отприлике 6.000 беба при рођењу сваке године? Дакле, 21. марта — датума изабраног да представља хромозомски дефект који се налази код Дауновог синдрома (двадесет први дан трећег месеца) — обележавамо Светски дан особа са Дауновим синдромом, догађај створен да подигне свест јавности, промовише инклузивност, подстакне залагање и подржавају добробит оних који живе са Дауновим синдромом. |
| Март је месец када се многобројним активностима обележава 20. март – Национални дан борбе против рака дојке. На тај начин се скреће пажња јавности на распострањеност болести и на подизање свести жена о значају превентивних прегледа у раном откривању болести. |
 |
Додатна обука кардиолога почела је у Општој болници Панчево, на једном од најсавременијих ултразвучних апарата за преглед срца који је недавно стигао у панчевачку болницу. Професорка Зорица Младеновић, долазиће у нашу болницу како би показа својим колегама да ураде и неке додане интервенције на овом апарату за које су до сада пацијенте слали у друге Клиничке центре. |
| Светски дан бубрега се обележава на иницијативу Међународног друштва за нефрологију (The International Society of Nephrology) и Интернационалног удружења Фондација за бубрег (International Federation of Kidney Foundations) у више од 100 земаља широм света. Слоган овогодишњег Светског дана бубрега „Здравље бубрега свима и свуда”, има за циљ подизање свести о високом и растућем оптерећењу болестима бубрега широм света, као и потребу за израдом стратегија за превенцију и контролу болести бубрега. |
| Кокаин је супстанца која је сама по себи природни анестетик, али исто тако и супстанца која изазива велику зависност. Кокаин се екстрахује из листова Erythroquilon coca, познатог као "кокина кора", биљке која расте у Андским висоравнима Јужне Америке.Кокаин је најмоћнији стимуланс природног порекла. Када је Coca-Cola први пут произведена, иницијална доза кокаина по чаши је била 9 милиграма. Године 1903. овај састојак је уклоњен, након што се спознао развој зависности од поменуте супстанце.Неколико година пре тога, тачније 1884., Карл Колер, аустријски офталмолог, први је употребио кокаин као анестетик током операције ока. Био је популаран и широко коришћен анестетик до почетка 20. века.Како је медицинска струка схватила да кокаин изазива зависност, развијени су сигурнији анестетици. Кокаин, у свом основном облику, више се не користи рутински.Међутим, кокаин и његов дериват, крек кокаин, широко се користе као илегалне рекреативне дрогe. |
| Метаболички синдром је скуп кардиоваскуларних фактора ризика, чија удруженост повећава ризик за кардиоваскуларно обољење и дијабетес тип 2. Препознаје се код једне од пет особа, а учесталост се повећава са годинама живота. |
| Процењује се да око 80 милиона људи широм света има глауком а 111,8 милиона људи има предиспозицију да добије глауком до 2040. године. У Србији је претпоставка да од ове болести болује око 100.000 људи јер не постоје прецизни подаци о оболелима јер глауком није болест која се обавезно пријављује. Око 50% особа са глаукомом није свесно да има болест, из разлога што већина пацијената са глаукомом нема симптоме јер је болест у својим раним фазама асимптоматска. Ако се не лечи, глауком може напредовати и довести до слепила. Уколико се болест открије на време велике су шансе да се сачува вид у годинама које долазе. |
 |
Није лако у једном дану и у једној честитки сажети сво поштовање према вашем раду, свакодневној посвећености другим људима, чији живот, некад и патњу чините лакшим . |
| Светски дан ретких болести (28. фебруар) установила је Европска организација за ретке болести 2008. године у циљу подизања свести о ретким болестима о проблемима и препрекама на које наилазе сви они који живе са ретким болестима, али и о могућностима да уз потребну здравствену и социјалну подршку живе квалитетним и садржајним животом. |
 |
Коксартроза представља артрозу кука. Артроза је дегенеративна промена зглобне хрскавице, која затим узрокује промене и на осталим деловима зглоба ( зглобна чаура, кост), а пре или после се карактерише болом и оштећеном функцијом зглоба. |
 |
Деформитет, познат као "равна стопала" карактерише спуштање свода и заузимање валгусног положаја при стајању. |
 |
Фибромиалгија припада групи обољења која се зову синдроми дифузног идиопатског мишићно - скелетног бола. |
 |
Микобактерије могу бити проузроковачи инфекције зглобова и костију. Захватање скелетне мускулатуре има спору клиничку еволуцију. Локалне инфламаторне промене неопажено, подмукло доводе до деструкције и могу спонатно да прелазе кроз фазе егзацербације и ремисије. Системски симптоми су често досутни. |
 |
Понекад након снажног директног утицаја масног ткива на колена може настати повреда (затегнутост) између задње бутне кости и колена. Ова повреда назива се Хофа синдром. |
| Акне су кожна болест која се најчешће први пут јавља у пубертету. У том периоду долази до пораста различитих хормона, па и хормона андрогена, који утичу на себацеалне жлезде. Себацеалне жлезде у кожи постоје и на рођењу, али почињу да фукционишу тек у пубертету када их повишене вредности андрогена стимулишу да стварају себум , једну масну супстанцу која облаже кожу и у нормалним условима има заштитну улогу. |
| Сандра Младеновић из Качарева никада неће заборавити свој други порођај. Девет дана пре термина на свет је донела прелепог дечака Андрију, тешког 3 килограма и 600 грама и дугачког 50 центиметара. Андрија је толико био нестрпљив да упозна родитеље, да их је изненадио на путу до болнице. |
 |
Дивертикулум желуца представља слепо, кесасто избочење од лумена пут споља, свих или поједних слојева зида желуца. |
| Мамографија је најстарија метода за визуализацију патолошких промена у дојци .1913. године немачки хирург Саломон је први приказао малигни тумор на рендгенском снимку хирушког препарата дојке доказавши тако да X-зраци могу да се користе за верификацију тумора у овом органу. |
 |
Под појмом хемоптизија подразумева се искашљавање крви из плућа и трахеобронхног стабла. |
 |
Излив течности у плеуру најчешћа је појава која прати обољења плеуре. То није посебна болест већ патофизиолошка промена која прати многа плеурна, плућна, медијастинумска и системска обољења. |
 |
Свирање у грудима може бити и симптом (када га чују друге особе) и знак (када се чује само стетоскопом). За овај симптом се често употребљава енглески термин "wheezing" (визинг). |
 |
Страна тела доњих ваздушних путева спадају у најургентнија стања у медицини јер могу за кратко време да доведу до смртног исхода услед угушења. |
 |
Хронични бронхитис карактерише хронично или понављано повећање секреције трахеобронхијалне слузи довољно да изазове кашаљ и искашљавање најмање три месеца годишње током две узастопне године, када се искључе други плућни и срчани узроци кашља и искашљавања. |
 |
Ризик од настанка СДМ се повец́ава са годинама. Резултати велике студије показују да људи у педесетим годинама имају 2% шансе да добију СДМ. Овај ризик расте на 30% након 75. године. Не знају се тачни узроци СДМ, али постоје неки фактори који доприносе настанку ове болести. На неке факторе се не може утицати, а на неке не. |
 |
Влажна сенилна дегенерација макуле (СДМ) према проценама захвата око 20 милиона људи широм света и водећи је узрок губитка вида међу особама у доби од 65 и више година. |
 |
Сенилна дегенерација макуле је болест средишњег дела ретине, која се обично јавља код старијих особа и која резултира губитком вида у средишту видног поља. Ова болест може отежати и онемогућити читање, писање, управљање возилом и препознавање лица, иако преостали периферни вид омогућава неке свакодневне активности . |
 |
Сенилна дегенерација макуле је један од основних узрока озбиљног губитка вида код људи старијих од 60 година. Више о томе прочитаћете кроз следеће тезе и текстове. |
 |
Примарни хипотиреоизам настаје у 90% случајева због аутоимуног тироидитиса, терапије хипертиреозе радиојодидом или оперативним уклањањем штитасте жлезде. |
 |
Након обилнијих оброка, повећане количине алкохола, хране богате високом енертском вредношћу, смањеног кретања, физичке активности током празника , организму је неопходан одмор, такозвано „чишћење“, било да сте добили на телесној маси или не. |
| Хипотермија је стање у којем је вредност ректалне температуре мања од 35 степена целзијуса. Најчешће настаје у хладном делу године код старијих, социјално угрожених болесника изложених хладноћи изван куће или у кући која није грејана. Често је реч о психички оболелим особама, дијабетичарима зависних од инсулина у хипогликемији, алкохоличарима, особама које злоупотребљавају лекове и дроге или болују од хипотиреозе. |
| Светска здравствена организација и Међународно удружење за борбу против рака већ традиционално обележавају Светски дан борбе против рака сваког 4. фебруара. Нова трогодишња кампања покренута је 2022. године, а са циљем да се јасно укаже на новонастале, актуелне и глобалне проблеме који оптерећују све учеснике у процесу превенције, дијагностике и лечења малигних болести. |
 |
Мукокеле су цистичне творевине, најчешће локализоване у фронталним и етмоидалним синусима, а врло ретко у сфеноидалном и максиларном синусу. |
 |
Реч температура потиче од грчке речи „termo“ (топлота) и латинске речи „foveo“ (топлота). Повишена телесна температура – фебрилност је облик одбрамбене реакције организма на вирусну или бактеријску инфекцију (што је у 90% случајева узрок повишења телесне температуре у деце). |
 |
Инфаркт је реч која потиче од латинскиг глагола „Infacere" што значи испунити, набити. У медицинском значењу, инфаркт је сложен и непредвидљив процес где услед зачепљења крвотока тромбом (крвним угрушком) у неком органу или делу органа долази до исхемије и пропадања ткива. |
 |
Обухвата групу различитих обољења и поремећаја чији је заједнички симптом бол у лумбалном или лумбосакралном делу кичменог стуба са иридијацијом у ноге или без ње. |
 |
Промуклост је симптом измењеног квалитета гласа. Органи који непосредно учествују у произвођењу гласа су плућа, гркљан, ждрело, усна дупља и нос, а као резултат добијамо глас одређене јачине, висине и боје. За правилан глас и говор неопходан је потпуни интегритет свих органа који учествују у њиховом формирању. |
| Под дуваном се подразумева више од 70 врста биљака из рода Nicotiana. Најкарактеристичнија супстанца у њиховом саставу је алкалоид никотин, мада је, поред њега, у саставу дувана доказано мноштво различитих супстанци и чак неколико хиљада оних које се ослобађају при сагоревању дувана. |
| Нормална слезина тежи око 150 грама, величине је 12цм x 7цм x 2цм и код одраслог здравог човека по правилу није палпабилна. Сваки налаз палпабилне слезине захтева додатне дијагностичке претраге да би се разјаснио узрок њеног увећања. |
 |
Да би микробиолошко испитивање било добро урађено потребно је да пацијенти знају како правилно да узму узорак и за које време да га донесу у лабораторију. Пацијенти сами могу да узму и донесу следеће узорке: урин, фецес, перианални отисак и спутум. |
 |
Срчана инсуфицијенција је клинички синдром који настаје због поремећаја структуре или функције срца што доводи до неадекватне перфузије ткива. Сматра се да око 2% светске популације болује од срчане слабости. |
 |
Хоане су отвори носних шупљина преко којих се одржава веза са спољном средином и горњим спратом ждрела. |
| Малигне болести се налазе на другом месту по броју изазваних смртних случајева, одмах после кардиоваскуларних болести. Настају као последица узајамног деловања генетских фактора, услова спољашње средине и лоших животних навика. |
| У ОБ Панчево се од недавно поново оперишу тумори дојке. Успостављена је сарадња са Прим. др Невеном Јокићем са Института за Онкологију и Радиологију Србије који у ОБ Панчево ради наведене операције уз помоћ младих лекара ОБ Панчево др Денија Петра Ардељана и др Александра Маричића. Такође, поново је почела са радом и амбуланта за дојку четвртком од 9 часова, амбуланта 3 специјалистичког центра ОБ Панчево. |
| Карцином грлића материце је опао у већини развијених земаља последњих година, али је и даље трећи у свету водећи узрок смрти од рака код жена. Прецизно постављање дијагнозе је на основу клиничког прегледа , МРИ карлице и абдомена, затим ПЕТ ЦТ , као и узорковање лимфних чворова. На основу тога можемо се определити за терапијску стратегију. |
| Миотонична дистрофија је аутосомно доминантно прогресивно мултисистемско обољење које се карактерише мишићном слабошћу и миотонијом, а најчешће почиње у адултном добу. Много драматичније болест се испољава у неонаталном периоду с обзиром на то да мишићна слабост може да буде тако тешка да доводи до респираторне инсуфицијенције и смрти новорођенчета. Конгенитална форма (ДМ1) разликуее се од адултне форме обољења (ДМ2), не само у погледу фенотипског испољавања већ и по месту генских локуса. |
| Коронарна јединица је јединица интензивне неге, намењена пружању стручне неге болесницима са кардиоваскуларним болестима које захтевају стално праћење. Особље је детаљно упознато са лечењем акутног коронарног синдрома, аритмија, срчане инсуфицијенције, механичком циркулаторном потпором, и комплексним инвазивним и неинвазивним мониторингом, као и са респираторном потпором. Коронарна јединица збрињава болеснике са озбиљним бубрежним и плућним болестима. |
| Неке механичке компликације могу се догодити у првим данима након акутног инфаркта, иако је њихова учесталост смањена услед пораста броја брзе и ефективне реперфузионе терапије. Све су животно угрожавајуће и захтевају брзу детекцију и лечење. |
 |
Деформитет, познат као „равна стопала" карактерише спуштање свода и заузимање валгусног положаја при стајању. |
 |
Перартритис је заједнички назив за све промене које се одигравају на структурама око зглобова и односи се на обољења зглобне капсуле, бурзи, мишићних тетива, њихових омотача, мишићних и лигаментарних припоја за кости и фасција. |
 |
Сјогренов синдром је хронично, запаљенско, реуматоидно обољење које се испољава сувим оком и сувим устима. Узрок настанка ових појава је смањење функција егзокриних жлезда. Овај синдром се јавља као примарно обољење и удружен са неком од других сиситемских болести везивног ткива, најчешће са системским лупусом или реуматоидним артритисом. |
 |
Дегенеративне промене зглобне хрскавице, које затим узрокују промене и на осталим деловима зглоба (зглобна чаура, кост), а пре или после се карактеришу болом и оштећеном функцијом зглоба, називају се артроза, остеоартроза или остеоартритис. |
 |
Активни имунитет може се стећи након прележане болести или вакцинацијом. Вакцине стимулишу стварање антитела или делују на остале компоненте имуног система. |
| Пред нама је још један празник, јулијанска Нова година, код нас познатија као Српска Нова година. Уживајте уз најмилије, слушајте и гледајте једни у друге, праштајте и наравно, волите се. Јер без љубави све остало губи смисао. |
 |
У току претходне ноћи, након акцидента са цурењем амонијака, на Одељење за пријем и збрињавање ургентних стања Опште болнице Панчево довежено је осам лица. |
| Пнеумоторакс је присуство ваздуха у плеуралном простору, обично са већим или мањим колапсом плућа. Код пнеумоторакса ваздух се акумулира у плеури. Количина ваздуха заробљена у плеуралном простору одређује степен колапса плућа. |
| 2020. године регистрован је први случај КОВИД-19 инфекције у Србији. Ова, до тада потпуно непозната инфективна болест, примарно је дефинисана као респираторна. РТГ дијагностика је показивала плућа као „млечно стакло“, те су пулмолози важан део медицинског тима у лечењу ове инфекције. |
| Дочекујемо свети, најрадоснији и најсвечанији празник у нашој религији, празник рођења Исуса Христа! Дан у коме се требамо волети, поштовати и опраштати, да би нам и самима било опроштено. Дан, када све недаће нестају а срца нам се испуне вером у Бога. Посветимо пажњу и љубав својим најближима, али и свим људима око себе. У својим срцима имајмо благостање и мир. |
 |
Градоначелник Панчева, Александар Стевановић, уручио је златник мајци прворођене бебе у 2023. години, Бојани Чижик из Ковачице. |
 |
Пре свега, за годину која пролази преузећу одговорност да својим колегама изразим захвалност и дивљење за све напоре, сво пожртвовање и борбу за здравље хиљаде пацијената који су прошли кроз нашу болницу. |
 |
Депресија (лат.depressio = спуштање, опадање, снижавање) је поремећај расположења који се карактерише присуством изузетне туге, разочарења, усамљености, безнађа, недостатак вере у себе и осећај кривице и ниже вредности. Овакво стање је врло озбиљно и може трајати веома дуго, реметећи јединку у обављању свакодневних активности. |
 |
Ваш адолесцент се чудно понаша у последње време, избегава разговор са вама, одбија да једе, често се затвара у своју собу... Забринути сте и у недоумици да ли је у питању проблем за који не знате, депресија или једноставно нормални симптоми адолесценције. |
 |
Постпорођајна депресија (постпартална депресија) је ментални поремећај који се јавља са преваленцом између 5% и 60.8% у свету. Ово је стање које се јавља након порођаја, а као одговор на новонастале животне промене које доноси рођење (новог) детета. |
 |
На почетку лечења на првом месту се налази тзв. пратећа психотерапија, дакле охрабрујући, добронамеран разговор који пружа објашњењ и уверавање да постоји наклоност и разумевање. Могу се применити одређени психотерапеутски поступци ако су депресију изазвали реални, тешки животни догађаји, као што су губитак посла, развод или губитак блиске особе. |
 |
Под парасомнијама се подразумевају поремећаји спавања које одликују различити облици краткотрајних нежељених активности са непредвидивим обрасцем појављивања у току спавања, или у прелазима између спавања и будности. |
 |
Иако живимо у ери неуронауке, у којој помоћу специјалних апарата за скенирање долазимо до значајних података о раду и структури људског мозга, код нас је психичка болест још увек табу тема и нешто што значи срам и обележеност. Последица таквог става је, наравно, погубна за све оне који имају психичке тегобе, обзиром да се касно или уопште не јаве лекару психијатру, те њихова болест прогредира, односно, компликује се и усложњава. |
| Царски рез је хируршки захват који подразумева прављење реза на трбуху и материци кроз који се остварује рађање бебе. Може бити планиран и хитан. |
| Бадњи дан је прави породични празник и проводи се у кругу породице у миру и слози. Славимо наду у свет доброте и разумевања међу људима. Праштајмо, волимо и чинимо добро другим људима. |
 |
Бенигни тумори колона и ректума су епителни, неепителни и лезије сличне тумору. Заузимају важно место у обољењима дебелог црева, с обзиром на њихово често откривање и однос према колоректалним карциномима. |
 |
Неуралгија тригеминуса представља повремене нападе оштрих болова у лицу у пределу једне од грана овог живца. |
 |
Дисфагија представља поремећај гутања који се карактерише као осећај заостајања залогаја хране у грлу или грудима. |
 |
Мултипла склероза (МС) је хронично обољење централног нервног система која се карактерише процесом демијелинизације кичмене мождине и мозга. Ово значи да Мултипла склероза спада под демијелинизирајуће болести код којих је мијелински омотач неурона оштећен. Процес демијенилизације подразумева гобитак беле супстанце, мијелина која је саставни део нервног ткива. |
 |
Данас још не постоје лекови којима се мултипла склероза МС може излечити, али постоје лекови којима се може значајно успорити или чак зауставити напредовање болести, број релапса и појава нових оштећења (лезија) у нервном систему. |
| Дијабетес се данас убраја међу најчешћа обољења са преваленцом у сталном порасту.То је хронична болест од које обољевају особе свих животних доби,независно од пола. Дијабетес дуго не испољава своје симптоме,а пре њихове појаве, најчешће само рутинском контролом нивоа шећера у крви,откривамо болест. Имамо ране симптоме, узнапредовале и симптоме који подстичу да се потражи стручна помоћ. |
| Плућна хипертензија представља поремећај који се јавља у различитим синдромима, стањима и болестима, а у основи лежи повишен притисак у плућној циркулацији. Уколико дође до пораста притиска у плућним крвним судовима, то ће се неминовно одразити на срце, посебно на десну комору, која ће почети интензивније да ради како би савладала новонастали отпор у крвним судовима плућа. Индиректно, последице трпи срце у целини, као читав организам јер се временом развија хипоксија, односно стање смањене концентрације кисеоника у крви. |
| Према Светској здравственој организацији маститис је запаљење ткива млечне жлезде дојке које може и не мора бити повезано са бактеријском инфекцијом. |
 |
Деркумова болест је ретко обољење у склопу којег постоје мултипли масни депозити који су најчешће смештени у кожи. Ови депозити могу вршити компресију на нерве и изазвати слабост и бол. Уколико се налазае у регији врата могу вршити притисак на велике крвне судове и трахеју. |
| Напрасна смрт представља изненадни и неочекивани престанак функције кардиоваскуларног и респираторног система и то најчешће у особа, у којих раније није било никаквих симптома, или откривених знакова болести. Она се најчешће дешава ван медицинских установа: у кући, на улици, у превозном средству, кревету, на радном месту,у спорту и слично. Узрок смрти је најчешће, у почетку нејасан те је потребна клиничка или судска обдукција зависно од околности под којим је настала. |
| Исхрана битно утиче на многе од променљивих фактора ризика за кардиоваскуларне болести (КВБ), тако да Светска здравствена организација (СЗО) и друге међународне и националне организације улажу велике напоре како би промовисале пожељан начин исхране и стил живота код што већег броја људи и тиме смањиле оптерећење здравствених служби. Препоруке за правилну исхрану (смернице, водичи) непрестано се мењају и усклађују са најновијим научним сазнањима. |
 |
Општа болница Панчево наставља са занављањем опреме за нашу установу. Овог пута стигли су нови апарати за патологију Опште болнице Панчево. Миктотоми, апарат за Ex-tempore дијагностику и конзола за калупљење су реализовани уз помоћ менаџмента Опште болнице Панчево а водено купатило је донација фирме "Lab-Teh" Београд. |
| Међународни дан људских права обележава се свида у свету 10. децембра и то од 1950. године, на дан када је две године раније потписама Универзална декларација о људским правима, којом је први пут у историји човечанства признато право свих људи на ,,живот, слободу и сигурност без икаквих разлика''. Овим документом је истакнуто да су људска права универзална и да не зависе од националне, идеолошке, социјалне и културне припадности. |
 |
Директорка УСАИД бироа за Европу и Евроазију, Erin McKee, посетилa je Општу болницу у Панчеву и обишлa реновирану подстаницу у болници. Србија и Америчка Агенција за међународни развој (УСАИД) припремају стратешке споразуме о енергетици који ће створити услове за више улагања. |
 |
Од свог оснивања 1945. године, Уједињене нације (УН) истичу своју посвећеност и позивају на стварање инклузивних, приступачних и одрживих друштава и заједница - нарочито усвајањем Универзалне декларације о људским правима 1948. године. Током времена , УН су свој фокус усредсредиле на промовисање добробити за људе који живе са инвалидитетом, а 1992. године затражиле су да се 3. децембра сваке године обележи Међународни дан особа са инвалидитетом. |
 |
Два нова рендген апарата, апарат за УЗ, као и скенер су током ове године стигли у Општу болницу Панчево. За савремене РТГ апарате новац је издвојио Покрајински секретеријат за здравство. Апарат је већ у функцији а пацијенти се снимају на новом РТГ апарату. |
| Светски дан борбе против ХИВ – а / АИДС – а обележава се 1. децембра сваке године са циљем да се људи широм света уједине у борби против ХИВ -а као и да се покаже подршка људима који са ХИВ – ом живе. |
| Занимљива је појава изненадних срчаних смрти у спорту јер је опште прихваћено да су спортисти физички способни и здрави људи, а физичка активност корисна по здравље. |
| Тампонада срца је животно угожавајуће стање које је праћено великим морталитетом уколико се не третира брзо и адекватно. Садржај у перикарду може бити течност, крв, гној, коагулум или гас. |
 |
Параназални синуси су шупљине у костима лица и базе лобање које су обложене репираторном слузокожом која ствара секрет (слуз). |
 |
Акутни отитис представља акутни запаљенски процес у средњем уву који настаје у току инфекције горњих дисајних путева (ринитис, синузитис, тонзилофарингитис). Значај запаљења средњег ува је у његовој високој инциденци у општој популацији и потенцијално опасним компликацијама, нарошито ендокранијалним. |
 |
Око 10% одраслих особа има неки облик зујања у ушима (пулсирање, пиштање, шиштање, цврчање, жубор воде, фијукање, итд.). Прогноза зујања зависи од узрока и врсте. |
 |
Ларингитиси су запаљења гркљана, обично се јављају у склопу запаљенских процеса дисајних путева а ређе изоловано. |
 |
Током ноћи на одељњу Ухо, грло и нос збрињавају се хитни случајеви, није ретко да у саобраћајним незгодама буду повређени глава, нос или вилица, такође гутање предмета и рибљих костију није реткост. На сву срећу, ипак су то ређи случајеви, сваке ноћи чести су доласци због капљичних инфекција и упале средњег уха. |
| Месец новембар је према Међународном и Националном календару здравља посвећен борби против болести зависности, са циљем подизања свести становништва о штетним ефектима дрога и мобилисања целокупног друштва за укључивање у активности на сузбијању њиховог коришћења. |
| Кератоакантом је бенигни тумор коже, који потиче од пилосебацеалне јединице, кожне структуре коју чине фоликул длаке и себацеална жлезда. Његова одлика је да у почетној фази има убрзан раст и да може спонтано да прође. |
| Корну кутанеум или у преводу кожни рог је промена на кожи која има потенцијал да се развије у малигну промену. У питању је израслина на која има склоност да више расте у висину у односу на величину базе из које креће да расте. |
 |
Тетанус је тешка акутна инфективна и неконтагиозна болест коју карактеришу тонични и клонични грчеви мускулатуре, тешки електролитни и метаболички поремећаји, аутономна дисфункција и често респираторна дисфункција. |
 |
Конгенитални сифилис је последица интраутерине инфекције. Трудноћа мајке делује супресивно на клиничке симптоме раног сифилиса. За разлику од мајке, болест фетуса је тешка, а исход дубиозан. |
 |
Муцање је један од највећих проблема у фонијатријској рехабилитацији. Обично настаје после 3. године, при поласку у школу или ређе у пубертету. Много се чешће јавља у мушке деце. |
 |
Међународни дан детета установљен је 1954. године када је Генерална скупштина Уједињених нација усвојила резолуцију 836 истоименог назива. Генерална скупштина је овим документом позвала државе чланице да установе Светски дан детета који би се обележавао као дан „братсва и разумевања међу децом широм света“ и који би био посвећен активностима за унапређење благостања деце. |
 |
Акромегалија је подмукла, хронична и потенцијално смртоносна болест настала због трајне хиперсекреције хормона раста, најчешће због аденома хипофизе. Најчешће настаје у добу између 30 и 50 година, са подједнаком учесталошћу код оба пола. У већини случајева јавља се спорадично, изузетно ретко виђа се породично. Инциденца акромегалије је мала, свега 5 до 6 случајева на 100000 становника. |
 |
Дана 14. новембра 2022.године обележена је лекарска слава св. Козма и Дамјан -Врачеви, сечењем колача уз присуство свештенства СПЦ, менаџмента Опште болнице Панчево на челу са др Слободаном Овуком, Дома здравља Панчево и Завода за јавно здравље Панчево кумова славе и многобројних здравствених радника. |
| Међународни дан борбе против Хроничне опструктивне болести плућа (ХОБП) обележава се 15. новембра у преко 50 земаља света, а организатор је Глобална иницијатива за хроничну опструктивну болест плућа (ГОЛД) у сарадњи са пулмолозима и пацијентима оболелим од ХОБП , те људима из јавног живота који својом активношћу на ову тему желе да помогну подизању свести унутар своје околине . Тема међународног дана борбе против ХОБП 2022. године је „Плућа за живот“ и сугерише на драгоценост плућног ткива које нам је дато рођењем , а које се приликом оштећења не може регенерисати и „поправити“, због чега апелује на одговорност свих нас при одабиру изложености различитим штетним ноксама, пре свега дуванском диму. |
 |
Светски Дан борбе против дијабетеса (WDD) се обележава сваке године 14. новембра, на рођендан сер Фредерика Бентинга, који је 1922. заједно са Чарлсом Бестом открио инсулин. Представља највећу светску кампању усмерену на подизање свести о дијабетесу. |
 |
Вирусни артритиси су бенигни инфекцијски аpтритиси који могу бити изазвани различитим виpусима: рубеле, хепатитиса Б, арбовирусима, вирусом мумпса, инфективне мононуклеозе, варичеле, аденовирусима и другим. |
 |
У току системских микоза ретко се може јавити инфекција зглобова акутног (пролазни артритис) и хроничног тока (деструктивни артритис). Микотични артритис се обично јавља код болесника са смањеном одбрамбеном способношћу, а инфекција настаје најчешће удисањем, а реде инокулацијом, хематогеним или неким другим путем. |
 |
Мучнина (nausea) представља стање праћено непријатношћу у горњем делу трбуха, у пределу желуца, праћено грчевима, гађењем, знојењем, осећајем тежине и потребом за повраћањем. |
 |
Урасли нокат настаје када се ивица нокта савија на тај начин да ураста у суседно ткиво испод коже палца. Може настати само са једне стране или са обе стране нокта у зависности од степена оштећења нокта. |
 |
Скидање конаца након операције се врши код такозваних нересорптивних конаца, односно конаца који не могу сами од себе. Код појединих стања, нпр. шивења слузокоже, ишивања рана код деце, шивења гениталне регије, долази у обзир да се пласирају такозвани нересорптивни конци, односно конци које се сами од себе отапају, односно распадају. |
 |
Вегенерова грануломатоза је мултисистемска болест непознате етиологије са некрозом, настајањем гранулома и васкулитиса у горњем и доњем делу респираторног система, гломерулонефритисом и варијабилним степеном захватања малих и некада крвних судова средње величине.Названа јепо Dr Friedrich Wegener који је описао болест 1936.године. Сматра се да у настајању болести улогу имају ауотоимуни механизми. |
 |
Плеурални излив настаје прекомерним накупљањем течности у плеуралном простору, а као последица повећаног стварања или смањеног преузимања течности. У физиолошким условима у плеуралном простору се налази мала количина течности. |
 |
Чињеница је да су болести срца и крвних судова водећи узрок смртности у свету. Сваке године у свету премине неколико милиона људи од последица кардиоваскуларних болести, процењује се да ће до 2030. године тај број порасти на 23 милиона. Који су фактори ризика за КВБ и како можемо да утичемо на здравље нашег срца? |
| Псоријаза је хронична дерматоза са преваленцијом од 1-3% у општој популацији. Обољење се карактерише периодима ремисије и егзарцербације, чији су настанак и трајање непредвидиви. |
 |
Митрална инсуфицијенција је срчана мана настала неадекватним затварањем митралног отвора путем митралних кусписа, због чега у систоли долази до враћања – регургитације крви у леву преткомору. |
 |
Флатер преткомора ( лепршање преткомора) настаје услед ненормалног аутоматизма преткомора који доводе до феномена кружења и одржавања аритмије. Ради се о брзом раду преткомора, најчешће око 300 у минуту. |
 |
Дилатирана кардиомиопатија (проширено срце) се карактерише дилатацијом срчаних шупљина са оштећеном пумпном функцијом, што се клинички најчешће манифестује конгестивном срчаном инсуфицијенцијом. |
 |
Сви болови и сметње у пределу срца не потичу од обољења срца у правом смислу речи, то јест од неке срчане мане или слабости. У знатном броју случајева ови болови и сметње потичу од ненормалног стања вегетативног нервног система. |
 |
Синусна брадикардија означава успорење срчане фреквенције испод 60 удара у минуту. Спори ритам срца може бити физиолошки нормалан за неке пацијенте, док фреквенција < 60/мин може бити неадекватна за друге. |
 |
Општа болница Панчево једна је од ретких у Србији у коју је стигао овакав кардиолошки ултразвук aпарат најновије генерације. Oн ће унапредити постојећу дијагностику и омогућити да се открију поједине кардиолошке болести које се ултразвучним апаратима старије генерације нису били видљиви |
| 25. новембра проглашен је Међународним даном борбе против насиља над женама на првом састанку феминисткиња Латинске Америке и Кариба (Феминист Енцуентро) одржаном у Боготи 1981.г. На састанку су жене говориле о породичном насиљу, силовањима и сексуалном злостављању, те насиљу које жене трпе под режимима, укључујући тортуру и насиље над политичким затвореницама. 25. новембар је одабран као дан сећања на сестре Мирабел (Патриу, Минерву и Мариу Тересу) које је брутално убио диктатор Рафаел Трујилло у Доминиканској републици 1960. Године 1999. Уједињене нације су резолуцијом 54/134 службене нове борбе као потврђене 25. против насиља над женама. |
 |
Гинекомастија је једнострано или обострано повећање дојки мушкарца, обично се јавља током неонаталног периода и присутна је код око 70% дечака у пубертету. Регресија настаје за 1 - 2 године. |
 |
Тестиси се састоје од герминативних ћелија (стварају сперму) и Леyдигових ћелија (стварају хормон тестостерон). Атрофија може да настане на једном или на оба тестиса. |
 |
Семеници (тестиси) су честа локализација мумпс инфекције. Јавља се код младића у пубертету или одраслих од 3 - 10 дана од почетка болести. |
 |
Пријапизам је изненадна, непровоцирана, нежељена болна ерекција која траје дуже од неколико сати. Разлог ерекције је пуњење кавернозних тела (исто као и у нормалној ерекцији), али постоји препрека у протоку крви у венском систему или промене на артеријама, па не долази до пражњења кавернозних тела. То је акутно обољење које захтева хитну уролошку интервенцију. |
 |
Период смањења репродуктивне функције женског организма назива се менопаузом. То је природан процес, окончава се уласком у климакс, тј. потпуним престанком менструалних крварења. У основи ове појаве је смањени ниво естрогена, што је последица слабијег одговора јајника на стимулацију посредовану хормонима ФСХ и ЛХ. |
 |
Oстеопороза је системски скелетни поремећај који карактеришу смањена коштана густина, губитак коштане масе и повећан ризик за прелом кости. |
 |
16. октобар се обележава као Светски дан хране, у складу са тим месец октобар је проглашен за месец правилне исхране. Овај дан се обележава са циљем подизања свести, информација и знања у корсит глобалне борбе против глади. |
| Међународни дан борбе против сиромаштва обележава се од 1987. године. Почетак ове званичне борбе смештен је у Паризу, где је том приликом ( 1987.) представљен јавности споменик посвећен борби против сиромаштва. Данас, овај датум се обележава у целом свету. Циљ обележавања јесте ширење свести о потреби искорењивања сиромаштва, нарочито у земљама у развоју. Вулнерабилне групе су: многочлане породице, деца до 14 година и старији (особито у руралним подручјима), самохрани родитељи, незапослени и особе са инвалидитетом, као и породице у којима они живе. |
| Хепаторенални синдром је синдром инсуфицијенције бубрежне функције код болесника са узнапредовалом болешћу јетре и портном хипертензијом. |
| Светски дан чистих руку обележава се 15. октобра, а главни циљ обележавања овог датума је развој културе прања руку сапуном, како на глобалном тако и на локалном нивоу, јер мали број људи пере редовно руке у критичним моментима. |
 |
У Операциони блок Опште болнице Панчево стигли су нови хируршки инструменти, а целокупна набавка је финансирана од стране Покрајинског секретаријата за здравство. |
 |
Пилонидални синус (coccygeal sinus) је постинфламациона шупљина обложена епителом локализована у кокцигеалном пределу. Пилонидални синус (урасла длака), синус пилонидалис или пилонидална болест најчешће називан и урасла длака, представља хроничну инфекцију у пределу бразде између глутеуса тј. у пределу тртичне кости. |
 |
Болести штитне жлезде су међу најчешћим обољењима данашњице. Процењује се да око 35% светске популације има неку врсту промена на штитној жлезди. Јавља се чешће у женској популацији. |
 |
Дијабетесно стопало је једна од бројних компликација шећерне болести и представља оштећење коже, меких ткива и коштано-зглобног система стопала. Карактерише се симптомима у виду улцерација, односно рана коже уз оток стопала, црвенило коже стопала, као и осећај трњења, печења или жарења. |
 |
Псоријаза је хронично, аутоимуно обољење коже. Одликује се рецидивирајућим током. Поред генетске предиспозиције, битан фактор за њено испољавање представљају УВ зраци ( рецидивира зими, уводи се у ремисију лети) али и појава инфекције, нпр. горњих дисајних путева, која често представља окидач за даљу неконтролисану активацију имуног система. |
 |
Поремећај крвних судова и себацеалних жлезда лица назива се розацеом. Одликује је присуство кожних промена: еритема, телангиектазија , налета црвенила (flushing) и промена еруптивног изгледа које подсећају на акне. |
 |
Светски дан вида обележава се сваке године 14. октобра како би се подигла свест о превенцији оштећења вида. Према подацима Светске здравствене организације, у свету је око 39 милиона људи слепо. Сматра се да је чак око 70% болести који доводе до губитка вида могуће превенирати. |
| Светски дан менталног здравља обележава се 10. октобра и како разумевање менталног здравља све више бива популаризовано у медијима и популарној култури, растемо заједно са њим. |
 |
Служба поливалентне патронаже, Служба за здравствену заштиту жена, Служба за здравствену заштиту деце Дома здравља Панчево, у сарадњи са Општом болницом Панчево и Заводом за јавно здравље Панчево су у Народној башти обележили Националну недељу дојења. |
| Потпредседница Владе Зорана Михаловић и Амерчки амбасадор Кристофер Хил посетили Општу болницу у Панчеву и обишли реновирану подстаницу у болници. |
| Међународни дан старијих особа се у свету и код нас обележава 1. октобра, у складу са Резолуцијом 45/106 коју је прогласила Генерална скупштина Уједињених нација 14. децембра 1990. године, а са циљем да нагласи важност прилагођавања животног окружења потребама и способностима становника трећег доба. |
 |
Хипоспадија је конгенитална аномалија предње уретре, која је непотпуно развијена и има отвор постериорно од нормалног места отварања. Представља једну од најчешћих аномалија. |
| Вирус беснила обично погађа животиње, али се може пренети на људе уједом или када бесна животиња лиже човекову озлеђену кожу. Пошто доспе у рану, вирус се може кретати нервима до мозга и изазвати потенцијално смртоносно запаљење. |
 |
Тумор може да открије сам пацијент или лекар као солитарни (појединачни цвор) на врату у пределу штитне жлезде. Он може да расте постепено али и нагло, може бити болан и може давати тегобе попут отежаног гутања или дисања. |
 |
Гихт настаје услед поремећаја елиминације мокраћне киселине (acidum uricum), која је дериват пурина (налази се у храни животињског порекла, печуркама и појединим биљкама) |
 |
Скидање конаца након операције се врши код такозваних нересорптивних конаца, односно конаца који не могу сами од себе. Код појединих стања, нпр. шивења слузокоже, ишивања рана код деце, шивења гениталне регије, долази у обзир да се пласирају такозвани нересорптивни конци, односно конци које се сами од себе отапају, односно распадају. |
 |
Менструацију не можете да добијете док ваше тело не схвати да више нисте у другом стању – а да би се то догодило, сав hCG мора да изађе из вашег организма. |
 |
Жучна кеса је део билијарног система који обухвата јетру и панкреас. Локализована је на доњој страни јетре. У жучној кеси се складишти и концентрише жуч пре него што се отпусти у танко црево. Најчешћи случај болести жучне кесе јесте холелитијаза (стварање камена у жучи), холециститис и холангитис (упала жучне кесе и упала жучних путева), тумори жучне кесе (полипи) и пресавијена жучна кеса. |
 |
Светски дан контрацепције се обележава сваке године, 26. септембра, почевши од 2007. године. Кампања је покренута на глобалном нивоу, са циљем да се истакне важност употребе различитих метода контрацепције и одговорног сексуалног понашања. Уз то, неопходно је младима омогућити што адекватнији приступ информацијама о сексуалном и репродуктивном здрављу.Планирање породице као тематски неодвојив део кампање, изузетно је важно питање јавног здравља и са индивидуалног и са ширег друштвеног аспекта. |
| Светски дан борбе против Алцхајмерове болести обележава се 21. септембра сваке године, када научна и стручна јавност, оболели и њихови ближњи апелују на друштвену заједницу да се уједини у борби против ове болести. У 2022. години кампања ће имати фокус у подршци након постављања дијагнозе. Циљ је да се истакне важност подршке особама која живе са деменцијом, као и њиховим породицама након постављања дијагнозе ове болести. |
 |
Мучнина (наусеа) представља стање праћено непријатношћу у горњем делу трбуха, у пределу желуца, праћено грчевима, гађењем, знојењем, осећајем тежине и потребом за повраћањем. |
 |
Пре увођења ефикасних лекова смртност од нелечене туберкулозе је била и до 50%. Данас се туберкулоза може успешно лечити. |
 |
У свакодневној педијатријској пракси опстипација jе чест проблем. Она се дефинише ако дете има до две столице или мањи број стoлица недељно, односно ако је столица веома тврда и „петрификована" барем током две узастопне недеље. |
 |
Алергијске реакције означавају имуни одговор организма на неку материју из спољашње средине, која обично није штетна по здравље човека.Већина алергија није опасно по живот, симптоми су благи и пролазе од неколико сати до неколико дана, али када се развије системска алергијска реакција (анафилактички шок), може доћи и до смртног исхода. Савет је да обавезно одете на преглед код алерголога. |
| Енуреза је један од најчешћих проблема дечјег доба и представља неконтролисано умокравање у узрасту када би требало да је успостављена комплетна вољна контрола мокрења, а то је узраст до 5 година. Најчешћа је у седмој години живота и износи 6,1-24.1%. Она може да буед примарна и секундардна, ноћна и дневна. |
| Сјогренов синдром је хронична аутоимуна болест егзокриних жлезда (најчешће пљувачне и сузне жлезде) и унутрашњих органа. Најчешће се јавља између 30. и 50. године живота. Чешће се јавља код жена, а ризик од оболевања од нон-Хочкиновог лимфома је код особа са овим синдромом 40 пута већи него у остатку популације. |
 |
Израз „прва помоћ“ односи се на помоћ која се пружа свакоме ко претрпи изненадну повреду или болест. Главни циљеви пружања прве помоћи су очување живота и пречавање погоршања стања. Не пружа је увек медицинско особље. У хитним ситуацијама, обични људи често морају да пруже прву помоћ како би спасили нечији живот. Прва помоћ не захтева нужно предзнање и може укључивати импровизацију. |
 |
Депресија (лат.„depressio" = спуштање, опадање, снижавање) је поремећај расположења који се карактерише присуством изузетне туге, разочарења, усамљености, безнађа, недостатак вере у себе и осећај кривице и ниже вредности. |
 |
Биполарни поремаћај се карактерише променама расположења, од дубоке депресије до екстремне еуфорије. Оне се понекад брзо смјењују, а понекад поједина фаза траје данима. Известан број особа с овим поремећајем осећа само депресију, са тек повременом тзв. маничном фазом. |
 |
Прецизан узрок ове врсте поремећаја још увек није тачно утврђен, али се претпоставља да и биолошки и психолошки фактори играју улогу у развоју синдрома. Занемаривање у детињству, недостатак пажње, деструктивно понашање, недостатак самопоуздања или чести боравци у болници само су неки од фактора који утичу на развој синдрома. |
 |
ПТСП узрокују психолошки трауматични догађаји који представљају претећу смрт или озбиљну повреду саме особе или других. Догађаји који су повод зову се „стресори", а могу се доживети изоловано или у већим групама. |
 |
Најсавременији стуб који се користи прилком операција код ортопедских повреда недавно је стигао у Општу болницу Панчево. Примена овог стуба омогућава операције колена са минимално инвазивним методама. |
| Реч самоубиство или суицид води порекло од латинског sui, себе, и caedere, сећи, убити. У литератури реч suicidium први пут споминје сер Т. Браун у књизи ,,Religia medici“ 1642. године, а Дефонтн то чини 1737. године. Класично се дефинише као чин којим човек сам себи одузме живот. |
 |
У Општу болницу Панчево стигао је апарат за ауто трансфузију крви, који ће омогућити да се током операција крв пацијента уз помоћ овог апарата филтрира и поново му се враћа. |
 |
У панчевачкој болници почео са радом нов скенер, захваљући новцу који је oбезбедио Покрајински Секретаријат за здравство. Током прошле недеље док је трајала обука радиолога и техничара први пацијенти обавили су снимање на новом скенеру. Пацијенти којима је у претходна два месеца било заказано снимање биће позивани да се јаве у Радиолошку Службу Опште болнице. |
| Акутно плућно срце се јавља код нагло настале плућне хипертензије и оптерећења десне коморе (акутну инсуфицијенцију), а најчешће је последица масивне плућне емболије. |
| Астма је је мултифокални синдром који обухвата атопију, бронхијалну хиперреактивност и акутни и хронични имунолошки одговор под деловањем имуноглобулина Е (ИгE) или без деловања ИгЕ. Астма (од грчког:тешко дисати, дахтати) један је од најстаријих медицинских термина, први пут је записан у Хомеровој Илијади, а касније у радовима Хипократа, Аристотела и Галена. |
| Нелечена дубока венска тромбоза (ДВТ) повезана је са повећаним ризиком за плућну емболију, а погрешно дијагностикована ДВТ доводи до сувишне антикоагулационе терапије и тиме до повећаног ризика крварења. Тачна дијагностика и брза терапија ДВТ су важне за редукцију ризика од тромбоемболичких компликација. Д-димер је постао тест избора у хитној дијагностици пацијената са сумњом на тромбозу дубоких вена и плућну емболију. |
| Болести вена најчешће се локализују на венама доњих екстремитета. Оне могу бити дубоке, површинске и комуникантне (чине комуникацију између дубоких и површинских вена). Нормално, крв из површинских вена празни се у дубоке било директно било кроз систем комуникантних вена. Патолошки процеси се најчешће се дешавају у венама доњих есктремитета, а у око 2% до 10% јављају се тромбоза, тромбофлебитис и посттромботски застој вена горњих екстремитета. |
 |
Болести штитне жлезде су међу најчешћим обољењима данашњице. Процењује се да око 35% светске популације има неку врсту промена на штитној жлезди. Јавља се чешће у женској популацији. |
 |
Сматра се да су притисци и сукоби унутар породице првобитни узрок булимије. Булимичар је обично особа која жели превише да постигне и тежи савршенству, а осећа да не може да задовољи очекивања својих родитеља. |
 |
Хашимотова болест је аутоимуно обољење где ћелије имуног система нападају и разарају ткиво штитасте жлезде (тиреоиде). |
 |
Најчешће је наследна. Симптоми нису изазвани психолошким или медицинским проблемима већ услед клинички значајног стреса или немогућности социјалног функционисања. |
 |
Клептоманија се не догађа из "сиромаштва", него се обично догађа код добростојећих људи, који немају задовољену потребу за узбуђењем на адекватан начин. Разлози за тај поремећај могу бити неодговарајући однос према родитељима, недостатак топлине у детињству покривеним материјалним, дететова чежња за некаквим похвалама од стране ауторитета, губитак поверења у себе, сексуално незадовољство. |
 |
Колоректални карцином спада међу најучесталије карциноме савременог човека. Инциденца тумора дебелог црева је висока у нашој земљи и приближава се стопама инциденце колоректалног карцинома у Европи и свету. |
 |
Халуцинације су врло честе код болесних од шизофреније, маније, пострауматских поремећаја, делиријума, деменције. Други узроци могу бити интоксикација или опијеност марихуаном, ЛСД-ом, кокаином, креком, хероином, алкохолом. Некада се халуцинације јављају и код тешких болести као што су инсуфицијенција бубрега и јетре и тумори мозга. |
| Захваљујући Министарству здравља Републике Србије и Покрајинској влади уз подршку Управе болнице, кардиологија ОБ Панчево је добила ултразвук срца последње генерације који је најсавременији, најмодернији и уједно припадник највише премијум класе ултразвучних апарата. |
 |
После петнаест година у Општу болницу Панчево стигао је нови скенер најсавременије технологије чија цена је око 5оо хиљада евра. Инсталација овог апарата је у току јер је пре почетка рада неопходно да стигне дозвола за рад од Агенција за заштиту од јонизујућих зрачења. |
 |
Ателектаза плућа представља стање код ког у одређеним деловим плућа не постоји ваздух, тј. плућа су издувана и колабирају. Ваздуха нема у алвеолама у којима се крв обогаћује кисеоником, а ослобађа угљен диоксида. Самим тим што у одређеним деловима плућа нема ваздуха, она су искључена из нормане функције дисање. |
 |
Бројни хуманитарни радници у свакодневној су опасности излажући своје животе како би помогли другима, било на ратом обухваћеним подручјима, градовима обухваћеним пандемијом, глађу, сиромаштвом… 19. августа 2003. године десио се бомбашки напад на зграду Уједињених нација у Багдаду, када је живот изгубило 22 хуманитарна радника. |
 |
Емпијем плеуре представља накупљање гноја у плеуралном простору. Узрокован је инфективним агенсима, а најчешћи узрочници су различити сојеви стафилокока потом анаеробни и грам негативни микроорганизми. Мешовите инфекције јављају се код 40 до 70% случајева. |
 |
Гојазност се дефинише као ексцесивно нагомилавање масног ткива у организму. У свету је преко 1,6 милијарди људи гојазно од којих је 400 милиона изразито гојазно. |
| Међународни дан младих је годишњи међународни догађај који се слави 12. августа. Први пут обележен 2000. године, дан има сврху да скрене пажњу на проблеме, културна и правна питања омладине, ученика, студената. Не треба га мешати са Светским даном омладине, који Католичка црква организује сваког јула различитог датума. |
 |
Мрена (катаракта, цатарацта) је замућење очног сочива које узрокује замагљење вида. Назив потиче од грчке речи „catarasso" која значи водопад, јер је одсјај ока попут беле воде у водопаду. |
 |
Аблација ретине (одлубљивање мрежњаче) је болест ока настала због раздвајања два слоја мрежњаче. Мрежњача има десет слојева и код овог поремећаја од првог слоја се одигне осталих девет. У простор између та два слоја се након одизања скупља течност. |
 |
Астигматизам је стање код ког се светлост не прелама подједнако на свим линијама ока. Реч астигматизам је грчког порекла и у буквалном преводу значи "без тачке". |
 |
Апсцес капака је ограничена гнојна колекција локализована у горњем или доњем очном капку. Апсцес може настати као пратећа појава повреде (чупање обрва код жена), уједа инсекта, ширења инфекције из параназалних синуса и метастатски. |
 |
Светска недеља дојења је глобална кампања која се обележава у око 170 земаља. Обухвата различите активности. Основни циљ је подизање друштвене свести о значају и предностима дојења. Кроз подршку дојењу, остварује се и унапређење и заштита здравља мајке и детета. |
 |
Одељење урологије је добило вредну опрему од новца Покрајнског секретеријата за здравство Војводине. Служба урологије је уназад 5 година значајно обновила опрему и уврстила у свој рад нове технике и технологије, што је подигло квалитет услуге ка пацијентима као и квалитет пружања услуга саме ОБ Панчево. |
| Последње две недеље забележен је пораст оболелих од ковида 19 у Србији и Јужнобанатском округу. Добра вест је да је већина пацијента са лакшом клиничком сликом и није потребно болничко лечење. |
| Топлотни удар је патолошко стање организма узроковано прегревањем тела, обично као резултат дужег излагања високој температури или последица физичке активности на високим температурама. |
| Синдром иритабилног колона или „нервозна црева“, како је у народу познато, је функционална болест гастроинтенстиналног система. Манифестује се болом у стомаку, поремећајем столице у разним комбинацијама, којима се не може наћи органски узрок, и дистензијом стомака. |
| Уверење да концентрација магнезијума може утицати на кардиоваскуларну стопу смртности, привлачи велику пажњу научника. Магнезијум је неопходан за многе кључне физиолошке функције, као што су срчани ритам, васкуларни тонус, нервна и мишићна функција. Магнезијум је такође потребан за формирање костију и може се назвати природним „антагонистом калцијума“. |
 |
Дијабетесно стопало је једна од бројних компликација шећерне болести и представља оштећење коже, меких ткива и коштано-зглобног система стопала. Карактерише се симптомима у виду улцерација, односно рана коже уз оток стопала, црвенило коже стопала, као и осећај трњења, печења или жарења. |
 |
Хипрефункција адреналног кортекса може бити АКТХ зависна и независна. Зависни тип настаје код хипофизне хиперпродукције АКТХ, код нехипофизних тумора који стварају АКТХ или код егзогеног уношења АКТХ. АКТХ-независна хиперфункција настаје код терапеутског давања кортикостероида или код адреналних аденома или карцинома. |
 |
Угануће скочног зглоба представља скуп повреда лигамената, капсуле, синовије и тетивних инсерција у пределу скочног зглоба при незгодном увртању или ређе извртању стопала у току посртања или пада. |
 |
Пејронијева болест представља појаву тврдих нодула у пенису који доводе до отежаних и болних ерекција. |
 |
Бол у грлу најчешће могу да проузрокују вируси или бактерије. Преносе се прљавим рукама, али и директним контактом, на пример пољупцем. Честа је код деце и младих људи, али се може појавити у било ком животном добу. Неки од вируса који изазивају грлобољу на слузокожи уста могу да проузрокују појаву афти - малих болних плихова. |
 |
Најчешће гастроинтестинално обољење у клиничкој пракси је синдром иритабилног колона или „нервозна црева". Манифестује се болом у трбуху и поремећајем столице, у разним комбинацијама, којима се не може наћи органски узрок. |
 |
Лето је време када се због високе температуре намернице брже кваре, а бактерије брже размножавају. Услед недовољног одржавања хигијене могу се јавити различити стомачни проблеми. |
 |
Светски дан борбе против хепатитиса обележава се 28. јула сваке године у циљу подизања свести о значају вирусних хепатитиса, упалних процеса јетре који узрокују тешка обољења и карцином јетре. |
 |
Колор доплер крвних судова врата или преглед каротидних и вертебралних артерија је један од најзначајнијих колор-доплер прегледа за велики број симптома, болести и стања. Може бити део евалуације васкуларних узрока како у домену васкуларне медицине (кардиологија, ангиологија, васкуларна хирургија), тако и код пацијената са примарном неуролошком, ОРЛ или офталмолошком симптоматологијом. |
 |
Пнеумоторакс се одликује присуством ваздуха у плеури, што доводи до делимичног или потпуног колапса плућа. Постоје три типа пнеумоторакса: затворени, отворени и тензиони (вентилни). |
 |
Бурзитиси су запаљења бурзи. Бурзе су затворене кесе обложене мембраном која је слична зглобној синовији. Омогућавају лакше клизање тетива изнад коштаних избочина. Бурзитиси се јављају у оквиру реуматских болести, после трауме, због инфекције бурзи или из непознатог разлога. |
 |
Ентезопатија је дегенеративно или запљењско обољење припоја тетиве, лигамента, капсуле зглоба, припоја фасције или анулуса фиброзуса. Најчешћи је облик ванзглобног реуматизма. |
 |
Реч остеопороза води порекло из Грчке : „osteun"=кост и „poros"=пора, а означава болест костију која доводи до повећаног ризика од прелома. Код остеопорозе коштана густина (bone mineral density=БМД) је смањена, микроархитектура костију пропада, а количина и однос протеина у костима се мења. |
 |
Реуматоидни артритис представља хронично, запаљенско,симетрично и системско обољење везивних ткива које се најчешће испољава на периферним зглобовима. Код неких болесника могу се открити и промене других ткива и органа - унутрашњих органа, нервног система и коже. |
 |
Гихт или уратни артритис представља метаболичко обољење зглобова који је последица хиперурикемије и хиперуратемије (високог нивоа мокраћне киселине) настале због генетски условљеног ензимског поремећаја у метаболизму пурина. Гихт се карактерише акутним епизодама артритиса са рецидивима и последичном нефролитијазом или уратном нефропатијом (талог урата у медули бубрега). |
 |
Протекли викенд на одељену Ухо, грло и нос у Општој болници Панчево протекао је уобичајено. Нажалост један случај алергијске реакције на поврће био је изузетно тежак истиче доктор Вељко Божић начелник овог одељења и додаје да је неопходно детаљно прати воће и поврће јер не знамо колико је заиста прскано. |
| На иницијативу Управног већа Уједињених нација од 1989. године Светски дан становништва обележава се 11. jула. |
| У овом периоду најчешћи пацијенти у ОРЛ амбуланти Опште болнице су малишани које родитељи доводе због упале уха. |
 |
Након учешћа на јавном конкурсу Покрајинског секретеријата за здравство за доделу средстава за изградњу, одржавање и опремање здравствених установа чији је оснивач Аутономна покрајина Војводина, Општа болница Панчево добила је значајна средства за набавку нове, најсавременије медицинске опреме. |
| Хипертензија се јавља у 5-10% трудноћа. Постоји четири типа хипертензије у трудноћи: претходна или хронична хипертензија, гестациона хипертензија, прееклампсија и еклампсија, претходна хипертензија која, се компликује еклампсијом. |
| Заговорници ове дијете тврде да можете изгубити тежину док једете онолико протеина и масти колико желите ако избегавате храну богату угљеним хидратима. |
| ХИВ је сексуално преносива инфекција. Такође се може пренети контактом са зараженом крвљу и убризгавањем дрога или дељењем игала. Иако у 2022. знато ређе због развијеније дијагностике, ХИВ се може пренети са мајке на дете током трудноће, порођаја или дојења. Без терапије, могу проћи године пре него што ХИВ ослаби ваш имуни систем до те мере да имате СИДУ. |
 |
Алергијска реакција представља претерану, несврсисходну и неспецифичну реакцију организма на неки стимулус или супстанцу, која иначе не би требало да буде штетна по организам. |
 |
Са првим излагањем сунцу на нашој кожи често се појављују алергијске реакције. Црвенило, свраб, осип, мехурићи или болни чворићи на кожи врло су непријатни, а јављају се неколико минута до неколико дана од првог излагања коже сунцу. |
 |
„Prurigo nodularis" је кожна болест која се карактерише појавом врло тврдих нодулуса (чворића) без тенденције регресије. |
 |
Соларна уртикарија је акутна уртикаријска реакција која се јавља убрзо после излагања сунцу сунчевим зрацима или вештачком светлу. |
 |
Сунце је неопходно за живот на Земљи. Познато је да су га још старе културе поштовале као божанство. Историјски записи говоре о благотворним ефектима сунца на тело и расположење човека, због чега се и користило за лечење различитих промена на кожи. |
 |
Под појмом масивна хемоптизија у одраслих подразумева се експекторација више од 600 мл крви, док се код деце, наравно, ради о мањим количинама. Масивна хемоптизија је једно од најтежих ургентних стања у дечјој онкологији, са великом смртношћу. |
 |
Хемофилија Б представља X везано, рецесивно обољење које се карактерише недостатком фактора коагулације IX. Дакле, у питању је урођено обољење које се карактерише поремећајем механизма коагулације крви, мада до њене појаве може доћи и спонтано током живота, нарочито деловањем одређених имунолошкх процеса. |
 |
Хемофилија А представља наследно X везано, рецесивно обољење које се карактерише недостатком фактора коагулације VIII. Проблем код ове болести је што постоји веома велика предиспозиција ка појави крварење због поремећног пута коагулације, као и могућност настанка инфекција, што је нарочито истакнути проблем током последњих година. |
| Срце је централни орган који функционише као пумпа, доводећи крв до сваког органа. На тај начин обезбеђује кисеоник и храњиве материје читавом организму. Нажалост, срчане сметње нису проблем само код старијих. Све више погађају и децу. С обзиром на то да се симптоми често испољавају на другачији начин него код одраслих, као и чињенице да се малишани ретко жале на њих, дијагностификовање је комплексно. |
| Бављење спортом је главна заштита од срчаног удара и кардиоваскуларних болести, а пацијентима који су прележали инфаркт кардиолози неизоставно препоручују да што пре започну физичку активност. Кретање је најважнија заштита од срчаних болести. |
 |
Злоупотреба дрога је озбиљан светски проблем, који захтева континуирану, мултисекторску сарадњу институција, са мерама и активностима усмереним ка појединцу и заједници. У Србији се 26.ог јуна сваке године обележава Међународни дан против злоупотребе и кријумчарења дрога организовањем различитих активности као што су предавања, трибине, дистрибуција промотивног материјала за становништво и сл. У активности су укључене школе, полиција, здравствене установе, медији, удружења грађана. |
| Варикси једњака представљају проширења венских крвних судова субмукозног слоја (слој испод слузокоже) једњака. Настају као последица повећања притиска у систему вене порте, која носи крв из органа дигестивног тракта у јетру. |
| Бациларна дизентерија, позната и под називом шигелоза (shigellosis), је акутно инфективно цревно обољење узроковано бактеријама из рода Shigella. |
 |
За ублажавање симптома миастеније гравис од пресудне је важности у исхрану укључити довољну количину антиоксиданса, чак и превентивно. Потребно је смањити употребу млечних производа, производа који садрже глутен, употребу шећера, пржене хране, незасићених масти, процесуиране хране, алкохола, генетски модифицираног меса и обавезно престати пушити. |
 |
Према Календару здравља, јун се обележава као месец свесности о Миастенији гравис , како би се изразила међународна солидарност у пружању подршке оболелим особама, које поред хроничних здравствених тегоба, имају и значајну нарушену радну и животну способност. |
 |
Захваљујући добром пословању и средствима која су обезбеђена од Светске банке и Покрајине у Општу болницу Панчево стигла су два нова најсавременија апрата, која ће много значити лекарима и пацијентима |
 |
Радијус је једна од две кости подлакице и налази се са спољашње стране у односу на улну. Прелом на типичном месту радијуса (или дистални преломи радијуса) су једни од најчешћих прелома уопште са око 15% свих прелома и најчешће се налазе код одраслих особа, али се могу наћи и код млађих особа и код деце. Прелом се најчешће налази на око 3цм изнад зглоба ручја. |
 |
Светски дан добровољних давалаца крви обележава се сваке године 14. јуна у циљу захвалности према добровољним даваоцима крви. Овај дан је посвећен подизању свести о глобалној потреби за сигурном и безбедном донацијом крви и начину како би сви могли да дају свој допринос. Светска здравствена организација је 2005. године одредила овај датум као дан којим се захваљује свим добровољним даваоцима крви и подстиче људе да дају своју крв. |
 |
Општа болница Панчево ће, на основу уговора који је закључило Министарство здравља РС, а у оквиру пројекта Светске Банке SCERP, добити нови најсавременији рендген уређај који ће значајно утицати на још веће подизање нивоа квалитета нашег рада, и сигурни смо,степена задовољства корисника наших услуга. |
 |
Акутни мождани удар (инфаркт мозга, инсулт, шлог, мождана кап) је болест која настаје услед запушења крвног суда (акутни исхемијски мождани удар- 75-80% болесника) или прскања крвног суда и изливања крви у мозак или око мозга (акутни хеморагијски мождани удар - 20-25% болесника). |
 |
Исхрана може бити прави изазов оним пацијентима који су оболели од карцинома, с обзиром на то да њихов имунолошки систем није ослабљен само малигним ћелијама већ и лечењем. Најчешће се примењује хемотерапија, која може довести до многих компликација као што су: губитак апетита, отежано гутање, мучнина с повраћањем, храна нема исти укус и мирис као раније. Могу се јавити дијареја и затвор, а уобичајене су и нагле промене у телесној тежини. Пацијенти су често депресивни, па често губе вољу за храном. |
| У више од 150 земаља свете данас се обележава Светски дан заштите животне средине, који је ове године носи назив „Имамо само једну планету Земљу“ (ориг. #OnlyOneEarth)наглашавајући климатске промене, губитак биодиверзитета и загађење, истовремено подстичуцћи све да живе и делују одрживо у складу са природом. |
 |
Понекад тело погрешно протумачи опасност и покрене непримерено бурну одбрамбену реакцију. Таква реакција преосетљивости назива се алергија. Најчешћи облик алергије је алергија на полен, која се још назива и поленска кијавица. Обично почиње у марту и може трајати све до краја октобра, а узрокује је полен трава, дрвећа и корова. |
 |
Захваљујући новцу Покрајинске владе и Министарства здравља Републике Србије Панчевачка болница после дванаест година купиће нови скенер, а биће замењен и један од рендген апарата који је у употреби читавих пет деценија. |
 |
Горушица је појава приликом које се кисели садржај из желуца враћа у једњак, јер је мишићни прстен на доњем крају једњака релаксиран више него обично. Манифестује се као болан осећај, или осећај печења у горњем делу стомака, или груди, а понекад зрачи и у врат. |
 |
Главни симптом хроничног ларингитиса и нодуса гласних жица јесте промуклост, односно дисфонија. Лекар опште медицине може уз мало вежбе да савлада технику извођења индиректне ларингоскопије и да самостално обави преглед гласних жица. Три најчешћа патолошка налаза су еритем/едем једне или обеју гласних жица, нодус на гласним жицама и пареза гласних жица. |
 |
Хронични тонзилитис палатиналних тонзила препознаје се или као акутизација хроничне болести, уз одговарајуће упалне симптоме (повишена температура, гушобоља, малаксалост, полимијалгија...), или као узгредни налаз, приликом чега се открива хипертофија тонзила (код деце и омладине) или атрофија, каткад са зјапећим криптама (код одраслих). |
 |
Хронични синуситис је запаљење слузокоже синусних шупљина и ово стање постоји, ако тегобе као код акутног синуситиса перзистирају и трају дуже од 8 недеља. |
 |
Масна јетра је једна од најчешћих болести данашњице. Иако је ова болест у потпуности излечива, најчешће и без терапије, већ само променом животних навика, болести јетре су ипак значајан узрочник смртности у целом свету.Последица je накупљања масти у јетри која прелази 5 % укупне тежине јетреног ткива. Масна јетра се дуго сматрала бенигним стањем, које не напредује у болест, међутим, временом се показало да стеатоза јетре може бити врло озбиљна, те може довести до цирозе јетре. |
 |
Ултразвучни преглед стомака (абдомена) је безболна и нешкодљива метода помоћу које лекар прегледа органе смештене у унутрашњости трбушне шупљине. Ултразвуком абдомена прегледају се јетра, жучна кеса, жучни путеви, гуштерача (панкреас), слезина, оба бубрега, надубрежне жлезде, мокраћна бешика, простата (код мушкараца), као и велики крвни судови и лимфни чворови у трбушној шупљини. |
| Примарни карцином јајовода веома је ретка болест. Процењује се да је његова учесталост 0.1 - 0.4% свих гинеколошких карцинома, док морталитет износи 65% укупног морталитета узрокованог карциномима. Далеко је чешћи секундари (метастатски) тумор. Због релативно касног откривања болести, касно спроведене терапије и природе малигног процеса, прогноза карцинома је релативно лоша. Излечење се постиже највише код 20 % болесница. |
| Инсулин је откривен 1921. године на Универзитету у Канади. Изолован је из гуштераче пса, првобитно је назван ислетин да би касније био преименован у инсулин. Године 1922. четрнаестогодишњи дечак Леонард Т. постао је први болесник који је примио инсулин. Инсулин је постао доступан за широку потрошњу већ 1923. године, а исте године додељене су три Нобелове награде за рад на инсулину. |
 |
Покрајински секретеријат за здравство издвојио је преко 80 милиона динара за куповину нових медицинских апарата намењених Општој болници Панчево. Захваљујући овим новим апаратима дијагностика ће бити бржа и прецизнија. |
 |
Многе особе с дијабетесом имају проблеме с видом. Сметње вида чешће се јављају код дугогодишњих дијабетичара и код оних пацијената код којих је регулација шећера у крви неодговарајућа. |
 |
Жене поседују XX генотип, а мушкарци XY. Будући да је X везано наслеђивање код ове болести, мушкарци увек оболевају, за разлику од жена које могу бити само преносиоци без појаве симптома. |
 |
Чмичак је акутна и локализована гнојна упала фоликула трепавица, или лојних жлезда очног капка. |
 |
Сузе продукују сузне жлезде, главне и помоћне. Сузе се сузним поточићем и преко сузних тачкица и каналића уливају у сузну кесицу из које даље путем сузно-носног канала отичу у носну шупљину. Обољења сузног апарата испољавају се знацима сузног и сувог ока. |
| Светски дан биодиверзитета се у целом свету обележава 22. маја, док неке државе организују низ догађаја у оквиру Међународне седмице биодиверзитета. Ирска је позвала оне који излазе на рекреацију да сликају или сниме сваког вилиног коњица и водену девицу које угледају. Јамајка се усредсредила на представљање пројеката за заштиту природе, али убацила је и виртуелну изложбу. На другим местима на нашој планети, ентузијасти показују како користе локалне биљке или учествују у играма заснованим на научним сазнањима. |
 |
Месечарење укључује устајање и ходање док сте у стању сна. Чешће код деце него код одраслих, ходање у сну се обично прерасте у тинејџерским годинама. Изоловани случајеви месечарења често не сигнализирају озбиљне проблеме нити захтевају лечење. Међутим, понављано ходање у сну може указивати на основни поремећај спавања. |
 |
Нарколепсија је хронични поремећај сна који карактерише јака дневна поспаност и изненадни напади сна. Oсобама са нарколепсијом је често тешко да остану будни током дужег временског периода, без обзира на околности. Нарколепсија може изазвати озбиљне поремећаје у вашој свакодневној рутини. |
 |
Херпес Симплекс (ХСВ) представља вирусну инфекцију коже и слузокоже која када се једном активира, може понављати више пута у току живота. Постоје два типа овог вируса, тип 1 и тип 2. Чешћи, тип 1, јавља се на лицу и уснама. Тип 2 или генитални херпес, захвата полне органе. |
 |
Сепса је системски запаљенски одговор са постављеном сумњом или доказаним микробиолошким узрочником. Тешку сепсу прати дисфункција једног или више органа. |
 |
Светски дан без дуванског дима обележава се сваке године 31.маја, а покренули су га Светска здравствена организација и њени партнери. Његовим обележавањем истичу се здравствени и други ризици који се повезују са употребом дувана и залаже се за делотворне политике којима се смањује употреба дувана. |
| Повећан је број прегледа у ортопедској амбуланти Опште болнице Панчево, помоћ лекари најчешће указују због падова, спортских повреда и саобраћајних несрећа. |
 |
Генерална скупштина УН је 1993. године у рeзoлуциjи А/РЕС/47/237 oдлучила да сe 15. мај сваке године обележава као Међународни дан породице. Оваj дан пружа прилику за унапрeђeњe свeсти o питањима кojа сe oднoсe на пoрoдицe и за пoвeћањe знања o сoциjалним, eкoнoмским и дeмoграфским прoцeсима кojи утичу на пoрoдицe. |
 |
У Општој болници у Панчеву, лечи се више од 200 хиљада људи из читавог Јужног Баната, пројектовани капацитети одавно су превазиђени. Посебно тешко било је за време пандемије. Испред реконструисаног интернистичког блока Опште болнице Панчево говорио је директор Опште болнице Панчево, др Слободан Овука< |
 |
Светски дан борбе против хипертензије обележава се 14. маја широм света са циљем да едукује и пробуди свест јавности о значају редовног мерења крвног притиска, како би се хипертензија правовремено дијагностиковала и лечила. |
 |
Међународни дан медицинских сестара 12. мај обележава се широм света, на годишњицу рођења Флоренс Најтингејл британске медицинске сестре, зачетнице модерног сестринства као признате професије. У сарадњи Опште болнице Панчево, Завода за јавно здравље Панчево, Медицинске школе "Стевица Јовановић" и Дома здравља Панчево организовани су превентивни прегледи током којих су грађанима, између осталог, мерени шећер и масноће у крви као и крвни притисак |
| Овај синдром настаје због увећања или упале тетива мишића које пролазе кроз предео зглоба ручја. Основ патофизиолошког механизма је притисак на n. medianus на улазном простору у предео шаке тзв. карпалном тунелу. Последица компресије је појава отока нерва која најпре ремети спровођење импулса кроз површна влакна, која су сензорна, а потом и дубље постављена, моторниа. Из овога проистиче да је најпре приметан испад сензибилитета дистално од карпалног тунела а потом се мења и моторика шаке. |
| Национални дан добровољних давалаца крви се традиционално обележава 11.маја, док се у свету он обележава 14.јуна. Дан добровољних давалаца крви обележава се у циљу захвалности према добровољним даваоцима крви. Овај дан је посвећен подизању свести о глобалној потреби за донацијом крви како би сви могли да дају свој допринос. |
| Према подацима из истраживања здравља становништва Србије у 2006. години више од две трећине одраслог становништва у Србији је физички неактивно (67,7%). Проценат одраслих становника који је вежбао више од три пута недељно износио је 25,5%, што је значајно повећање у односу на 2000. годину када је тај проценат био 13,7%. У 2006. години 31,1% запослених у Србији се бавило седентерним типом посла, за разлику од 2000. године када је тај проценат износио 25,2%. |
 |
У четвртак, 12. маја, у Народној башти у Панчеву биће обављени превентивни прегледи током којих ће грађанима, између осталог, бити мерен шећер и масноће у крви и крвни притисак, саопштио је Дом здравља Панчево. Акција превентивних прегледа, како се наводи у саопштењу, биће организована од 8 до 12 сати код волијере у Народној башти (код „круга”) у сарадњи Опште болнице Панчево, Завода за јавно здравље Панчево, Медицинске школе и Дома здравља Панчево, а поводом обележавања Међународног дана сестринства, 12. маја. |
 |
Сиптоми код одраслих особа са АДХД-ом укључују тешкоће при управљању временом, тешкоће са памћењем, организацијом, емоционалном регулацијом и још много тога. Сазнајте како изгледа АДХД код одраслих и како се дијагностикује и лечи. (енгл. ADHD - Attention- Deficit Hyperactivity Disorder). |
 |
Већина људи је доживела искуство када зна да је нешто направила - закључала врата од куће, затворила плин али ипак после тога настаје дилема да ли су то заиста урадили. Некада, може бити потребно да се изнова провери оно за шта знате да сте урадили, да би сте могли даље наставити дан и почети мислити о нечем другом. |
 |
Хипохондрија се може дефинисати као преокупираност страхом или мислима да је особа оболела од неке теже болести, што је последица погрешног тумачења телесних симптома. |
 |
Oдељење за пријем и збрињавање ургентних стања Опште болнице Панчево интервенише код најтежих пацијената. Пријемно-ургентна служба у потпуности је опремљена новим апаратима за дијагностику како би пацијентима одмах била постављена дијагноза. Нажалост, најтежи случајеви збрињавају се након саораћајних незгода у којима најчешће учествују млади људи. |
 |
Астма је хронични инфламацијски процес у дисајним путевима, у коме учествују многе ћелије, укључујући мастоците и еозинофилне леукоците. Болест се код осетљивих особа манифестује отежаним дисањем, звиждањем у грудима (визинг) и кашљем, удруженим са распрострањеном, али варијабилном опструкцијом у дисајним путевима, најчешће реверзибилном спонтано или применом терапије. Болест се карактерише појачаном реактивношћу бронхија на различите надражаје. |
| Занимање бабица је једно од најстаријих и најплеменитијих. Но, упркос томе, међународна конфедерација бабица је тек 1992. установила 05. мај званичним, међународним, даном бабица. Циљ оваквог поступка је био промоција овог занимања, размена примера добре праксе и, кроз унапређење рада бабица, унапређење здравља жена. |
| Међународни дан бабица 05. мај, установила је интернационална конференција бабица 1992. године, а традиционално се у Србији обележава од 2009. године. |
 |
Главна карактеристика ових психијатријских поремећаја је присуство анксиозности, односно страха. Ова два осећања, анксиозност и страх, се јављају увек када проценимо да нам прети нека опасност. Кажемо да се ради о страху ако је опасност непосредна, а да се ради о анксиозности ако особа страшљиво исчекује неку опасноcт у будућности. |
 |
Агорафобија је првобитно означавала страх од отвореног простора, док се данас под тим појмом подразумева скуп страхова у вези са јавним местима, отвореним простором и великим бројем људи, са страхом да на таквом месту након изненадног онеспособљења не би били у стању побећи или потражити помоћ. |
 |
Међународна организација рада обележава овај дан организовањем кампања за подизање свести, која фокусира пажњу међународне јавности на проблеме у овој области и промоцију безбедности и здравља на раду. |
| Псоријаза је распрострањено хронично аутоимуно запаљенско кожно обољење, које се обично састоји од периода побољшања и погоршања. Најчешће се јавља врста псоријазе која има упадљиво оивичене наслаге које могу бити или ружичасте или сиве боје, прекиривене сребрнкастом љуспастом кожом. |
 |
Данас је ултразвук врата и посебно штитасте жлезде поступак од великог значаја у откривању,оцени и праћењу тироидног/тироидних нодуса и треба га применити и ако се присуство нодуса утврди палпацијом. |
 |
Парализе нерва фацијалиса после повреде пирамиде темпоралне кости могу да буду ране и касне. Ране парализе настају у тренутку повређивања, а касне неколико часова или неколико дана после повреде. |
 |
Повреде бубне опне су најчешће изазване шиљатим и оштрим предметима који служе за чешање спољашњег слушног ходника, наглим зароњавањем у дубину воде или шамарима у пределу ува. |
 |
Епиглотитис је акутна инфекција која захвата супраглотични део ларинкса и може да доведе до асфиксије и потенцијалне смрти детета. |
 |
Највећи хришћански празник започињемо Великим петком, најтужнијим даном хришћанства. Овај дан посвећујемо Христовом страдању. Проведимо га у миру и молитви у кругу својих породица. |
 |
Сваке године, 22-ог априла обележава се Међународни дан планете Земље у циљу скретања пажње грађанима на значај очувања природе и спречавања негативних последица по животну средину. Данашњи дан се од 1970. године у целом свету обележава као Међународни дан наше планете. |
 |
Илеус представља изостанак нормалног протока цревног садржаја из било ког разлога |
 |
„Apendix vermiformis" (црвуљак) представља формацију лимфоидног ткива црволиког изгледа која се у највећем броју случајева налази на споју дебелог и танког црева. Често се назива и трбушни крајник, јер по својој грађи у великој мери подсећа на крајнике. |
 |
Залихе свих крвних група већ извесно време су у дефициту. Тренутно највише недостаје А негативна крвна група, али и остале крвне групе са РХ негативним фактором |
 |
Невољно мокрење се стручно назива уринарна инконтиненција. То је један од најчешћих проблема у урологији, поготово код женске популације. Главни узрок тога је анатомско-физиолошка разлика међу половима. Кратка уретра, одсуство простате, специфични хормон статус… |
 |
Двадесетог априла сваке године обележава се Међународни дан заштите од буке. Циљ обележавања је да се кроз различите активности ради на подизању свести о овом проблему. Процењује се да у Европској унији, око 56 милиона људи (око 54%) живе у средини изложеној саобраћајној буци већој од дозвољене просечне вредности, која се сматра ризичном за здравље. |
 |
Ускрс је највећи хришћански празник и време када славимо наду у свет заједништва, љубави и разумевања међу људима. Праштајмо, волимо и чинимо добро другим људима јер само тако можемо учинити овај свет бољим за живот свих нас! |
 |
Повољна епидемиолошка ситуација са вирусом ковид 19 је у панчевачкој болници, где се недељама не повећава број пацијената. Клиничка слика оболелих који сe лече на Инфективном одељењу је лакша, истиче ПР Опште болнице, докторка Слађана Ковачевић. |
 |
Светски дан здравља обележен је у Панчеву акцијом превентивних прегледа у Месној заједници Тесла, у организацији Дома здравља Панчево, Завода за јавно здравље и Опште болнице. Заинтересовани су на једном месту могли да ураде основне лабораториске анализе, ураде ултразвук штитне жлезде и добију савет како да брину о свoм здрављу. |
 |
„Q" грозница представља зоонозу коју узрокује „Coxiella burnetii", Грам-негативна интрацелуларна бактерија. |
 |
Бронхиолитис представља обољење бронхиола које настаје као последица инфламаторне опструкције малих дисајних путева, и најчешћа је тешка респираторна инфекција код одојчета. |
 |
Деменција се дефинише као стечено снижење менталних способности у најмање две области (на пример: памћење и говор, памћење и опажање, оријентација у простору и опажање итд.) и временом се погоршава. |
 |
На Пријемно ургентно одељење Опште болнице Панчево стигла је донација вредна два милиона динара. Српско-америчка медицинска организација из Вашингтона донирала је: 7 лежећих покретних кревета, два ормара за терапију, покретна колица за терапију, 7 сталака за инфузију, 3 паравана троделна и 3 једноделна, дефибрилатор, 3 екг апарата, 4 кисеоничне главе са адаптером, 7 мерача за притисак, као и 1 мали аспиратор и 2 велика аспиратора! Од срца им се захваљујемо на овој несебичној и веома значајној помоћи! |
 |
Трећа недеља априла обележава се као Европска недеља имунизације и представља годишњи догађај чији је општи циљ повећање обухвата имунизацијом и јачање уверења о потреби заштитесваког детета од заразних болести које се могу спречити вакцинацијом. Имунизација је једно од највећих достигнућа јавног здравља двадесетог века. Једноставан је безбедан и ефикасан начин заштите од одређених заразних болести. На овај начин се превенирају заразне болести, њихове компликације као и смртни исходи. |
| Светски дан здрављa (енгл. World Health Day) обележава се широм света 7. априлa сваке године под покровитељством Светске здравствене организације. Одлука да се овај дан обележава као Светски дан здрављa донесена је на 1. скупштини ове организације, одржаној од 24. јунa до 24. јулa 1948. године у Женеви, пошто je 7. априла исте године одлука o конституисању СЗO званично ступила на снагу након што је и последња држава чланица УН ратификовала ову одлуку. |
 |
Рак дојке је једна од најчешћих малигних болести код жена.У свету преко милион и по људи оболи од карцинома дојки.Малигне неоплазме представљају такав поремећај раста ћелија појединих ткивагде долази до прекомерног умножавања ћелија.Подела ћелија се у нормалним условима, одвија на уобичајен и контролисан начин, али уколико се из неког разлога овај процес отргне контроли, ћелије настављају да се деле и стварају отеклину која се назива тумор. |
| Аутизам се дефинише као развојни поремећај који карактерише склоност у понашању и комуникацији које утичу на способност особе да управља друштвеним интеракцијама и такође узрокује репетитивно и ограничено понашање. У свету, преко 7.500.000 људи потпада под спектром аутизма. |
| Жилберов (Гилбертов) синдром је најчешћи наследни поремећај метаболизма билирубина. Манифестује се благом некоњугованом хипербилирубинемијом која није изазвана хемолизом и обољењем јетре. |
| Индекс телесне масе ( енгл. body mass index - BMI) је вредност која се добије када тежину особе у килограмима поделимо са квадратом висине у метрима. BMI је јефтина и лака метода скрининга за телесну масу - подхрањеност, здрава телесна маса, прекомерна тежина и гојазност. |
 |
Хематурија представља присуство крви у урину (мокраћи). Уопштено, о хематурији се говори када постоји, или више еритроцита у једном милилитру урина и тада се каже да постоји микрохематурија (невидљива голим оком), међутим када се хематурија види голим оком, тада се користи назив макрохематурија. |
 |
Дизурија није болест, или стање већ симптом који се описује као појава отежаног, или болног и непријатног мокрења (уринирање). Често се дизурија описује и као осећај печења приликом мокрења. |
 |
Карцином (рак) бубрега представља око 3% свих малигнитета одраслих особа, а око 95% свих тумора који погађају бубрег. Ову болест карактерише недостатак раних знакова упозорења, различити клинички токови и отпорност на зрачење и хемиотерапију. |
 |
Бенигна хиперплазија простате (БХП) је немалигни, прекомерни раст ћелија простате. Како се хиперплазија развија, тако се уретра (цев којом урин излази из бешике) постепено сужава што доводи до великог броја неугодних и узнемирујућих симптома. |
 |
Простатодинија се користи као термин за дијагностиковање хроничног болног синдрома упале карлице са симптомима идентичним простатитис-у. |
 |
Јавља се углавном након 40. године живота. Микроскопски тумори простате се откривају код 70-90% мушкараца између 80 и 90 године. Ова врста тумора је заступљенија у Северној Европи, Северној Америци и Новом Зеланду у односу на Јужну Америку и медитеранске земље, а најниже стопе имају Израел, Русија и Јапан. |
 |
Упала простате честа је болест која бар једном у животу погађа 10 - 15% мушкараца. Симптоми су у најблажем облику непријатни, а обично се јавља јака бол. Простата је жлезда која је део мушког полног система. Смештена је испод мокраћне бешике, а испред ректума, завршног дела дебелог црева. |
 |
Простата је мушка полна жлезда која представља део мушког репродуктивног система. Налази се између бешике и ректума, а окружује уретру, цев која проводи мокраћу из бешике кроз пенис. Она производи материје које улазе у састав ејакулата. |
 |
Говоримо у ситуацији која је много боља, јер је број хоспитализованих доста смањен. Чини се да нам овај вирус, иако поптуно непредвидиљив, полако дозвољава да се вратимо у нормалу. Тако се Општа болница Панчево током читаве две године борила против ковида али и у својој зеленој зони са свим болестима које иначе лечи. |
| У организацији одељења хирургије Опште болнице Панчево, у петак 18.03.2022. је организована хируршка секција Друштва лекара Војводине. Стручном састанку су осим домаћина присуствовали и хирурзи из Клиничког центра Војводине, општих болница из Зрењанина, Кикинде, Вршца, Сремске Митровице, Сомбора, Суботице и Сенте. Пред пуном свечаном салом у згради градске управе састанак је отворио директор Опште болнице, др Слободан Овука. |
| Акутна упала средњег уха (Otitis media acuta, скраћено АОМ) је упала слузнице средњег уха, Еустахијеве тубе и бубне опне, и представља једну од најчешћих инфекција код деце. |
| Туберкулоза је хронична, заразна болест коју узрокује Кохов бацил тј. Mycobacterium tuberculosis. Најчешће захвата плућа, али може се јавити и у другим органима. |
| У децембру 2011. године, Генерална скупштина УН је прогласила 21. март за Светски дан особа са Дауновим синдромом. Годинама уназад, бројне хуманитарне организације посвећују велику пажњу овом дану, а сваким даном је инклузија особа са Дауновим синдромом све већа. С тим у вези, морамо напоменути и да и даље постоји одређена доза дискрминације и одбацивања а на нама је да подигнемо свест о особама са Дауновим синдромом и да покажемо да љубав и пријатељство не знају за границе и број хромозома! |
| Светски дан вода слави воду и подиже свест од глобалној кризи са водом, а основни фокус обележавања је подршка постизању циља одрживог развоја (СДГ) 6: вода и санитација све до 2030. године. |
| Карцином дојке је најчешћи малигни тумор у оболевању и умирању код жена у Србији. У просеку сваке године у Републици Србији региструје се 4237 новооболелих жена од ове врсте малигног тумора. |
 |
Због смањеног броја ковид пацијента у Општој болници Панчево полако се одељења која су била у ковид систему враћају у нормалан рад. |
 |
У роду „Proteus" се налазе две врсте: „Proteus mirabilis" и „Proteus vulgaris". Обе врсте припадају групи Грам негативних бактерија, штапићастог обилка. Имају перитрихијално распоређене флагеле и врло су покретљиви. Немају способност синтезе капсуле. |
 |
Све „Klebsiellae" су Грам негативни бацили са заобљеним крајевима. Распоређују се појединачно или у виду парова. Немају флагеле и непокретне су. Фимбрије са адхерентним својствима и капсула представљају значајне факторе вируленције. |
 |
Род „Enterobacter" припада породици „Enterobacteriaceae" и састоји се од четири врсте: „E.aerogenes", „E.cloacae", „E.georgoviae" i „E.sakazaki". |
 |
E. Coli, скраћено од Escherichia coli ( ешерихија коли ) је врста бактерије из рода Escherichia и породице Enterobacteriaceae и широко је распрострањена у природи. Припада групи бактерија које су нормални становници црева многих животиња и људи, где помажу у варењу хране. |
 |
Инфекције уринарног тракта су честе у детињству. Могу се јавити код свих узраста деце и захватити различите делове уринарног система. Чешће су код девојчица него код дечака, а према узрасној групи су најчешће код деце до 5 година живота. |
 |
У организму човека постоји преко 500 врста бактерија. Све те бактерије су добре за организам, и одржавају нормалну физиолошку флору тј. цревну флору. Такве бактерије често се називају пробиотским бактеријама, и оне представљају примарну заштиту организма од патогених бактерија. |
 |
Пробиотици су живе бактерије и квасци које су добре за пробавни систем и здравље целог организма. У телу има много бактерија, неке од њих су добре, док су друге лоше. Пробиотици спадају у добре бактерије јер користе организму да буде здрав, а пре свега цревима и целокупном систему за варење. |
| Хронична венска инсуфицијенција означава дисфункцију венског система узроковану валвуларном инкомпетенцијом која може бити удружена и са венском опструкцијом. |
| Светски дан бубрега обележава се на иницијативу Међународног друштва за нефрологију и Интернационалног удружења Фондације за бубрег у више од 100 земаља широм света. Од 2006. године обележава се у марту месецу. Циљ је подизање свести о важности бубрега, органа који има кључну улогу у одржавању живота и упознавање јавности да су болести бубрега честе, опасне и излечиве. |
 |
Глауком је хронично обољење ока које је један од водећих узрока губитка вида. Процењује се да у Србији на десетине хиљада људи болује од ове болести. Најважнији фактор ризика за настанак глаукома је повишен очни притисак. |
 |
Реуматоидни артритис (РА) је хронична упала зглобова, непознатог узрока, променљивог тока и трајања, од које болује 0,5-1% светске популације. Три пута чешће погађа жене него мушкарце. |
 |
Гихт или уратни артритис представља метаболичко обољење зглобова који је последица хиперурикемије и хиперуратемије (високог нивоа мокраћне киселине) настале због генетски условљеног ензимског поремећаја у метаболизму пурина. |
 |
Сви у животу имамо жене које највише волимо – супруге, мајке, баке, тетке, стрине, ујне, колегинице, девојке, комшинице... Све оне заслужују поштовање и љубав сваког дана у години, а не само данас! |
 |
У претходних неколико недеља лекари са одељења Ортопедије са трауматологијом Опште болнице Панчево су у сарадњи са колегама из Института за ортопедију „Бањица“ извели низ операција иновативним приступом, комбинацијом артроскопске и отворене хирургије за лечење повреда лигамената колена и стабилизације зглоба рамена. |
 |
Карцином гркљана (ларинкса) је најчешћа малигна творевина у подручју главе и врата. Болест се чешће јавља код мушкараца средњег и старијег животног доба. Већа учесталост се повезује са пушењем и конзумирањем алкохола. |
 |
Хронични синуситис је запаљење слузокоже синусних шупљина и ово стање постоји, ако тегобе као код акутног синуситиса перзистирају и трају дуже од 8 недеља. |
 |
Хематоми ушне шкољке (отхаематома), настају као последица субперихондралне акумулације крви након трауме усне шкољке. Уколико се не лече адекватно и на време, доводе до хондритиса, апсцеса и васкуларне некрозе хрскавице, која се ретрахује и узрокује касније трајне деформитете. |
 |
Након носних повреда често се јавља хематом носног септума и тада долази до акумулације крви субперихондрално, са одвајањем мукопериходријума који је одговоран за исхрану хрскавице. Резултат је васкуларна некроза и рефракција носних хрскавица са последичном депресијом хрскавичаве пирамиде носа, што узрокује деформацију познату као „седласт нос". |
 |
Синусна брадикардија означава успорење срчане фреквенције испод 60 откуцаја у минути. Спори ритам срца може бити физиолошки нормалан за неке пацијенте, док фреквенција < 60/мин може бити неадекватна за друге. |
| На Дечијем Интерном одељењу Опште болнице смањен је број деце којима је неопходно болничко лечење. Педијатри се труде да сва деца чије здравствено стање може бити лечено у амбуланти и не захтева обавезно болничко лечење буду збринути у амбуланти, због епидемоиолошке ситуације. |
 |
Кројцфелд-Јакобова болест (ЦЈД, кортокостриатоспинална дегенерација, субакутна спонгиформна енцефалопатија) спада у групу спорих инфекција нервног система. Изазвана је прионима. Одликује се дугом, вишегодишњом инкубацијом, спорим и дугим клиничким током и смртним исходом. |
 |
Вируси који се обично називају респираторним обухватају више разнородних група вируса, али је клиничка слика болести које изазивају веома слична. Етиолошка потврда болести захтева вирусолошка испитивања, која у клиничкој пракси најчешће и нису потребна, због лаке клиничке слике болести. |
 |
Целијакија или глутенска ентеропатија је хронична болест, претежно проксималних делова танког црева, која настаје услед неадекватне имунске реакције у контакту са глутеном, у генетски предиспонираних особа. |
 |
Ретка болест подразумева сваку болест која се јавља код највише 1 од 2 000 особа. Према проценама, постоји између 6.000 и 7.000 ретких болести |
| Ингестија страних тела подразумева гутање било ког страног објекта. Честа је појава код три категорије пацијената: 1. деце у узрасту од 18-48 месеци, 2. психијатријских болесника и затвореника, 3. пацијента без зуба. Најчешћи разлог је случајно прогутано страно тело. |
| Гастроскопија је ендоскопска метода која која омогућава директан преглед унутрашњих органа. Иако се овај преглед често назива само гастроскопија, пуни назив је езофаго - гастро - дуоденоскопија (ЕГДС) и њом може прегледати једњак (езофагус), желудац (гастер) и дванаестопалачно црево (дуоденум). |
 |
Из покрајнског Завода за трансфузију крви ових дана стиже информација да су залихе свих крвних група на минимуму и да нарочито недостају нулта и Б негативна крвна група. Апелују на све добровољне даваоци да дају крв у оквиру акција које се организују, јер једна јединица крви може некоме и да спасе живот.Са једним давањем крви може се некоме знатно побољшати здравствено стање, а није радак случај ни да се некоме спасе живот. Зато је важно у сваком моменту имати довољно крви. |
 |
Хемохроматоза је генетски условљен аутозомно рецесивни поремећај који се карактерише абнормално великим садржајем гвожђа у организму и његовим депоновањем у многим ткивима и органима. |
| Примарне кардиомиопатије (примарне болести срчаног мишића) су хетерогена група болести миокарда непознате етиологије. Представљају оштећење и функционалну измењеност у одсуству коронарне болести, хипертензије и васкуларних мана. Деле се на дилатационе, хипертрофичне и рестриктивне. |
 |
Лумбоишијалгија, познатија у општој популацији под термином ишијас, јак је бол у пределу доњег дела леђа и седалне регије који се шири низ ногу, некада сасвим до стопала. |
 |
Дисфагија је сама по себи симптом који се карактерише као поремећај гутања у смислу отежаног гутања који пацијенти описују као осећај немогућности да залогај покрену наниже, или осећај да храна застајкује у грлу. |
 |
Дијабетесна ентеропатија се јавља код нешто млађих особа, више код мушкараца, него код женског пола и то код инсулин независног дијабетеса. |
 |
Стопе алкохолне болести јетре су алармантно повећане у последњих неколико година. Смртни исход код терминалног стадијума ове болести који се карактерише цирозом јетре и попуштањем функција јетре, веома је велики, а битно је напоменути и то да је у Србији програм трансплантације јетре и уопште, завештања органа међу најнижим нивоима у Европским земљама. |
 |
У панчевачкој болници прошле недеље заједно са колегама са Ургентног центра Клиничког центра Србије, урађене две иновативне операције које нису до сада рађене у нашој болници. Обављена је лапараскопска операција киле и слепог црева. Оваква хирушка интервенција је лакша за пацијента због минималног реза и бржег опорава. |
| У Општој болници Панчево скоро су попуњени капацитети на ковид oдељењу . Због повећаног броја хоспитализованих, поново је трећи спрат Интерног оспособљен за лечење ковид пацијента. |
 |
Корона нас је научила шта значи капљична инфекција, како је дисати испод хируршке маске и зашто се не смемо руковати у време када пандемија достиже пик. Директор Опште болнице у Панчеву, доктор Слободан Овука апелује да се вакцинишемо сви целокупно да би вакцина имала ефекат какав би требало да има. |
 |
Први и по многима најдужи месец у години напокон је завршен. Од свих биланса који ће на крају јануара моћи да се сведу, овај је дефинитивно најлепши: на гинеколошко-акушерском одељењу Опште болнице у Панчеву рођено је 126 беба. |
| Светска здравствена организација и Међународно удружење за борбу против рака већ традиционално обележавају Светски дан бобре против рака сваког 4. фебруара, са циљем појачавања значаја личног учешћа појединца у борби против рака, а за сврху обележавања Светског дана борбе против рака. |
 |
У Специјалистичком центру Опште болнице Панчево Уролошка амбуланта ради сваког дана и прима пацијенте. Све операције на Уролошком одељењу Опште болнице Панчево раде се без одлагања, нема чекања. |
 |
Грип и прехлада су вирусне болести дисајних путева. Спадају у капљичне инфекције. Иако симптоми могу бити слични, грип не треба олако схватити – то је озбиљна болест која може изазвати компликације. |
 |
Бол у грлу најчешће могу да проузрокују вируси или бактерије. Има их много крајем јесени и током зиме, а преносе се прљавим рукама, али и директним контактом, на пример пољупцем. Честа је код деце и младих људи, али се може појавити у било ком животном добу. |
 |
Процењује се да најмање 80 - 100% девојака у доби између 18 - 25 година долази при полном контакту у додир с овим вирусом, док свега око 30% девојака развија симптоме инфекције. |
| Бол не треба трпети, већ је неопходно наћи узрок и лечити га, истиче докторка Биљана Гавриловић специјалиста за терапију бола у Општој болници. Због тренутне ситуације са ковидом 19 амбуланта ради смањеним капацитетом. |
| У Србији се 31. јануара обележава Национални дан без дуванског дима. Активностима у оквиру обележавања Националног дана без дуванског дима упозоравају јавност на штетне ефекте употребе дувана, као и последице излагања дуванском диму. |
| У панчевачкој Општој болници током викенда био је повећан број пацијената којима је била неопходна хоспитализација. Повећао се број особа са ковидом 19 који су на болничком лечењу, а током викенда доста посла било је за ортопеде због падова и саобраћајних траума. |
| На Одељењу ОРЛ Опште болнице само за месец дана урађено је сто операција, које нису спадале у хитне. Помоћ у амбуланти тражили су пацијенти због крварења из носа и вртоглавица. |
 |
Анкилоглосија је урођена аномалија језика у којој је френулум (ресица испод језика која спаја језик са подом усне дупље) кратак, или нееластичан, при чему је смањена покретљивост језика, што може утичати на отежано храњење одојчади и деце и успорен раст и развој, поремећену хигијену усне дупље, поремећен говор и отежану социјализацију код деце са психичким променама. |
 |
Анафилактички шок представља најбурнију и најопаснију алергијску манифестацију, понекад са фаталним исходом. Такав пацијент има уртикарију, ангиоедем, ларингоспазам, поремећај свести, поремећај срчаног рада, хиперперисталтику, итд. Време које протекне од контакта са алергеном па до појаве анафилаксе, говори о тежини клиничке слике. Што је краће, то је болест тежег тока. |
 |
Саобраћајни трауматизам са својим последицама, односно високом стопом смртности, повређивања и инвалидитетом, представља оптерећење целог друштва, а не само система здравствене заштите. Према подацима Светске здравствене организације (СЗО), данас у свету у саобраћајним незгодама смртно страда 1.300.000 људи годишње, а више од половине страдалих особа су пешаци, бициклисти и мотоциклисти. Када је реч о безбедности деце у саобраћају, у 2020. години у Србији je у саобраћајним незгодама погинуло је 13 деце (двоје у својству бициклисте, четворо деце у својству пешака и седморо деце у својству путника у аутомобилу). |
 |
Одређени број пацијената који имају проблема са недовољним, или прекомерним спавањем могу имати поремећај временског усклађивања спавања који може настати због спољашњих уитицаја, или због поремећаја делова мозга задужених за ритам спавања. |
 |
Са годинама многе особе примете да им се тресу руке, глава, или да почиње да им дрхти глас. У већини случајева, реч је о есенцијалном тремору (тремор значи дрхтање, треперење). |
 |
Ларингокела представља врећасту избочину Моржагнијевог вентрикулуса гркљана. Моржагнијев вентрикулус је анатомско место гркљана које се налази између гласних жица. Ово проширење је обложено цилиндричним, трепљастим епителом и испуњено је ваздухом. |
 |
Хидроцела представља водену килу, односно колекцију течности унутар скротума (мошница) која прати processus vaginalis, односно избочење трбушне марамице унутар скротума. |
 |
Један од главних симптома било које болести или тегобе готово увек је – бол. Било да се само ударите или посечете или имате неку пролазну тегобу или пак озбиљнију болест, управо бол је један од аларма који ће вас упозорити да с вашим организмом нешто није у реду и да треба реаговати и заштитити га. |
 |
Имајући у виду актуелну епидемиолошку ситуацију у Републици Србији и земљама европског региона, као и карактеристике делта и омикрон варијанте вируса SARS-CoV-2, Институт за јавно здравље Србије „Др Милан Јовановић Батут“ усвојио је измене мера које се односе на скраћење трајања карантина у кућним условима за блиске контакте COVID-19 позитивних особа са 14 на 10 дана, као и измене критеријума за изузећe од мера карантина након блиског контакта. |
 |
Европска недеља превенције рака грлића материце се обележава од 17. јануара до 23. јануара 2022. године у циљу подизања свести жена о раку грлића материце и начинима превенције. Прва Европска недеља обележена је 2007. године после интервенције Интересне групе за рак грлића материце, када је Савет Европе донео препоруке о започињању Кампање и обележевању Европске недеље превенције рака грлића материце. |
 |
И у време короне пацијенти који чекају на операцију катаркте на Очном одељењу Опште болнице Панчево са свим неопходним припремама, интервенцију обаве највише три месеца. |
 |
Број оболелих од ковида-19 у Србији приближио се бројци од 14 хиљада потврђених случајева, на срећу са лакшом клиничком сликом. У Општој болници бележимо благи пораст пацијента који су интезивној нези. |
 |
Данас обележавамо Нову годину према Јулијанском календару, то је традиција коју са својих предака преносимо на наша будућа поколења. |
 |
Рођење Богочовека Исуса Христоса довело је до преображаја људског света и дало смисао овоземаљском животу. Христово учење води нас на пут Спасења, дајући нашем рођењу пуну садржину. Празник рођења Богомладенца нас подсећа на његов скроман живот, од рођења у Витлемејској пећини до пута Страдања, који је постао путоказ развоја рода људског у претходна два миленијума. |
| Атријална фибрилација (АФ) је међу главним факторима ризика настанка исхемијског можданог удара (ИМУ). Преваленца јој прогресивно расте с годинама. Атријална фибрилација је најчешћи тип срчане аритмије у чијој је основи неправилан кружни ток електричних феномена у преткоморама који провоцира неједнаку, нехомогену преткоморску деполаризацију. Последица је електромеханичка дисфункција срца која доводи до сметњи у опскрбљивању крвљу различитих органа. Мозак као орган са највишим потребама за кисеоником је највише угрожен. Поремећен проток крви води у већи ризик од тромбоемболија. |
| Аутизам је сложени развојни поремећај који се обично јавља током прве 3 године живота. Многи стручњаци верују да овај проблем није изазван једним узроком. Постоје озбиљни показатељи да аутизам настаје као последица различитих фактора који утичу на развој мозга, његову структуру и функционисање. |
 |
У дворани Аполо Дома омладине одржан је квиз “Мислилац” који је поред такмичарског имао и хуманитарни карактер. Учесници су донирали поклоне, које су малишанима поделили Деда Мраз и вилењаци. Најупешнији учесници квиза су се и засладили. |
 |
Прва беба рођена у Панчеву у 2022. години је девојчица Уна, рођена 1. јануара у 21 сат и 15 минута. Уз традиционални поклон Града Панчева – златник, који је уручен мајци Ани Митровић из Алибунара, Уна ће добити и 20.000 динара. |
 |
Општа болница Панчево наставља са занављањем старе медицинске опреме. Апарат за анестезију је уз тим стручњака, неопходна ставка како би се пацијенти осећали безбедно и при најкомплекснијим хируршким интервенцијама. |
 |
Одбројавање последњих сати пандемијске 2021. је у току. Желећи да је што пре одложимо у претинац сећања, можемо бити поносни на успешно положен испит из знања, хуманости и пожртвовања у очувању људских живота. |
 |
Деца која остају у болници за предстојеће празнике пролазе кроз тешке тренутке. Болест им одузима топлину породичног дома којој се сви окрећемо у овим празницима. Али зато се сваке године јаве они који својом пажњом донесу барем мало радости и измаме дечије осмехе. |
 |
Гасна гангрена је тешко инфективно обољење које изазивају различити типови клостридија. |
 |
 |
Лофлеров синдром плућа је ретко обољење које се испољава као алергијска реакција плућног ткива. |
 |
Амброзија је једногодишња коровска биљка висине од 1 до 1.5 метар. У Европи, коју осваја невероватном брзином, може се наћи око 20 врста амброзије, а најраспрострањенија је кратка амброзија (Ambrosia artemisiifolia, Ambrosia elatior). |
 |
Унос витамна Д мора бити стриктно прилагођен потребама, било да је реч о нормалном или патолошком стању. Познато је да вишемесечни унос преко оптимума код здравих особа доводи до интоксикације, тј. до хиперкалцијемије са калцинозом крвних судова и ектопичним калцификацијама меких ткива. |
 |
Алергија на хладноћу спада у најчешће алергије. Изазвана је деловањем хладних предмета, воде или ветра. Типична је појава на местима која су највише изложена хладноћи - лице, руке, ноге. |
 |
Копривњача (уртикарија) је алергијско обољење коже. Иако је релативно честа појава, мало се зна шта је узрок њеног настанка. Кожа је отечена, црвена, рељефаста, а каректерише је свраб или пецкање. Акутна копривњача траје неколико недеља, промене се јављају и нестају за неколико сати, без икаквог трага. У исто време излазе нове. |
 |
Идиопатски лобуларни паникулитис подразумева лобуларне паникулитисе (запаљење поткожног масног ткива) непознате етиологије. |
 |
Бурзитиси су запаљења бурзи. Бурзе су затворене кесе обложене мембраном која је слична зглобној синовији. Омогућавају лакше клизање тетива изнад коштаних избочина. Бурзитиси се јављају у оквиру реуматских болести, после трауме, због инфекције бурзи или из непознатог разлога. |
 |
Акутни артритиси су запаљења (болни отоци) зглобова који настају нагло и трају неколико дана до неколико недеља. Запаљење је интензивно, интензивније него у групи хроничних артритиса где се развија постепено. |
 |
Глобална криза са појавом обољења КОВИД-19 продубљује већ постојеће неједнакости, разоткривајући обим искључености и наглашавајући да је рад на инклузији особа са инвалидитетом императив. Особе са инвалидитетом — милијарда људи — једна су од најискљученијих група у нашем друштву и међу најтеже погођенима у овој кризи у смислу смртних случајева.Инклузија особа са инвалидитетом је суштински услов за очување људских права, одрживог развоја, мира и безбедности. |
| Очување плодности се дефинише као коришћење хируршких, медицинских или лабораторијских процедура са циљем очувања потенцијала биолошког родитељства код одраслих или деце која су под повећаним ризиком од стерилитета пре природног краја репродуктивног периода. |
| Инсулинска резистенција је смањена способност инсулина да у уобичајеним концентрацијама омогући периферно искоришћавање глукозе, супримира продукцију глукозе у јетри и инхибише излучивање липопротеина врло мале густине. Инсулинска резистенција је један од водећих фактора ризика за развој дијабетеса мелитуса типа 2, гестацијског дијабетеса (дијабетес у трудноћи) и предијабетеса (стање код кога је ниво шећера у крви висок али не довољно да би се сматрао дијабетесом). |
 |
Прикупљање крви у просторијама Црвеног крста Панчево доприносе да залихе крви за сада буду стабилне у Општој болници Панчево. |
 |
Дан Христовог рођења подсећа нас да током овоземаљског живота тражимо Христа у себи, као и себе у Христу. Живот нам враћа само оно што дајемо другима. Љубав и праштање ближњем свом није омеђено календаром , који је људска творевина. |
Општа болница наставља са континуираним занављањем медицинске опремe

 |
Здравствени радници чине мање од једног промила светске популације, а скоро читав терет борбе против овог опасног вируса пао је на њихова леђа. У знак захвалности на сву пожртвованост у лечењу коју здравствени радници подносе свакога дана, ова компанија одлучила је да поклони 200 пакетића нашим херојима у првим редовима. |
 |
Општа болница Панчево је уз помоћ спонзора набавила нову количину маски са небулајзерима који служе да пацијенти који су на кисеонику могу и да се инхалирају, као и овлаживаче за кисеоник. Континуирано се набавља све што је потребно да би се нашим пацијентима обезбедила најбоља здравствена заштита. |
 |
Током KОВИД пандемије, људи се све више упознају са улогом и значајем витамина у циљу подизања имунитета, а витамини о којима се посебно прича јесу хидросолубилни витамини – комплекс витамина Б и витамин Ц. Развојем веганске исхране, о витамину Б12 се доста говори јер су природни извори животињске намирнице, а исхрана сиромашна витамином Б-12 утиче на здравље целог организма, а посебно централног нервног система. |
 |
Имати епилепсију или бити родитељ детета са епилепсијом подразумева бројне изазове – од едукације себе али и људи у окружењу, до бриге о учесталости и интензитету самих напада, преко питања везана за лечење и ограничења у свакодневном животу до константне неизвесности везане за наставак квалитетног живота. |
 |
Пети пут за мање од две године, Одељење за ухо, грло и нос Опште болнице Панчево, било је у ковид систему и излазило из њега, због проширења капацитета за пацијенте који су захтевали болничко лечење у ковид систему. Почетком ове недеље после три месеца, пацијенти су поново на болничком лечењу на овом одељењу. |
 |
Покрајинска влада уложила је 744 милиона динара за опремање и реконструкцију 8.000 квадрата Опште болнице Панчево, најважније здравствене установе у Јужном Банату. Од јуна 2016. године за набавку опреме издвојено више од 200 милиона динара, а у реконструкцију Интернистичког блока Опште болнице Панчево уложено је 544 милиона динара. Урађено је оно што се у Јужном Банату чекало више од 30 година. Радило се плански и систематски, како би пацијенти имали најсавременије услове за лечење. Чак и кроз период најјачег удара вируса Ковид-19, Општа болница Панчево пролазила је као победник, захваљујући ангажовању запослених, које су грађани са правом назвали “тихи хероји”. |
| Чуло укуса и мириса припадају хемијским чулима, јер на њих делују хемјске супстанце растворљиве у води, а које су присутне у харни, води и ваздуху. Укус хране или пића је осећај који прдставља комбинацију мириса и укуса. Због тога се и укус хране и пића мења уколико је неком од ова два чула поремећено. |
| За живот и стварање сваке ћелије у организму неопходна је енергија. Ова енергија се у организму добија из хранљивих супстанци тј. оксидацијом угљених хидрата, масти и протеина, које се храном уносе у организам или се у организму налазе као резерве. |
| У саопштењу УН истиче се да ,,наше заједничке глобалне циљеве можемо постићи само ако будемо у стању да створимо једнаке могућности за све, отклонимо неуспехе које је створио и искористио Ковид-19 и применимо стандарде људских права за борбу против укорењених, системских и међугенерацијских неједнакости, искључења и дискриминације". |
| Због рада у ковид систему болнице, на Дечијем интерном одељењу број деце која леже у болници сведен је на минимум. Само малишани који су угрожени леже у болници, остали се лече у амбуланти ове установе. Тренутно су актуелне цревне инфекције. |
 |
„USAID" и Ротари клуб донирали су Дечјем одељењу Опште болнице Панчево два ЕКГ уређаја. Са циљем да се побољша здравствена нега и развој најмлађих пацијената, Ротари клуб Панчево је раније овој установи донирао два инкубатора, сто за реанимацију и УВ лампе. |
 |
У Јужном Банату тренутно 1800 активних случајева оболелих од корона вируса, почетком месеца било је око 4500. Лекари сматрају да је пад оболелих допринела повећана вакцинација становништва у Панчеву. |
 |
Број оболелих од корона вируса се полако смањује, али и даље је преко деведесет пацијената на болничком лечењу. |
| Почев од усвајања Универзалне декларације о људским правима 1948. год. УН су настојале да заштите права и обезбеде интеграцију у све сфере друштвеног живота лицима са инвалидитетом. На основу тих аспирација од 1992. године установљено је да се 3. децембра сваке године обележи Међународни дан особа са инвалидитетом. |
 |
Први децембар је дан када се свуда у свету обележава Светски дан борбе против сиде, а који је први пут обележен 1988. године. Тема Светског дана борбе против сиде 2021.године је „Крај неједнакостима. Крај АИДС-а''. Поред тога што овај датум обележава борбу против једне опаке болести, он је покренуо и један сасвим нови вид подизања свести о битним здравственим темама јер је био први глобално установљен дан здравља.Овај датум постоји да нас подсети да је неопходно разговарати о битним темама и пружити подршку особама које су заражене ХИВ вирусом. |
 |
Устајете три-четири пута током ноћи да бисте мокрили, мислите да сте прехлађени и не осећате се баш најбоље? Јесте ли проверили скоро стање своје простате? Проблеми с мокрењем главни су симптом свих болести простате било да се ради о упали, бенигном увећању или карциному. Упркос напретку медицине, број мушкараца који имају неко обољење простате с годинама се не смањује, а посебно забрињава то што је и оболелих од карцинома простате све више. |
 |
Под појмом Белове парализе се подразумева унилатерална периферна парализа фацијалног нерва непознатог узрока и без оштећења других кранијалних живаца. |
 |
Једна од најчешћих аритмија са којима се лекари сусрећу како у ординацијама опште праксе, тако и у амбулантама Интерне медицине јесте фибрилација преткомора. Други назив за ову честу аритмију је апсолутна аритмија комора. |
 |
Тинитус је перцепција звука у одсуству звучног надражаја, тј.људи се жале на разне звукове без постојања тог звука у стварности. |
 |
Дисајни путеви су често на појединим местима ужи и на тим, ужим местима настаје турбулентно струјање ваздуха које се манифестује као хркање. Током спавања, мишићи меког непца су опуштени и падају, заједно са ресицом ка задњем зиду ждрела, па настаје још веће сужење, у виду пукотине кроз које пролази ваздух. |
 |
Малигни процес на ендометријуму се јавља у виду полипозне промене која проминира у шупљину материце. |
 |
25.новембар одабран је као дан сећања на брутално убиство сестара Мирабал, политичких активисткиња, које се догодило 1960.године у Доминиканској Републици. Генерална скупштина Уједињених нација је 1999.године прогласила 25.новембар за Међународни данборбе против насиља над женама, како би се подигла свест о чињеници да су жене широм света жртве сексуалног, психичког, породичног насиља, злостављања и многих других видова насиља. |
 |
Светски дан детета или Међународни дан детета је годишњи међународни догађај који се обележава и слави 20. новембра. Установљен је од стране Генералне скупштине Уједињених нација 1954. године са циљем да се у свим државама слави и обележава истог дана. |
 |
Трудноћа траје 280 дана, 40 недеља, односно 10 лунарних месеци рачунајући од првог дана последње менструације. Сваки порођај, независно о порођајној маси плода, пре навршених 37 недеља, јесте превремени. |
 |
У новембру је удружење "На пола пута", које чине особе са интелектуалним тешкоћама донирало породилишту Панчево 70 тетра пелена које су они сами сашили уз подршку асистената. |
| Хронични бронхитис и емфизем плућа су удржени у синдром који се назива хронична опструктивна болест плућа (ХОБП). Ову болест карактерише трајан поремећај протока ваздуха кроз дисајне путеве и има прогресиван карактер. |
 |
Алкохол је популарна социјална психоактивна супстанца која се веома често злоупотребљава. То што је његова употреба раширена, не значи да је нешкодљив. Алкохол се налази у различитим алкохолним пићима, а нека од тих пића садрже мање, а нека више алкохола. Свака употреба алкохола од стране малолетне особе се сматра злоупотребом. Алкохол утиче на психу и мења начин на који људи мисле,осећају, говоре. |
| У својој вечитој тежњи да доживе задовољство, млади понекад посежу за дрогама. Животна истина лежи у томе да што више обезбедимо среће и задовољства без вештачких стимуланаса “хемијских штака“, утолико је наш живот испуњенији, садржајнији, богатији. Током развоја важно је да се ускладимо са реалношћу и нормама ужег и ширег окружења. Савлађујући бројне препреке на путу задовољења потреба човек се психолошки развија. |
| Месец новембар је према Међународном и Националном календару здравља посвећен борби против болести зависности, са циљем подизања свести становништва о штетним ефектима дрога и мобилисања целокупног друштва за укључивање у активности на сузбијању њиховог коришћења. |
 |
Светски дан борбе против дијабетеса (WDD) се обележава сваке године 14. новембра, на рођендан сер Фредерика Бентинга, који је 1922. заједно са Чарлсом Бестом открио инсулин. Представља највећу светску кампању усмерену на подизање свести о дијабетесу. |
| Херпес симплекс је често инфективно обољење које спада у везикуларне дерматозе са муко-кутаном локализацијом. Болест протиче кроз три фазе: примоинфекција, латенција и мултипли рецидиви. Преноси се директним контактом са лезија које су на кожи и слузокожама, као и секретом у зависности од локализације. Деца се често заразе са из контакта са зараженом одраслом особом. |
| Младежи на кожи захтевају редован самопреглед као и редовно праћење од стране дерматолога због пораста броја меланома. Дерматолог упућује пацијента на који начин се прате младежи применом АБЦДЕ правила као и на шта је потребно обратити пажњу приликом самопрегледа младежа. |
 |
Деменција се дефинише као стечени и перзистентни поремећај интелектуалних функција при којој долази до оштећења најмање три интелектуалних функција (проблеми са памћењем, проблеми са говором и језичким изражавањем, сналажењем у простору, измена понашања, немогућност рачунања, просуђивања, планирања ...). |
| Трограни или тригеминални живац (лат.nervus trigeminus) је мешовити кранијални нерв, који инервише мастикаторну мускулатуру и из ње изведене мишиће (предњи трбух двотрбушног, милохиоидни, мишић затезач меког непца и мишић затезач бубне опне), док његов сензитивни део оживчава кожу лица и предњег дела главе, слузокожу носне дупље, усне дупље и предње 2/3 језика, зубе, вежњачу, поједине опне очне јабучице и извесне делове тврде мождане опне. Овим гранама се прикључују симпатичка и парасимпатичка нервна влакна која потичу из фацијалног и језично-ждрелног живца, а која инервишу различите органе. |
 |
Због актуелне епидемиолошке ситуације смањен је одзив добровољних даваоца, па су смањене и резерве крви свих крвних група. Црвени крст Панчево и Завод за трансфузију крви Војводине позивају даваоце свих крвних група који су здрави, да се одазову и дају крв, што је од великог значаја у овом тренутку. |
 |
Карцином (рак) бубрега представља око 3% свих малигнитета одраслих особа, а око 95% свих тумора који погађају бубрег. Ову болест карактерише недостатак раних знакова упозорења, различити клинички токови и отпорност на зрачење и хемиотерапију. |
 |
Карцином јајника може да настане као примарни тумор, али и као тумор са других локација у телу. Примарни тумори јајника су епителни тумори (карциноми), тумор порекла герминативних ћелија, а метастазе нису тако ретке у могу да потичу oд материце, дојке, дебелог црева и желуца. |
 |
Малигни тумори вагине могу да настану као примарни, или као метастазе са других органа. Ово је веома важно, јер преко 80% карцинома вагина настаје управо ширењем са других органа и ткива. |
 |
Тимом представља најчешћи тумор који се налази у предњем делу медијастинума (средогруђе). Тимус представља лимфоидни орган који се налази у предњем медијастинуму. |
 |
Овај карцином је најчешћи малигни тумор слузнице уста. Макроскопски се разликују вегетантна и улцерозна форма. Вегетантни или егзофитични облик расте изнад нивоа површине околне слузнице. |
 |
Као и код свих малигних тумора узрок није тачно познат, чешћи је код старијих мушкараца уз хроничну иритацију, пушење и конзумирање алкохолних пића. |
 |
Етиолошки се повезује с недостатком хигијене, фимозом и задржавањем смегме унутар препуцијума, као и пристуством Хуманих папилома вируса. Обрезивањем се готово потпуно заштићује од овог обољења пениса. |
 |
Није познат узок болести. Уочено је, међутим, да се у 10% оболелих налази крипторхизам (неспуштен тестис). Уочено је да 20-30% болесника с тим малигномом има олигоспермију или азоспермију (смањен број сперматозоида у семеној течности) и пре спроведене онколошке терапије. |
 |
Јетра је орган величине лопте за рагби који се налази у горњем десном углу трбуха, испод дијафрагме. Рак јетре настаје у ћелијама јетре. |
 |
Амелобластом представља тумор одонтогеног порекла (развија се из ткива зубних ламина). Иако није у питању тумор малигног порекла са тенденцијом ширања путем крви и лимнфих судова, постоји његова велика агресивност и деструктивни потенцијал. |
 |
Акутна мијелоидна леукемија представља малигну болест коштане сржи у којој су прекурсори нормалних крвних ћелија у раним стадијумима умножени и ометају нормалне функције коштане сржи. Дакле, у питању је малигна болест у којој долази до умножавање бласта. |
 |
Акутна лимфобластна леукемија представља рак коштане сржи при коме се примордијалне ћелије из којих се развијају крвне ћелије умножавају и заузимају место нормалних ћелија. Дакле, малигне ћелије у овом типу леукемије су лимфобласти који се умножавају. Најчешће се ове ћелије умножавају унутар коштане сржи и на тај начин изазивају анемију, тромбоцитопенију и неутропенију, али се могу умножавати и унутар јетре, слезине и лимфних чворова. |
 |
Аденоми представљају бенигне туморе порекла жлезданог ткива. Постоји више подтипова ових тумора који се развијају у средњем уху, попут церуминозних аденома, церуминома и мономорфних аденома. Потичу из специфичних ћелија слузокоже средњег уха које показују ненормалан раст. |
 |
Себацеалне жлезде представљају лојне жлезде које се смештене у кожи. Оне се налазе свуда на телу, осим на длановима и табанима, а највише их има на скалпу и на лицу. Себацеалне жлезде се најчешће налазе у склопу са фоликулима длаке, чинећи себацеофоликуларни апарат. Тумори себацеалних жлезда могу да буду себацеални аденоми (бенигни тумори жлезданог ткива), себацеални епителиоми, карциноми... |
 |
Надбубрежне жлезде (адреналне жлезде) су парне жлезде које се налазе смештене изнад бубрега. Свака надбубрежна жлезда има своју кору и срж које су различите у структури и функцији. Кора надбубрежне жлезде производи хормоне кортиозол, алдостерон и андрогене, а срж надбубрежне жлезде производи хормоне адреналин и норадреналин. |
 |
Захваљући средствима која су обезбеђена из Покрајинског скератаријата за здравство, ускоро ће бити замењена цев за скенер у Општој болници . Такође је обезбеђено и 8 милиона динара за набавку опреме за патологију која ће у многоме олакшати рад и дијагностику на овом одељењу. |
 |
Псоријаза је хронична дерматоза са преваленцијом од 1-3% у општој популацији. Обољење се карактерише периодима ремисије и егзарцербације, чији су настанак и трајање непредвидиви. |
 |
Крипторхизам представља несилажење тестиса и њихово заостајање, једнострано или обострано, на путу од абдомена до скроталних врећа. |
 |
Гинекомастија је једнострано или обострано повећање дојки мушкарца, обично се јавља током неонаталног периода и присутна је код око 70% дечака у пубертету. Регресија настаје за 1 - 2 године. |
 |
Семеници (тестиси) су честа локализација мумпс инфекције. Јавља се код младића у пубертету или одраслих од 3 - 10 дана од почетка болести. |
 |
Материца је највећи полни орган и надовезује се на вагину, а на њу се надовезују јајоводи. Нормалан положај материце је у малој карлици, величине је крушке, како је описују бројни аутори (код жена у периоду трудноће, долази до њеног увећања) |
 |
Аменореја представља изостанак менструације код жена током репродуктивног периода. Аменореја може да буде физиолошка појава која се јавља пре пубертета и патолошка која се јавља када су менструална крварења већ почела. |
 |
Ендометријум представља унутрашњи слој материце (утеруса), а ендометритис представља појаву запаљења овог слоја материце. Дакле, у питању је запаљење слузокоже материце. Често се овај запаљенски процес може проширити и на миометријум (средњи, мишићни слој материце), као и на параматријум (спољашњи слој материце). |
 |
Аднексе представљају јајнике са јајоводима. Због тога што се налазе веома близу, а приликом запаљенских процеса долази до захватања оба поменута органа, често их је веома тешко одвојити. |
 |
Вредности нормалног крвног притиска су - систолни (горњи) од 100 до 140 мм Хг, дијастолни (доњи) од 60 до 90 мм Хг. Међутим, те вредности требало би узети само оквирно, јер како човек стари, тако се и граница систолног (горњег) притиска повећава. |
 |
Иницијативом Слободана Рангелов и организацији у групи Панцевци на Малти, у договору са ПР болнице др Слађаном Ковачевић, 22 оксиметара су донирана Општој болници Панчево. Прикупили су 20 000 дин. Захваљујемо се на овом дивном гесту и апаратима који су нам неопходни у свакодневном раду. Ниједна донација није мала када је од срца! |
 |
Светски дан борбе против остеопорозе који се обележава 20. октобра сваке године је кампања посвећена подизању свести о превенцији, дијагностици и лечењу остеопорозе и сродних мишићно-коштаних обољења. Циљ је ствити здравље костију и превенцију прелома на глобалну здравствену агенду и допрети до здравствених радника, медија, креатора политике, пацијената и шире јавности. Годишња кампања је јединствена прилика када се појединци и организације широм света уједине како би ставили у центар пажње болест. Мото кампање је: ,,Предузмите мере за здравље костију (Take action for bone health)". |
 |
Менопауза представља последње менструално крварење, обично између 45. и 55. године живота и означава крај репродуктивног периода. Значај обележавања овог дана у целом свету је у пружању подршке женама које су у менопаузи и едукацији жена како би се лакше избориле са физичким и емоционалним променама које са собом носи менопауза. |
 |
Број оболелих у Општој болници Панчево против ковида 19 расте, нажалост све млађи пацијенти са тешким клиничким сликама, а већина није вакцинисана, истиче директор панчевачке болнице доктор Слободан Овука. Он је позвао све који сумњају у ову болест да дођу обуку одело и сами питају оболеле да ли су вакцинисани или не и виде колико је тешко пацијнтима на кисеонику и респиратору. |
| Светски дан хране један је од најважнијих датума у Календару јавног здравља. Обележава се већ три деценије, у преко 150 земаља света. За датум његовог обележавања, 16. октобар, симболично је узет дан када је основана Светска организација за храну и пољопривреду (Food and Agriculture Organisation - FAO), сада већ давне 1945. године, непосредно по окончању Другог светског рата, са циљем да подржи, обједини и појача тадашње напоре свих земаља да што брже, и ефикасније превазиђу кризу изазвану разорним последицама рата. |
 |
Оштрина вида је способност ока да у спољњем свету разликује одвојене објекте посматрања. Што су посматрани објекти међусобно ближи, а могу се разликовати и што је видни угао сваког од њих мањи, оштрина вида је боља. |
| Октобар се, као Међународни месец борбе против рака дојке, обележава у многим земљама широм света, како би се скренула пажња на распрострањеност ове болести и подигла свест о значају превенције, раног откривања и правовременог започињања лечења особа оболелих од карцинома дојке. |
 |
Панчево је град међу онима који бележе највећи број новооболелих од ковида-19. Одмах иза Београда, Новог Сада, Ниша и Крагујевца. Најтеже клиничке слике имају невакцинисани пацијенти. |
 |
На Дечијем интерном одељењу панчевачке болнице било је деце којима је због ковида 19 била неопходна хосптализација. |
 |
Светски дан менталног здравља се сваке године обележава 10.октобра од 1992.године на иницијативу Светске федерације за ментално здравље и уз подршку Светске здравствене организације, а у партнерству са министарствима здравља и организацијама цивилног друштва широм света. |
 |
Хемангиоми јетре представљају васкуларне малформације. Представљају 70% бенингних тумора јетре и сматра се да их има 3-20% популације. |
 |
У нашој земљи Национална недеља промоције дојења обележава се 40. недеље у години која симболично представља трајање трудноће, а ове године обележиће се у периоду од 3. до 10. октобра под слоганом: „Дојење је наша заједничка одговорност“. |
 |
Уколико буде за то потребе можемо још да проширимо те капацитете науштрб редовних пацијената, што уопште није добро. Одлика овог таласа је да имамо све више млађих људи радно способног становништва. |
 |
Због повећаног броја оболелих од Kовида-19 који захтевају болничко лечење, поново се на првом спрату Интерног одељења Опште болнице Панчево лече пацијенти оболели од овог вируса. Тренутно је хоспитализовано 140 пацијената. |
 |
Деца често стављају различита страна тела у нос и најчешће су то разне гумице, папир, разне куглице или делови играчака, сунђер, као и „згодна" органска страна тела као што је пасуљ. |
 |
Повреде ува могу да захвате само спољње, средње или унутрашње уво, или су комбиноване тако да обухватају више регија. Повреде усне шкољке најчешће су узроковане дејством оштре или тупе механичке силе, а реде су последица физичких и хемијских фактора. Према степену оштећења, механичке повреде могу бити отворене и затворене. |
 |
У мају 2012. светски лидери су се обавезали да ће смањити глобалну смртност од незаразних болести за 25% до 2025. године. Кардиоваскуларне болести (КВБ) су одговорне за скоро половину свих смртних исхода од хроничних незаразних болести, што их чини главним „убицом“ на свету. |
 |
Светска недеља дојења сваке године се обележава у више од 170 земаља света како би се повећало знање и свест о значају и предностима дојења и обезбедила подршка дојењу. |
 |
Светски дан борбе против беснила биће обележен данас у свету и у Србији са циљем подизања јавне свести и скретања пажње на важност превенције те најстарије и најсмртоносније заразне болести познате човечанству. |
 |
Светски дан контрацепције се обележава сваке године, 26. септембра. почевши од 2007. године. Кампања је покренута на глобалном нивоу, са циљем да се истакне важност употребе различитих метода контрацепције и одговорног сексуалног понашања. |
 |
Акутни респираторни дистрес синдром је нагло попуштање респираторног система. У кратком времену, дисање постаје тешко, и парцијални притисак кисеоника у крви опада. |
 |
Аденоми бронха настају из дукталног епитела мукозних бронхијалних жлезда најчешће великих бронха, где расту као добро ограничена и васкуларизована субмукозна (испод слузокоже) маса. |
 |
Хиперестрогенизам представља прекомерне нивое естрогена (женског полног хормона који луче јајници) у организму. Повећани нивои естрогена се могу јавити код оба пола, али су чешћи код особа женског пола. Уколико се прекомерни нивои естрогена налзе код репродуктивно способних жена, често се стање назива синдром естрогене доминације. |
 |
Анорексија представља поремећај исхране који се карактерише губитком 15% телесне тежине очекиване за пол и узраст, страхом од гојења и емоционалним поремећајима због изгледа тела са којим особе које пате од анорексије готово никада нису задовољне. |
 |
17.септембар Светска здравствена организација и међународни партнери обележавају као Светски дан безбедности пацијената. Општи циљеви Светског дана безбедности пацијента се односе на глобално побољшавање разумевања безбедности пацијента, повећањe ангажмана јавности у безбедности здравствене заштите и промовисању глобалне акције за побољшање безбедности пацијента и смањење штете пацијента. |
| Беснило (Rabies) је смртоносно запаљење мозга (енцефалитис), узрокован вирусом беснила.Болест карактерише психомоторни немир, страх од воде и прогресивна мишићна парализа. Када се болест јави смрт је готово неизбежна, те је од изузетног значаја и огромна одговорност пацијента да се јави лекару и лекара у спровођењу антирабичне заштите после уједа од стране бесне или на беснило сумњиве животиње. |
| Емболија плућа настаје опструкцијом гране плућне артерије крвним угрушком, најчешће 3-7 дана од тромбозе дубоких вена ногу. Презентује се у виду отежаног или убрзаног дисања, убрзаног срчаног рада, несвестице и бола у грудима. |
 |
Повећан је број пацијента који због вртоглавица и крварења из носа буду збринути у Општој болници на ОРЛ одељењу. Начелник, доктор Вељко Божић истиче да то није неуобичајено пошто је један од разлога нагла промене температуре и ваздушног притиска. |
 |
,,Једна пацијенткиња је интубирана, шест је на полуинтензивној нези. Инфективно одељење је пуно, тренутно се пуни старо грудно, а следеће је ОРЛ. Места у издвојеним објектима има за око 100 пацијената“, изјавио је директор болнице др Слободан Овука. |
| Након увођења антихипертензивне терапије, потребне су месечне контроле ради процене њене ефикасности и регистровања нежељених ефеката . Када се постигну циљне вредности крвног притиска, могуће је значајно смањити учесталост контролних прегледа. Међутим, изузетно дуги интервали између контрола се не саветују, јер могу нарушити комплијансу болесника. |
| Приликом прегледа труднице најважније је одредити да ли предстоји порођај. Ако је тако, дете се може родити у року од неколико минута и некада нема времена за транспорт. Порођај у теренским условима је оправдан када се рађање новорођенчета очекује у наредних 5 минута, када је болница недоступна (у ванредним условима) или не постоји могућност правовременог транспорта у болницу. |
 |
Грозница Западног Нила потврђена код две особе које се тренутно лече на Инфективном одељењу Опште болнице. Према подацима Завода за јавно здравље вирус је потврђен код особе из Панчева док је други оболео из Ковачице. |
 |
До рамене дистокије долази када је после рађања главице даље рађање онемогућено, услед заустављања предњег рамена плода у нивоу симфизе. |
 |
Профилактички дати антибиотици умногоме помажу у редуковању инфекција после царског реза. Треба задовољити три критеријума како би се оправдало давање антибиотика. |
 |
Дојка се налази на средњој трећини предњег зида грудног коша, неколико центиметара у страну од медијалне линије. |
 |
Амниоцентеза представља најстарији инвазивни дијагностички поступак који је примењиван у трудноћи. Пуни значај добија тек са развојем биохемије и молекуларне биологије, које омогућују да се из плодове воде добију жељени подаци, али и ултразвучне опреме која служи за непосредно навођење игле, чиме су потенцијалне компликације интервенције сведене готово на минимум. |
 |
Општој болници Панчево испоручено је 40 болничких кревета, које је обезбедило Министарство здравља. Тридесет савремених кревета је испоручено у полуинтезивну, док је десет било намењено за интезивну. |
 |
Вирус хепатитиса Е је вирус величине 27-32нм. Спада у РНК вирусе са липидним омотачем. По својим карактеристикма сличан је норвалк и калици вирусима. Доста је отпоран у спољашњој средини. |
 |
Резервоар инфекције је оболео човек или вирусоноша. ХБВ се налази и крви, крвним продиктима, зноју, пљувачци, урину, фецесу, семеној течности, мајчином млеку, синовијалним течностима и ликвору. |
 |
Вирусни хепатитис А је акутно инфективно и контагиозно обољење које се карактерише израженим диспептичним синдромом и појавом иктеруса (жуто пребојена кожа и слузокожа) насталим услед оштећења паренхима јетре. |
 |
Вирус хепатитиса Ц (ХЦВ) припада РНК вирусима, фамилија „Flaviviridae". Геном чини једнострука РНК а омотач протеини, величине је 35-50 нм. Показује хиперваријабилност регија генома и до сада је описано 12 генотипова. |
 |
Берибери представља недостатак тиамин-пирофосфата у организму (тиамин пирофосфат је активни облик витамина Б1). Витамин Б1 у организму учествује у процесу метаболизма угљених хидрата. Витамин Б1 је хидросолубилан (растворљив у води) и тело може да складишти само око 20мг овог витамина укупно – највише се накупља у скелетним мишићима, а налази се у јетри,срцу, бубрезима и мозгу. |
 |
Пелагра је које је проузроковано недостатком витамина Б3 (ниацина) који је битан за процес у организму који подразумевају НАД и НАДПХ (никотинамид-динукелотид и никотинамид- динуклотид фосфат). У питању је системско обољење које је проузроковано недостатком витамина Б3 (ниацина). |
 |
Скорбут је стање које се карактерише смањеним нивоом витамина Ц у организму. Људски организам не може да синтетише витамин Ц (аскорбинску киеслину), већ се он мора уносити путем хране (преко 90% витамина Ц се уноси из свежег воћа и поврћа, а остатак из меса, рибе, јаја, млека и млечних производа). |
 |
Рахитис представља болест деце и особа код којих кости расту, код којих постоји поремећај у густини костију због недостатка витамина Д и поремећаја метаболизма калцијума. |
 |
Карциноидни тумор представља тумор порекла неуроендокриних ћелија и најчешће се налази у танком цреву. |
| Будно око родитеља је неопходно у сваком тренутку јер мала деца из радозналости стављају разне предмете у уста, ухо и нос. То се не догађа често али није ни реткост. |
 |
Хронична акустичка траума представља повреду средњег уха која је последица хроничног и дуготрајног излагања акустичким дражима. Оваква оштећења слуха запажају се код радника који дуго раде у условима буке: у фабрикама, у дискотекама, на аеродромима или са пнеуматским компресором без адекватних мера заштите од буке. |
| Четврти талас корона вируса у Србији се полако захуктава и у болницама је све више људи. Ковид најчешће погађа невакцинисане особе које се враћају са летовања или су били на већим окупљањима попут свадби или ноћног провода. |
 |
Међународни дан младих обележава се сваке године 12. августа, скрећући пажњу младих на питања младих и славећи потенцијал младих као партнера у данашњем глобалном друштву. |
 |
У Панчеву се бележи раст заражених корона вирусом. Тренутно се на Инфективном одељењу, Опште болнице Панчево, лечи 14 особа од корона вируса од којих се 10 налази на кисеоничној потпори. |
 |
Црвена крвна зрнца (еритроцити) су најбројнија врста ћелија у организму. Њихова основна улога је да транспортују кисеоник од плућа до ткива и угљен-диоксид у обрнутом смеру. |
 |
Акутна упала бубрега је инфекција горњег дела уринарног тракта која најчешће настаје продором бактерија из мокраћне бешике путем мокраћовода у бубрег. Пре свега је погођена цревна област и бубрежна карлица или нешто ређе бубрежне тубуле. |
 |
Високи леукоцити нису увек знак да имате бактеријску инфекцију и да треба да пијете антибиотике, а добри еритроцити не значе да нисте анемични. |
 |
Потребно је да назначимо да се код лекара иде одмах, без чекања, када се код детета појаве фебрилне конвулзије, односно фрас. Дете је без свести, обично укоченог (фиксираног) погледа, згрчено је или се наизменично тресе и опушта (конвулзије), а неретко се може видети и пена на устима. |
 |
Сваке године на одељењу Ухо, грло, нос, Опште болнице Панчево, буде откривено око 50 пацијената са дијагнозом карцинома. Начелник овог одељења, доктор Вељко Божић, истиче да су сви пацијенти са овом дијагнозом пушачи. |
 |
Сужење препуцијума (фимоза) може да ремети елиминацију урина тако да се од урина заосталог приликом мокрења препуцијум надувава. Крајња компликација фимозе као опструктивног фактора може бити чак и хидронефроза. |
 |
Светска недеља дојења обележава се у више од 170 земаља како би се повећало знање и свест о значају и предности дојења.Званични датум Светске недеља дојења је од 1. до 7. августа али се државама, организацијама и институцијама предлаже да за обележавање и активности поводом Светске недеље дојења изаберу најприкладније у њиховим земљама. |
 |
Гастроентеритис представља запаљење желуца и црева које је праћено повраћањем, воденастим проливима и грчевима у стомаку, мучнином са или без повишене температуре, главобољом, хладним знојем, боловима у мишићима, губитком апетита и губитком тежине. |
 |
На избор намирница које користимо у исхрани утиче више различитих чинилаца, као што су пол, узраст, физичка (не)активност, здравствено стање. Зависно од годишњег доба, доступне су нам и различите врсте намирница, а осим тога, климатски услови утичу и на потребе организма за одређеним врстама хране. |
 |
Сезона годишњих одмора повећава број учесника у саобраћају и могућност већег броја саобраћајних незгода. Статистике показују да се највећи број саобраћајних незгода дешава лети и то најчешће у јулу, августу и септембру. |
 |
Четири од пет одраслих особа бар једном у животу има проблема са болом у доњем делу леђа. Бол у доњем делу леђа није специфична болест, него симптом који може бити узрокован разним акутним и хроничним процесима у леђима, а може бити и рефлекс процеса у трбушној шупљини и малој карлици када се бол из споменутих подручја рефлектује у доњи део леђа. |
 |
Од 2010. године Светска здравствена организација (СЗО) је установила 28. јул као дан обележавања борбе против хепатитиса. Овај дан је одабран у част рођендана нобеловца проф. Блумберга, који је открио вирус хепатитис Б. |
 |
Топлотни удар настаје као поремећај метаболичке топлоте (ендогене) и климатске топлоте (егзогене) и способности организма да изврши регулацију истих. Топлотни поремећај најчешће срећемо код беба и мале деце због слабе развијености терморегулационих центара у том периоду, као и неадекватном преграјавању тела одећом и прекривачима. Често се јавља у прегрејаним салама за такмичење, на излетима и слично. |
 |
Дејство топлотног и ултравиолетног зрачења у интензитету већем од дозвољеног називамо опекотине или комбустије. У практичне сврхе значајно је да опекотине које захвате 12 - 15% код одраслог човека, а 5 - 8% код деце, опасне су по живот јер постоји могућност патофизиошких промена у организму (појава шока) што може и летално да се заврши, па је препоручљива хоспитализација. |
 |
Сунчаница је акутно оштећење мозга изазвано сунчевим зрачењем. За време високих температура, често чујемо да нам је неопходна заштита од сунца, а препорука је да не излазимо по сунцу од 12-17ч - али зашто? Какве последице може да остави дуго излагање сунцу? |
 |
Мајчино млеко је због свог састава непобитно најздравије за новорођенче и одојче. Дојење представља наставак природне пренаталне исхране, екстерну везу мајке и плода, имунолошку интеграцију мајке и детета, и остаје једна од кључних активности у гајењу детета и од највећег значаја за јавно здравље, за здравље детета и истовремено за здравље мајке. Са психолошке стране, дојење је почетак стварања сигурног окружења у коме ће дете одрастати. |
 |
Денга је обољење чији је проузроковач вирус денге. Вирус денга је РНА вирус из породице „Flaviviridae". Постоје четири соја овог вируса. Не постоји унакрсни имунитет између сојева, тј. инфекција са једним сојем не ствара имунитет од остала три соја. |
 |
Трудите се да вам животни простор увек буде расхлађен. Препорука је одржавати собну температуру испод 32°C током дана, односно испод 24°C током ноћи. Ово је нарочито важно за децу узраста до 2 године, особе старије од 60 година, као и за хроничне болеснике. |
 |
Стање терминалне бубрежне инсуфицијенцијенције карактерише као немогућност бубрега да излучује азотне материје, токсине, продукте метаболизма, немогућност одржавања ацидобазне равнотеже и хомеостазеорганизма ни уз помоћ доступне конзервативне терапије. |
 |
Недостатак гвожђа је термин који се односи на смањење количине гвожђа у организму. Анемија услед недостатка гвожђа се развија када постоји толико смањење количине гвожђа у организму да је поремећена еритропоеза (процес стварања црвених крвних зрнаца и хемоглобина). |
 |
Плеура, или плућна марамица, обавија плућа чинећи кесу у којој се нормално налази мала количина течности која служи да смањи трење које настаје ширењем и скупљањем плућа током дисања. Ова марамица може да се упали и може да дође до скупљања течности у том простору. Дакле, то је излив течности у плеурални простор. |
 |
Помоћник директора Опште болнице у Панчеву др Слободан Продановић изразио је изузетно задовољство и захвалност поводом донације квалитетне медицинске опреме за Службу педијатрије Опште болнице Панчево. |
 |
Акутни алергијски едем капака је алергијска манифестација која може бити изазвана уједом инсекта, употребом појединих лекова или се може јавити у склопу генерализоване уртикарије. |
 |
Хронични синуситис је запаљење слузокоже синусних шупљина и ово стање постоји, ако тегобе као код акутног синуситиса перзистирају и трају дуже од 8 недеља. |
 |
Опекотине спадају у посебну групу повреда изазваних дејством термичког агенса. Учесталост опекотина, рачунајући целокупну популацију је 1% годишње. Половина од свих опечених задобијају такве повреде да захтевају третман лекара, а 20% од свих хоспитализованих су деца. |
 |
Полицистични бубрези аутозомално доминантног типа - Инциденција ове болести је 1:500 на 1000 становника, у 90% случајева мутиран је ген ПКД1, а у 10% случајева ген ПКД2. Суштина је поремећај базалне мембраме тубулуса, долази до његове дилатације и стварања многобројних циста. Симптома у почетку често нема. |
 |
Након апликације спекулума, најпре уклонити слуз или упални ексудат стерилним брисом или газом. Дебљим брисом из сета ући у ендоцервикални канал, заротирати брис неколико пута (3-5 секунди) како би се покупило довољно ћелија, а затим извући брис без додиривања зидова вагине. Брис се одмах мора уронити у епрувету са транспортном подлогом и енергично размутити у њој. Поломити вишак држача бриса и затворити епрувету. Узети узорак би требало транспортовати до лабораторије одмах након узорковања. Уколико транспорт није могућ, узорак чувати на температури 2-8°С и у року од 24ч доставити лабораторији. |
 |
Примарни тумори мозга се најчешће виђају код деце (прва деценија живота). Код одраслих инциденца расте са годинама живота и за особе са преко 65 година износи 18 на 100 000. |
 |
Ако имате изненадну потребу за мокрењем коју не можете да контролишете, тада се код вас вероватно ради о уринарној ургентној инконтиненцији. За овај поремећај окривљује се лака инфекција мокраћних канала. |
 |
Парализа дијафрагме настаје услед прекида њене моторне инервације неким патолошким процесом. Може да буде обострана или једнострана. |
 |
Алергијске реакције означавају имуни одговор организма на неку материју из спољашње средине, која обично није штетна по здравље човека. |
 |
Запаљења слузнице горњих респираторних путева представљају најчешћи узрок јављања пацијента лекару опште медицине (35-40% свих пацијената). |
 |
На иницијативу Управног већа Уједињених нација од 1989. године Светски дан становништва обележава се 11. јула. |




